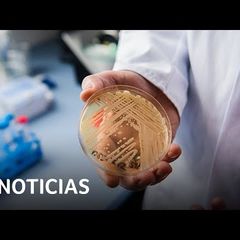
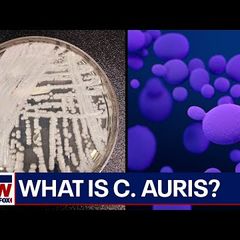

| |
Video News Review at 11 a.m. Daily
Current Video News:
https://www.inoreader.com/stream/user/1006407045/tag/YouTube%20subscriptions/view/html?cs=m&sb=y
Selected Articles Review From The News And Times -
https://thenewsandtimes.blogspot.com/
Current Selected Articles: https://www.inoreader.com/stream/user/1006407045/tag/user-favorites/view/html
All Current Articles: https://www.inoreader.com/stream/user/1006407045/tag/all-articles/view/html |
|
|
|
 | Partygate: 'Hand on heart that I did not lie' - Boris Johnson |
| Former Prime Minister Boris Johnson has claimed that the Privileges committee is "holding back evidence"... |
| |
|
|
|
 | Watch live: Gwyneth Paltrow in court following claims she crashed into skier |
| Actress Gwyneth Paltrow appears in court after being accused of crashing into a skier during a 2016 family... |
| |
|
|
|
 | PMQs: Starmer attempts to prove Labour is ready for government - Analysis |
| Sky's Joe Pike analyses PMQs, saying Sir Keir Starmer was out to prove to doubters that Labour is ready... |
| |
|
|
|
 | Watch live: Baroness Casey quizzed on Met Police review findings |
| Baroness Casey - who conducted a review on the Met Police - is by questioned by the Home Affairs Committee.... |
| |
|
|
|
 | Политическая китаизация России? |
| Будет как в Синьцзяне? В эфире Владимир Милов, Сергей Давидис. НАСТОЯЩИЙ МАТЕРИАЛ (ИНФОРМАЦИЯ) ПРОИЗВЕДЁН,... |
 Радио Свобода Радио Свобода | 1m | |
|
|
|
 | He ended New York City's insane ban on pinball |
| Austin Bragg and Meredith Bragg talk Remy, libertarian parodies, and their new indie film, "Pinball:... |
 ReasonTV ReasonTV | 3m | |
|
|
|
 | CHP shuts down 71 Freeway due to massive potholes |
| All lanes of State Route 71 were closed in both directions at Holt Avenue and Valley Boulevard in Pomona... |
 CBS Los Angeles CBS Los Angeles | 5m | |
|
|
|
 | Striking LAUSD workers continue picketing Wednesday |
| SEIU and UTLA members picketed Wednesday as a scheduled three-day strike continued into its second day,... |
 CBS Los Angeles CBS Los Angeles | 5m | |
|
|
|
 | Pekín escenifica que respalda la paz, pero profundiza sus lazos con Moscú |
| Pekín (China), 22 mar (EFE/EPA).- Con sus propuestas para poner fin a la guerra en Ucrania, China busca... |
 AGENCIA EFE AGENCIA EFE | 7m | |
|
|
|
 | Kremlin critica la reacción "hostil" de Occidente a la visita de Xi |
| Moscú (Rusia), 22 mar (EFE/EPA).- El Kremlin denunció este miércoles la reacción "hostil" de países occidentales... |
 AGENCIA EFE AGENCIA EFE | 7m | |
|
|
|
 | WATCH LIVE: Biden and First Lady Jill Biden mark Women's History Month at White House... |
| Stream your PBS favorites with the PBS app: https://to.pbs.org/2Jb8twG Find more from PBS NewsHour... |
 PBS NewsHour PBS NewsHour | 8m | |
|
|
|
 | WATCH LIVE: Fed Chair Powell gives update after interest rate decision amid banking... |
| Stream your PBS favorites with the PBS app: https://to.pbs.org/2Jb8twG Find more from PBS NewsHour... |
 PBS NewsHour PBS NewsHour | 8m | |
|
|
|
 | WATCH LIVE: White House holds news briefing after Fed announces decision on interest... |
| Stream your PBS favorites with the PBS app: https://to.pbs.org/2Jb8twG Find more from PBS NewsHour... |
 PBS NewsHour PBS NewsHour | 8m | |
|
|
|
 | WATCH LIVE: Yellen testifies on budget in Senate hearing amid questions about banking... |
| Stream your PBS favorites with the PBS app: https://to.pbs.org/2Jb8twG Find more from PBS NewsHour... |
 PBS NewsHour PBS NewsHour | 8m | |
|
|
|
 | 🔴 "Me dijo que la acosaban": habla la madre de la soldado hallada muerta... |
| Alejandra Ruiz, madre de la soldado hispana Ana Basaldua, aseguró que hay contradicciones en las versiones... |
 Univision Noticias Univision Noticias | 8m | |
|
|
|
 | 🔴 EN VIVO: Huelga de trabajadores de escuelas en Los Ángeles. Hablan los sindicatos |
| 🔴 EN VIVO: Hablan los trabajadores de escuelas en Los Ángeles sobre la huelga |
 Univision Noticias Univision Noticias | 8m | |
|
|
|
 | Una hispana halló un recién nacido abandonado días antes en la puerta de su casa |
| Juliannys Avilés regresaba de pasar el fin de semana fuera cuando vio una sillita con un bebé llorando... |
 Univision Noticias Univision Noticias | 8m | |
|
|
|
 | The India Story Live: World Latest English News | International News | Live News |
| The India Story Live: World Latest English News | International News | Live News #TheIndiaStory... |
| |
|
|
|
 | Active COVID-19 cases in India cross the 7,000 mark | What's causing the spike? |... |
| As India continues to witness a rapid surge in COVID-19 cases, the top medical body tasked with making... |
| |
|
|
|
 | India: Metro lines a game changer for Mumbai traffic | WION Dispatch |
| Mumbai, the country's most vehicle-congested city, is witnessing a complete infrastructure revamp, as... |
| |
|
|
|
 | Thick sandstorms shroud Beijing I WION Shorts |
| China's capital city of Beijing was affected by dense sandstorms on March 22. Shrouding buildings &... |
| |
|
|
|
 | Americans acquiring more in car loans than ever before | Morning in America |
| In less than two years, interest rates have almost jumped 2 percent leading to a $30 increase a month... |
 NewsNation Now NewsNation Now | 8m | |
|
|
|
 | Behind The Amazing Growth Of Pickleball |
| Long-time sports executive and former Turner Sports president David Levy joins Forbes senior writer Jabari... |
 Forbes Under 30 Forbes Under 30 | 8m | |
|
|
|
 | Серп и Молот Запрет - Новодворская |
| Путин ворует Украинских детей. Бездействие США провоцирует Путина на расширение конфликта и использование... |
 borovonovodvo borovonovodvo | 9m | |
|
|
|
 | Народ и Сталин - Новодворская |
| Путин ворует Украинских детей. Бездействие США провоцирует Путина на расширение конфликта и использование... |
 borovonovodvo borovonovodvo | 9m | |
|
|
|
 | Designer Jeremy Scott heads to Seoul |
| (22 Mar 2023) Designer Jeremy Scott says he is "very proud" of his legacy at fashion house Moschino during... |
 Associated Press Associated Press | 9m | |
|
|
|
 | TikTok creators speak to press ahead of CEO congressional hearing | LIVE |
| TikTok creators hold a news conference ahead of Thursday's congressional hearing with TikTok's CEO Shou... |
 Associated Press Associated Press | 9m | |
|
|
|
 | Missile Strikes Civilian Building in Ukraine |
| (22 Mar 2023) Ukraine's president posted video missile slamming into an apartment building in the southeastern... |
 Associated Press Associated Press | 9m | |
|
|
|
 | Secretary Blinken testifies before the Senate Committee on Foreign Relations - 2:30... |
| Secretary of State Antony J . Blinken testifies before the Senate Committee on Foreign Relations on the... |
 U.S. Department of State U.S. Department of State | 9m | |
|
|
|
 | TikTok CEO to promise firewall protection for Americans user data |
| The Chinese-owned company is expected to clarify its community guidelines and add new polices on AI and... |
| |
|
|
|
 | Flooding rains, fierce winds and more snow pound West Coast l GMA |
| ABC News' Rob Marciano reports on a new storm bringing heavy rain, snow and destructive winds in the... |
| |
|
|
|
 | Lebanon economic crisis: Banking system replaced with cash economy |
| Lebanon's economic collapse has devastated its banking sector and turned the nation into a cash-based... |
 Al Jazeera English Al Jazeera English | 12m | |
|
|
|
 | China sends ominous message to the West |
| Rep. Mike Turner, R-Ohio, says it would be a 'game-changer' if China supports Russia with weapons for... |
| |
|
|
|
 | Sunak says you can't trust Labour to keep people safe |
| The Prime Minister Rishi Sunak said in PMQs that you cannot trust a Labour government to keep people... |
 The Independent The Independent | 14m | |
|
|
|
 | Massive operation underway after ship tips over in Edinburgh dock during strong winds |
| Injuries have been reported after a ship tipped over in an Edinburgh dock during high winds. The... |
 The Independent The Independent | 14m | |
|
|
|
 | Starmer grills Sunak on low rape prosecution rate at PMQs #shorts |
| Click here to subscribe to The Independent: https://bit.ly/Subscribe-to-Independent About The Independent:... |
 The Independent The Independent | 14m | |
|
|
|
 | 'Cancelled' for retweeting Ricky Gervais trans joke |
| "I was rather miffed that the reason that they cancelled me was I retweeted a Ricky Gervais speech."... |
 Times Radio Times Radio | 14m | |
|
|
|
 | Похищение, военное преступление и промывка мозгов. Депортация украинских детей в... |
| Поддержать канал и выход новых роликов: https://www.patreon.com/macknack Принудительная депортация... |
| |
|
|
|
 | Will banking turmoil impact feds raising interest rates? |
| The Federal Reserve will announce Wednesday whether interest rates are going up again. We hear from CBS... |
 CBS New York CBS New York | 15m | |
|
|
|
 | Armed crooks steal $23k of items in NYC spree: NYPD |
| Two suspects allegedly stole over $23,000 worth of jewelry, cash, and other items in a New York City... |
| |
|
|
|
 | |
| My Opiion: Putin and Xi: more pomp and circumstance than the substance, which can be described in one... |
 Tweets by @mikenov Tweets by @mikenov | 17m | |
|
|
|
 | Trump awaits New York grand jury decision |
| Sources tell CBS News that Trump is meeting with his legal team at Mar-a-Lago as they await a possible... |
| |
|
|
|
 | Sherwood Lumber: When there is some hope on the interest rate cycle, we see a surge... |
| Kyle Little, COO of Sherwood Lumber, discusses the steep fall in lumber prices over the past year, and... |
 CNBC Television CNBC Television | 19m | |
|
|
|
 | Fed doesn't want to be in a position where people are asking about rate cuts, says... |
| WSJ Reporter Nick Timiraos joins CNBC's Brian Sullivan and 'Last Call' to discuss whether the Fed should... |
 CNBC Television CNBC Television | 19m | |
|
|
|
 | LIVE: White House press secretary Karine Jean-Pierre holds a briefing with reporters... |
| White House press secretary Karine Jean-Pierre holds a briefing with reporters on Wednesday. »... |
 CNBC Television CNBC Television | 19m | |
|
|
|
 | Treasury yields hold higher ahead of Fed's interest rate decision |
| CNBC's Rick Santelli reports on the treasury markets. For access to live and exclusive video from CNBC... |
 CNBC Television CNBC Television | 19m | |
|
|
|
 | Fed must stay the course on inflation, says former Kansas City Fed president |
| Thomas Hoenig, former FDIC vice chair and Kansas City Fed president, joins 'Squawk Box' to discuss why... |
 CNBC Television CNBC Television | 19m | |
|
|
|
 | Banking crisis looks much different than 2008, says former Goldman CEO Lloyd Blankfein |
| Lloyd Blankfein, former Goldman Sachs CEO, joins 'Squawk Box' to discuss if the recent banking crisis... |
 CNBC Television CNBC Television | 19m | |
|
|
|
 | Fed chair Powell's statement will be more important than rate decision, says Jim... |
| Jim O'Neill, former Goldman Sachs chief economist and chairman of asset management, joins 'Squawk Box'... |
 CNBC Television CNBC Television | 19m | |
|
|
|
 | Former Boston Fed president: I'm concerned we haven't seen all problems from higher... |
| Eric Rosengren, former Boston Fed president and visiting MIT scholar, joins 'Squawk Box' to discuss what... |
 CNBC Television CNBC Television | 19m | |
|
|
|
 | Humanity has 'broken the water cycle, destroyed ecosystems': UN chief | AFP |
| Humanity has "broken the water cycle, destroyed ecosystems and contaminated groundwater," the UN secretary-general... |
| |
|
|
|
 | Water scarcity activist Mina Guli completes 200th marathon at the UN to raise awareness... |
| Australian water scarcity activist Mina Guli completes her 200th marathon outside the UN headquarters... |
| |
|
|
|
 | UN 2023 Water Conference opens in New York | AFP |
| United Nations Secretary General Antonio Guterres declares the UN 2023 Water Conference open in New York,... |
| |
|
|
|
 | Danone realiza en la planta de Aldaia su primera instalación de placas solares en... |
| Danone ha realizado en la planta que tiene en Aldaia (Valencia) su primera instalación de paneles solares... |
 Europa Press Europa Press | 20m | |
|
|
|
 | El Banco de España eleva más de 4 puntos su previsión de IPC de los alimentos para... |
| El Banco de España ha revisado al alza su previsión de inflación promedio de los alimentos para 2023,... |
 Europa Press Europa Press | 20m | |
|
|
|
 | María Gámez dimite como directora de la Guardia Civil |
| La directora de la Guardia Civil, María Gámez, ha presentado su renuncia esta mañana al ministro del... |
 Europa Press Europa Press | 20m | |
|
|
|
 | Ayuso da la enhorabuena a Vox por "dar a Sánchez una victoria" |
| La presidenta de la Comunidad de Madrid, Isabel Díaz Ayuso, ha dado este miércoles la enhorabuena a Vox... |
 Europa Press Europa Press | 20m | |
|
|
|
 | El Parlament avala el decreto ley por la sequía |
| El pleno del Parlament ha avalado este miércoles el decreto ley del Govern para afrontar la situación... |
 Europa Press Europa Press | 20m | |
|
|
|
 | María Gámez explica su dimisión como directora de la Guardia Civil |
| La directora de la Guardia Civil, María Gámez, ha presentado su renuncia esta mañana al ministro del... |
 Europa Press Europa Press | 20m | |
|
|
|
 | La Torre de los Anaya de Salamanca acoge dos obras del artista Zacarías González |
| La sala de exposiciones de la Torre de los Anaya en Salamanca ha abierto sus puertas a "la parte más... |
 Europa Press Europa Press | 20m | |
|
|
|
 | Nacho: "No se trata de que el Real Madrid me dé más años" |
| El defensa del Real Madrid y la selección española Nacho Fernández reiteró este miércoles que quiere... |
 Europa Press Europa Press | 20m | |
|
|
|
 | MESSERMORD AUF KIRMES IN MÜNSTER: Tatverdächtiger stellt sich! Fahndungsdruck war... |
| MESSERMORD AUF KIRMES IN MÜNSTER: Tatverdächtiger stellt sich! Fahndungsdruck war wohl zu hoch Der... |
| |
|
|
|
 | Residents of Belgian town living through nightmare of 'forever chemical' pollution |
| PFAS are a group of over 9,000 man-made chemicals that are used in products including textiles, cars... |
 euronews (in English) euronews (in English) | 21m | |
|
|
|
 | Europe's Decision | Exclusive interview with Charles Michel #shorts #EuropeNews |
| "We are defending the democratic principles and values by supporting Ukraine as much as we can." ... |
 euronews (in English) euronews (in English) | 21m | |
|
|
|
 | Exclusive: The EU is 'not naïve' about ever-closer Russia-China ties, says Charles... |
| In an exclusive interview with Euronews, European Council President Charles Michel discussed the Ukraine... |
 euronews (in English) euronews (in English) | 21m | |
|
|
|
 | Uganda passes a bill to imprison people who identify as LGBTQ+ |
| Uganda passes a bill to imprison people who identify as LGBTQ+ and could face life imprisonment or even... |
 euronews (in English) euronews (in English) | 21m | |
|
|
|
 | Policeman knocks out protester in Paris |
| A policeman punched and knocked unconscious a protester during Monday (March 20) night's rowdy demonstrations... |
| |
|
|
|
 | March 22, 2023: China, Russia meeting, California floods, Federal Reserve, LGBTQ... |
| Five stories to know today: 1. Russia launched a swarm of drones into Ukraine, killing at least... |
| |
|
|
|
 | NGO plants 30,000 trees to reforest a mangrove |
| A Brazilian NGO planted over 30,000 trees to reforest a mangrove wetland to mark World Water Day in an... |
| |
|
|
|
 | LIVE: Former British Prime Minister Boris Johnson gives evidence in 'partygate' inquiry |
| Former British Prime Minister Boris Johnson gives evidence to an inquiry into whether he intentionally... |
| |
|
|
|
 | msnbcleanforward's YouTube Videos: Joe: Trump is horrified; he's just talking big... |
| ... |
 Trump News TV from Michael_Novakhov (10 sites) Trump News TV from Michael_Novakhov (10 sites) | 27m | |
|
|
|
 | ABC News's YouTube Videos: New developments in Trump classified documents investigation... |
| ... |
 Trump News TV from Michael_Novakhov (10 sites) Trump News TV from Michael_Novakhov (10 sites) | 27m | |
|
|
|
 | MidweekPolitics's YouTube Videos: Desperate, panicked Trump releases insane midnight... |
| ... |
 Trump News TV from Michael_Novakhov (10 sites) Trump News TV from Michael_Novakhov (10 sites) | 27m | |
|
|
|
 | msnbcleanforward's YouTube Videos: Former Watergate prosecutor: The whole world is... |
| ... |
 Trump News TV from Michael_Novakhov (10 sites) Trump News TV from Michael_Novakhov (10 sites) | 27m | |
|
|
|
 | FoxNewsChannel's YouTube Videos: Alvin Bragg cares more about getting Trump than... |
| ... |
 Trump News TV from Michael_Novakhov (10 sites) Trump News TV from Michael_Novakhov (10 sites) | 27m | |
|
|
|
 | MidweekPolitics's YouTube Videos: LIVE: Donald Trump's 1st 2024 Campaign Rally in... |
| ... |
 Trump News TV from Michael_Novakhov (10 sites) Trump News TV from Michael_Novakhov (10 sites) | 27m | |
|
|
|
 | Russia's war on Ukraine: Latest 'propaganda stunt' demonstrates how 'desperate' Vladimir... |
| Russian President Vladimir Putin made a surprise trip to Mariupol, his first visit to territory captured... |
 FRANCE 24 English FRANCE 24 English | 28m | |
|
|
|
 | Trump 2024: Indictment would be a 'major disturbance for the campaign' and quest... |
| The decision whether to indict former President Donald Trump over hush-money payments made on his behalf... |
 FRANCE 24 English FRANCE 24 English | 28m | |
|
|
|
 | UBS takeover 'right stabilizing move': 'Run on Credit Suisse not a systemic run on... |
| UBS's emergency takeover of its troubled Swiss rival Credit Suisse, with significant backing and arm-twisting... |
 FRANCE 24 English FRANCE 24 English | 28m | |
|
|
|
 | Dean's Home Video: Lucky Hank, Rabbit Hole, Up Here, Yellowjackets Season 2 — and... |
| WGN Entertainment Reporter Dean Richards previews all the new shows and movies released this week in... |
| |
|
|
|
| My Opiion: Putin and Xi: more pomp and circumstance than the substance, which can... |
| #Putin #Xi #YUAN Putin and Xi: more pomp and circumstance than the substance, which can be described... |
 The News And Times The News And Times | 29m | |
|
|
|
 | Rueda de prensa de la Casa Blanca, 22 de marzo |
| La secretaria de Prensa de la Casa Blanca, Karine Jean-Pierre, responde las preguntas de los periodistas... |
 NOTICIAS TELEMUNDO NOTICIAS TELEMUNDO | 29m | |
|
|
|
 | Boris Johnson 'risks being a pound shop Nigel Farage' says NI Minister |
| A crunch vote on the key part of the legislation is set to take place, where MPs will decide whether... |
| |
|
|
|
 | Jacob Rees-Mogg asked if he's a 'pound shop Nigel Farage' |
| Jacob Rees-Mogg asked if he's a 'pound shop Nigel Farage' after Steve Baker accuses Johnson of risking... |
| |
|
|
|
 | Watch live: Boris Johnson quizzed by the privileges committee on partygate |
| Former prime minister Boris Johnson appears in front of the privileges committee as he is questioned... |
| |
|
|
|
 | Biden teases 2024 run during WH arts ceremony |
| President Joe Biden teased a 2024 run during a White House awards ceremony, telling Bruce Springsteen:... |
| |
|
|
|
 | New developments in Trump classified documents investigation |
| Sources tell ABC News that a federal judge determined there's compelling preliminary evidence former... |
| |
|
|
|
 | "Обними, если против войны" #shorts |
| "Обними, если против войны", с таким плакатом вышел на улицу Ижевска 20-летний Никита Горбунов. Никита... |
 Радио Свобода Радио Свобода | 31m | |
|
|
|
 | В Греции снова ходят поезда |
| Железнодорожное сообщение в Греции восстанавливается после катастрофы ЧИТАТЬ ДАЛЕЕ : https://ru.euronews.com/2023/03/22/greece-trains-restart... |
 euronews (на русском) euronews (на русском) | 35m | |
|
|
|
 | Federal Reserve to decide on interest rate hikes amid banking sector turmoil |
| As the Federal Reserve is expected to decide on whether to raise interest rates, some on Wall Street... |
| |
|
|
|
 | India: What's causing the spike in Covid cases? | WION Dispatch |
| As India continues to witness a rapid surge in COVID-19 cases, the top medical body tasked with making... |
| |
|
|
|
 | Earthquake in Afghanistan kills at least 13, eleven of them in Pakistan | WION Dispatch |
| At least 13 people were killed and more than 90 injured in Pakistan and Afghanistan after a magnitude... |
| |
|
|
|
 | Privileges committee to grill Boris Johnson over partygate scandal | WION Dispatch |
| Boris Johnson is set to be grilled by the Privileges Committee to establish whether he knowingly misled... |
| |
|
|
|
 | Pakistan's parliament meets for special session amid crisis over ex-PM Imran Khan... |
| Pakistan's parliament is holding a special joint session amid a crisis over anti-government protests... |
| |
|
|
|
 | India: Bengaluru based company's viral post about hiring Chief Meme Officer with... |
| Here, we bring you the news that is trending across WION's social media platforms - If you enjoy making... |
| |
|
|
|
 | Joe: Trump is horrified; he's just talking big and the walls are closing in |
| The Morning Joe panel discusses a possible indictment of former President Trump and his response to the... |
| |
|
|
|
 | noticeloficial's YouTube Videos: El Push de la Mañana para el 21 de marzo de 2023 |
| ... |
 Puerto Rico News Videos from Michael_Novakhov (20 sites) Puerto Rico News Videos from Michael_Novakhov (20 sites) | 37m | |
|
|
|
 | WATCH LIVE: Blinken testifies on State Department budget and diplomacy before Senate... |
| Stream your PBS favorites with the PBS app: https://to.pbs.org/2Jb8twG Find more from PBS NewsHour... |
 PBS NewsHour PBS NewsHour | 38m | |
|
|
|
 | 🔴 En vivo ViX: La Voz de la Mañana 10:00 A.M., 22 de marzo de 2023 |
| En @VIX ésta y más noticias 24 horas Noticias 24/7 en ViX: https://bit.ly/3LBhvTK #ViX en redes... |
 Univision Noticias Univision Noticias | 38m | |
|
|
|
 | En un minuto: Gran jurado se reúne para evaluar cargos contra Trump por el caso Stormy... |
| En otras noticias, hay expectativa por el anuncio de la Reserva Federal sobre las tasas de interés en... |
 Univision Noticias Univision Noticias | 38m | |
|
|
|
 | Stephen Smith case: Family attorney says ruling reversal by state is rare, incredible... |
| Stephen Smith's mother has been working by herself for eight years to bring justice for her son's death.... |
 NewsNation Now NewsNation Now | 40m | |
|
|
|
 | Protesters Scatter Garbage in Paris Over Macron's Pension Reform |
| Public opposition to the French government's pension reform is getting messy, especially in central Paris.... |
 TicToc by Bloomberg TicToc by Bloomberg | 41m | |
|
|
|
 | Muslims prepare to celebrate the holy month of Ramadan |
| (22 Mar 2023) Authorities in several Middle Eastern countries say this year's fasting month of Ramadan... |
 Associated Press Associated Press | 42m | |
|
|
|
 | The "mega-basins" in agriculture | AFP |
| How can water be stored for reuse in agriculture? There are two main systems: the rainwater reservoir... |
| |
|
|
|
 | Therapy, pirate-style #OurFlagMeansDeath #iPlayer |
| 1717: hapless Stede Bonnet has a midlife crisis and hits the high seas as a 'gentleman pirate'. It does... |
| |
|
|
|
 | Former Watergate prosecutor: The whole world is watching our criminal justice system |
| Criminal defense attorney Jon Sale and Palm Beach State Attorney Dave Aronberg join Morning Joe to discuss... |
| |
|
|
|
 | Rishi Sunak calls relationship between Met Police and Sadiq Khan 'dysfunctional' |
| The Prime Minister Rishi Sunak called the relationship between London's Metropolitan Police and The Mayor... |
 The Independent The Independent | 45m | |
|
|
|
 | Starmer says Tories 'should be ashamed' about the number of rapists that get convicted |
| Watch more videos at the Independent TV: https://www.independent.co.uk/tv/editors-picks Click... |
 The Independent The Independent | 45m | |
|
|
|
 | Earthquake in Pakistan and Afghanistan leaves several dead - BBC News |
| At least 13 people have been killed and more than 200 injured after a powerful earthquake shook large... |
| |
|
|
|
 | VOA's Bill Gallo Reports From Seoul |
| ▶️ VOA's Bill Gallo in Seoul, South Korea, reports on the US. and South Korea joint military drills... |
| |
|
|
|
 | Top Republicans split on Ukraine aid as 2024 primary takes shape |
| Foreign policy and the future of aid to Ukraine are poised to become a top issues for Republican candidates... |
| |
|
|
|
 | LIVE: Latest News on March 22, 2023 | Prime Time with John Dickerson |
| We're covering all of the day's top stories and more on "Prime Time with John Dickerson." #news... |
| |
|
|
|
 | LIVE: Top Political News on March 22, 2023 | "Red & Blue" |
| "Red & Blue" reports on the top political stories of the day. #news #politics #livenews .. |
| |
|
|
|
 | Former Trump White House attorney Ty Cobb calls possible indictment "a very... |
| A New York grand jury is considering whether to indict former President Donald Trump, which could be... |
| |
|
|
|
 | Listen Live: Supreme Court hears arguments in Jack Daniel's trademark case | CBS... |
| The Supreme Court is hearing arguments in a trademark case involving whiskey maker Jack Daniel's. The... |
| |
|
|
|
 | TROTZ GEWALTSAMER PROTESTE: Frankreich boxt Rentenreform durch – Macron betreibt... |
| In Frankreich ist es erneut zu Protesten gegen die umstrittene Rentenreform gekommen. Wie die Polizei... |
| |
|
|
|
 | Vara: Extremadura será una "potencia verde" en España |
| El presidente de la Junta, Guillermo Fernández Vara, ha participado en el acto de colocación de la primera... |
 Europa Press Europa Press | 50m | |
|
|
|
 | Andalucía "bate récord" de inversión extranjera gracias a la política económica... |
| La consejera de Economía, Hacienda y Fondos Europeos, Carolina España, ha mantenido este miércoles un... |
 Europa Press Europa Press | 50m | |
|
|
|
 | Desperate, panicked Trump releases insane midnight video #shorts |
| -- A desperate and panicked Donald Trump releases a bizarre video at midnight https://projects.fivethirtyeight.com/polls/president-primary-r/... |
 David Pakman Show David Pakman Show | 52m | |
|
|
|
 | CBSNewsOnline's YouTube Videos: Former Trump White House attorney Ty Cobb calls possible... |
| ... |
 Trump News TV from Michael_Novakhov (10 sites) Trump News TV from Michael_Novakhov (10 sites) | 55m | |
|
|
|
 | msnbcleanforward's YouTube Videos: TikTok operates as a sophisticated surveillance... |
| ... |
 Trump News TV from Michael_Novakhov (10 sites) Trump News TV from Michael_Novakhov (10 sites) | 55m | |
|
|
|
 | CBSNewsOnline's YouTube Videos: Listen Live: Supreme Court hears arguments in Jack... |
| ... |
 Trump News TV from Michael_Novakhov (10 sites) Trump News TV from Michael_Novakhov (10 sites) | 55m | |
|
|
|
 | Fracasa la moción de censura del candidato Tamames |
| Madrid, 22 mar (EFE).- La segunda moción de censura de Vox contra el presidente del Gobierno, Pedro Sánchez,... |
 AGENCIA EFE AGENCIA EFE | 56m | |
|
|
|
 | Macron says ready to accept 'unpopularity' over pensions reform • FRANCE 24 English |
| French President Emmanuel Macron on Wednesday said he was prepared to accept unpopularity as a consequence... |
 FRANCE 24 English FRANCE 24 English | 57m | |
|
|
|
 | 'Democratic crisis': France's Macron defiant on pension reform despite uproar • FRANCE... |
| French President Emmanuel Macron on Wednesday defiantly vowed to push through a controversial pensions... |
 FRANCE 24 English FRANCE 24 English | 57m | |
|
|
|
 | Uganda leader urged to reject 'appalling' anti-LGBTQ bill • FRANCE 24 English |
| Uganda's President Yoweri Museveni faced calls Wednesday from the United Nations and rights groups to... |
 FRANCE 24 English FRANCE 24 English | 57m | |
|
|
|
 | Zelensky visits Ukraine army positions near Bakhmut • FRANCE 24 English |
| President Volodymyr Zelensky on Wednesday visited military positions near the frontline town of Bakhmut... |
 FRANCE 24 English FRANCE 24 English | 57m | |
|
|
|
 | 'Vampiric' water use leading to 'imminent' global crisis, UN warns • FRANCE 24 English |
| Lead Author on UN world water development report Richard Connor speaks out about imminent danger of water... |
 FRANCE 24 English FRANCE 24 English | 57m | |
|
|
|
 | Macron stands firm on pension bill, says to enter into force by year-end • FRANCE... |
| French President Emmanuel Macron on Wednesday said a deeply unpopular new law that raises the retirement... |
 FRANCE 24 English FRANCE 24 English | 57m | |
|
|
|
 | Pollution in Brazil's Guanabara Bay spoils postcard image of Rio • FRANCE 24 English |
| Located beside the Brazilian city of #RiodeJaneiro, Guanabara Bay is home to rich #biodiversity and represents... |
 FRANCE 24 English FRANCE 24 English | 57m | |
|
|
|
 | EN VIVO: La corte donde un jurado decide si imputa cargos a Trump por pagos a Stormy... |
| Agencias de seguridad se preparan para la posibilidad de que el expresidente Donald Trump sea acusado... |
 NOTICIAS TELEMUNDO NOTICIAS TELEMUNDO | 58m | |
|
|
|
 | El Push de la Mañana para el 21 de marzo de 2023 |
| Para más noticias de Puerto Rico visite NotiCel.com NotiCel™| La verdad como es. |
| |
|
|
|
 | WATCH LIVE | Legal action filed against Little Village Discount Mall owner |
| LIVE | Ald. Byron Sigcho-Lopez (25th Ward) plans to update the public Wednesday on "legal litigation... |
| |
|
|
|
 | Stanhope CEO Sees 'Substantial Consequences' of Bank Crisis |
| Stanhope Capital Chief Executive Officer Daniel Pinto says of the banking crisis, "I agree we are not... |
 Bloomberg TV Markets and Finance Bloomberg TV Markets and Finance | 1h | |
|
|
|
 | 25 people injured after large ship dislodges in Edinburgh dry dock |
| A major rescue operation is ongoing at Imperial Dock in Leith after the vessel lurched towards its right-hand... |
 Sky News Sky News | 1h | |
|
|
|
 | "A Just Compensation": Iraqi Peace Activist Reflects on 2003 U.S. Invasion |
| As we continue to look back on the 20th anniversary of the U.S. invasion of Iraq, we're joined by Sami... |
 Democracy Now! Democracy Now! | 1h | |
|
|
|
 | Andrew Bacevich on China's Growing Influence & Marking 20 Years Since U.S. Invasion... |
| Andrew Bacevich is a historian, co-founder of the Quincy Institute for Responsible Statecraft and a retired... |
 Democracy Now! Democracy Now! | 1h | |
|
|
|
 | Top U.S. & World Headlines — March 22, 2023 |
| Democracy Now! is an independent global news hour that airs on over 1,500 TV and radio stations Monday... |
 Democracy Now! Democracy Now! | 1h | |
|
|
|
 | TikTok operates as a sophisticated surveillance tool, says FCC commissioner |
| TikTok's CEO is set to testify before the House on Thursday, and FCC Commissioner Brendan Carr joins... |
| |
|
|
|
 | Шарль Мишель в интервью Euronews: ЕC "не наивен" в отношении российско-китайского... |
| Евросоюз "не наивен" в отношении дипломатического сближения России и Китая на фоне войны в Украине, заявил... |
 euronews (на русском) euronews (на русском) | 1h | |
|
|
|
 | 2023 Hyundai Verna Walkaround - The MOST POWERFUL SEDAN in the Segment Gets ADAS!... |
| The all-new 2023 Hyundai Verna has launched in India with introductory prices starting from INR 10.90... |
| |
|
|
|
 | Dutch and Polish jets perform joint NATO air exercise I WION Shorts |
| Polish and Dutch fighter jet pilots participated in a joint exercise on March 21. Polish MiG-29s &... |
| |
|
|
|
 | Встреча Си и Путина: станет ли Россия придатком Китая? | Козырев Online |
| Тема сегодняшнего Козырев Online: «Как думаете, станет ли Россия придатком Китая?» Звоните нам... |
 tvrainru tvrainru | 1h | |
|
|
|
 | Biden awards 2021 National Medals of the Arts and Humanities in star-studded ceremony |
| In a star-studded ceremony at the White House on Tuesday, President Biden awarded the 2021 National Medal... |
 NBC News NBC News | 1h | |
|
|
|
 | Alvin Bragg cares more about getting Trump than his crime-infested city | Will Cain... |
| 'Fox & Friends Weekend' co-host Will Cain discusses the potential arrest of former President Donald... |
 Fox News Fox News | 1h | |
|
|
|
 | The World News And Times - 3.22.23 |
| The World News And Times - The News And TimesThe World News And Times - theworldnewsandtimes.com | The... |
 The News And Times The News And Times | 1h | |
|
|
|
 | CCTV Man Set on Fire in Birmingham: Arrest Made |
| A man has been arrested following an attack on a man who was set on fire while walking home from a mosque... |
| |
|
|
|
 | LAUSD strike continues for second day Wednesday |
| Los Angeles Unified School District campuses remained closed Wednesday morning as a district-wide strike... |
 CBS Los Angeles CBS Los Angeles | 1h | |
|
|
|
 | Potholes close State Route 71 in both directions in Pomona |
| All lanes of State Route 71 were closed in both directions at Holt Avenue and Valley Boulevard in Pomona... |
 CBS Los Angeles CBS Los Angeles | 1h | |
|
|
|
 | XXXTentacion's Grandma Reacts to Guilty Verdict in Rapper's Tragic Murder |
| XXXTentacion's grandmother, Yvonne Kerr, spoke to the Law&Crime Network's Jesse Weber about the sweeping... |
 LawNewz Network LawNewz Network | 1h | |
|
|
|
 | Secretary Blinken testifies before the Senate Committee on Appropriations, Subcommittee... |
| Secretary of State Antony J. Blinken testifies before the Senate Committee on Appropriations, Subcommittee... |
 U.S. Department of State U.S. Department of State | 1h | |
|
|
|
 | TikTok unveils updated rules, standards ahead of CEO's congressional testimony |... |
| TikTok's CEO says there will be a new firewall put in place that will protect the data from U.S. users... |
 NewsNation Now NewsNation Now | 1h | |
|
|
|
 | Rep. Matt Gaetz: Will Manhattan DA indict Trump? | Morning in America |
| Rep. Matt Gaetz says there's an expectation for Manhattan DA Alvin Bragg to indict former President Trump,... |
 NewsNation Now NewsNation Now | 1h | |
|
|
|
 | Fit at any age: 61-year-old woman redefines how to be fit | Morning in America |
| Sheryl Grant, the founder and CEO of "Fit for Life," won her first Miss Olympia title in 2017 at 55.... |
 NewsNation Now NewsNation Now | 1h | |
|
|
|
 | Trump probe: Legal expert on possible indictment | Morning in America |
| The Manhattan grand jury in the hush money probe has yet to meet and make its decision on whether to... |
 NewsNation Now NewsNation Now | 1h | |
|
|
|
 | Four-day work weeks gain popularity | Morning in America |
| Trials of four-day work weeks have overwhelmingly shown successful results, with happier workers and... |
 NewsNation Now NewsNation Now | 1h | |
|
|
|
 | LIVE: Federal Reserve interest rate Jerome Powell decision announcement | LiveNOW... |
| Subscribe to LiveNOW from FOX! https://www.youtube.com/livenowfox?sub_confirmation=1 Where to watch... |
 FOX 10 Phoenix FOX 10 Phoenix | 1h | |
|
|
|
 | 'My Olympic gold': Fashion icon Vera Wang receives one of nation's highest honors |
| Iconic fashion designer Vera Wang joins "CNN This Morning" to discuss being honored with the National... |
| |
|
|
|
 | WATCH LIVE: Norfolk Southern CEO testifies on East Palestine derailment at Senate... |
| Stream your PBS favorites with the PBS app: https://to.pbs.org/2Jb8twG Find more from PBS NewsHour... |
 PBS NewsHour PBS NewsHour | 1h | |
|
|
|
 | John Cornyn: This Is What I Told The President Of Mexico |
| In Senate floor remarks on Tuesday, Sen. John Cornyn (R-TX) detailed his discussions with Mexican President... |
 Forbes Under 30 Forbes Under 30 | 1h | |
|
|
|
 | Timeline of the military situation near Bakhmut from August 1, 2022 to March 20,... |
| Timeline of the military situation near Bakhmut from August 1, 2022 to March 20, 2023 VIDEOGRAPHIC .. |
| |
|
|
|
 | WATCH: Norfolk Southern CEO testifies on Ohio train derailment |
| Norfolk Southern CEO Alan Shaw testifies to senators on March 22 about the train derailment in East Palestine,... |
 Washington Post Washington Post | 1h | |
|
|
|
 | Trump supporters rally outside of Mar-a-Lago |
| Trump supporters gathered outside of his Mar-a-Lago resort in Palm Beach, Fla., as the former president... |
 Washington Post Washington Post | 1h | |
|
|
|
 | Cow ESCAPES Slaughterhouse, Runs Through Streets of Brooklyn | NBC New York |
| The cow was finally corralled after dodging cars and those trying to capture it Tuesday afternoon. NBC... |
 NBC New York NBC New York | 1h | |
|
|
|
| |
| Saved Web Pages - Daily Report at 9 p.m. - Will China save Russia from a defeat in Ukraine? thenewsandtimes.blogspot.com/2023/03/saved-…... |
 Tweets by @mikenov Tweets by @mikenov | 1h | |
|
|
|
 | Trump-Stormy Daniels Investigation: The Path to a Possible Indictment | WSJ |
| As Donald Trump faces a possible indictment over hush-money allegedly paid to Stormy Daniels, WSJ's Joe... |
 Wall Street Journal Wall Street Journal | 1h | |
|
|
|
 | Gwyneth Paltrow 'bolted' after 'slamming' into elderly skier, court told |
| A US courtroom has heard that Gwyneth Paltrow allegedly "slammed" into a fellow skier before she "bolted"... |
 The Independent The Independent | 1h | |
|
|
|
 | Boris Johnson leaves home ahead of Partygate grilling |
| Former prime minister Boris Johnson was seen leaving his home in London ahead of his televised appearance... |
 The Independent The Independent | 1h | |
|
|
|
 | Rudy Giuliani recites nursery rhyme I'm A Little Teapot on Cameo |
| Rudy Giuliani, the former New York City Mayor and ex-personal lawyer to former President Donald Trump,... |
 The Independent The Independent | 1h | |
|
|
|
 | Ex-MI6 spy Christopher Steele records message for Donald Trump |
| Christopher Steele, the former head of the MI6 Russia desk who authored a controversial opposition research... |
 The Independent The Independent | 1h | |
|
|
|
 | The full exchange: Keir Starmer and Rishi Sunak clash over Casey report findings... |
| Rishi Sunak clashed with Keir Starmer over the Casey report, hours before his Brexit deal goes to a vote... |
 The Independent The Independent | 1h | |
|
|
|
 | PMQs: Sunak 'appalled' by findings from Casey report into Metropolitan Police misconduct |
| Rishi Sunak has said that he is appalled by the findings of the Casey Report into misconduct within the... |
 The Independent The Independent | 1h | |
|
|
|
 | PMQs: Keir Starmer makes Partygate jibe towards Rishi Sunak in fiery Commons exchange |
| Keir Starmer has accused Rishi Sunak of being negligent about lockdown parties during ahead of the Partygate... |
 The Independent The Independent | 1h | |
|
|
|
 | The full exchange: Stephen Flynn grills Rishi Sunak over Northern Ireland Brexit... |
| SNP leader at Westminister Stephen Flynn grilled prime minister Rishi Sunak over the Northern Ireland... |
 The Independent The Independent | 1h | |
|
|
|
 | Live: Boris Johnson questioned in Partygate committee hearing |
| Watch live as Boris Johnson gives evidence to a parliamentary committee on standards over his role in... |
 The Independent The Independent | 1h | |
|
|
|
 | Live: View of Trump Tower as investigation into Stormy Daniels hush money continues |
| Watch a live view of Trump Tower as the investigation into payments made to Stormy Daniels continues.... |
 The Independent The Independent | 1h | |
|
|
|
 | Keir Starmer calls Rishi Sunak 'out of touch' |
| "The Prime Minister stands there and pretends that everything's fine. He is totally out of touch." .. |
 Times Radio Times Radio | 1h | |
|
|
|
 | Новая баллада Филиппа Киркорова #музыка #киркоров #знаменитости #shorts |
| Читай нас на сайте: https://www.kp.ru/ И присоединяйся к нам в соцсетях: ➡️Rutube https://rutube.ru/u/kpru/... |
 Комсомольская Правда Комсомольская Правда | 1h | |
|
|
|
 | "За Путина – молюсь" | Что думают москвичи о возможности примирения России... |
| "Примирение невозможно", "Далеко мы зашли", "Нас не очень все любят", "Нам еще достанется", "За Путина... |
 Радио Свобода Радио Свобода | 1h | |
|
|
|
 | Big banks will continue to take market share from the regionals, says Hightower's... |
| Stephanie Link, Hightower Advisors chief investment strategist and CNBC contributor, joins 'Squawk Box'... |
 CNBC Television CNBC Television | 1h | |
|
|
|
 | Fed's 'freshmen' in focus as markets brace for interest rate decision |
| Ahead of today's Federal Reserve decision, CNBC's Steve Liesman highlights a wild card in the process:... |
 CNBC Television CNBC Television | 1h | |
|
|
|
 | LIVE: Moderna CEO Stéphane Bancel testifies on potential Covid vaccine price hike... |
| The U.S. Senate Committee on Health, Education, Labor and Pension holds a hearing on Moderna's potential... |
 CNBC Television CNBC Television | 1h | |
|
|
|
 | Petco CEO: Inflation in 2023 will be roughly even at year's end |
| Petco CEO Ron Coughlin joins 'Squawk Box' to discuss the company's quarterly earnings results, the impact... |
 CNBC Television CNBC Television | 1h | |
|
|
|
 | The Fed shouldn't raise the rate at all, says Dynamic Fund's Blackstein |
| Noah Blackstein, senior portfolio manager at Dynamic Funds, joins 'Squawk Box' to discuss what he thinks... |
 CNBC Television CNBC Television | 1h | |
|
|
|
 | Economists expect a 25 bps rate hike |
| CNBC's Steve Liesman reports on what economists expect from the Federal Reserve later today. For access... |
 CNBC Television CNBC Television | 1h | |
|
|
|
 | Joanne Lipman breaks down her new book on reinvention in life & work |
| Joanne Lipman, Author and Yale University lecturer, joins 'Squawk Box' to discuss her new book, 'Next!... |
 CNBC Television CNBC Television | 1h | |
|
|
|
 | We need to reconsider the capital regulation of banks: Columbia professor Piskorski |
| Columbia Business School Professor Tomasz Piskorski joins 'Squawk Box' to discuss whether banks should... |
 CNBC Television CNBC Television | 1h | |
|
|
|
 | Watch Live: Senate committee holds hearing on rail safety following Ohio train derailment... |
| Ohio Gov. Mike DeWine, Senators Sherrod Brown and J.D. Vance, and others are testifying before a Senate... |
 CBS News CBS News | 1h | |
|
|
|
 | В Уганде принят закон, запрещающий людям идентифицировать себя как ЛГБТК+ |
| Однополые отношения уже запрещены в стране. Нарушителям закона грозит тюремное заключение и даже смертная... |
 BBC Russian BBC Russian | 1h | |
|
|
|
 | The News And Times Posts Review |
| The News And Times - thenewsandtimes.comThe News And Times - thenewsandtimes.comPosts ReviewThe News... |
 The News And Times The News And Times | 1h | |
|
|
|
 | El Centro de Ciberseguridad de Andalucía abrirá sus puertas en Málaga la próxima... |
| El Centro de Ciberseguridad de Andalucía abrirá sus puertas la próxima semana en el Palmeral de las Sorpresas,... |
 Europa Press Europa Press | 1h | |
|
|
|
 | Vecino relata que las víctimas del incendio estaban "desesperadas" |
| Declaraciones de uno de los vecinos del edificio incendiado en Rubí, Reinaldo Márquez, que ha explicado... |
 Europa Press Europa Press | 1h | |
|
|
|
 | Abogada dice que el presunto asesino del niño "buscaba matar" |
| Alicia Redondo, abogada de la familia de Álex, el niño de 9 años asesinado en Lardero (La Rioja), ha... |
 Europa Press Europa Press | 1h | |
|
|
|
 | Asens dice que Sumar y Podemos coinciden en celebrar primarias |
| El presidente del grupo parlamentario de Unidas Podemos en el Congreso, Jaume Asens, ha manifestado este... |
 Europa Press Europa Press | 1h | |
|
|
|
 | Fernández-Pacheco asegura que "no se levantarán de la mesa" hasta alcanzar... |
| El consejero de Sostenibilidad, Medio Ambiente y Economía Azul, Ramón Fernández-Pacheco, ha asegurado... |
 Europa Press Europa Press | 1h | |
|
|
|
 | Abascal cree demostrado que el PP aspira a pactar con el PSOE |
| El presidente de Vox, Santiago Abascal, cree que la moción de censura ha servido para demostrar que el... |
 Europa Press Europa Press | 1h | |
|
|
|
 | El Constitucional rechaza el recurso de Vox y avala la ley de la eutanasia |
| El Tribunal Constitucional (TC) ha rechazado en su Pleno de este miércoles el recurso formulado por Vox... |
 Europa Press Europa Press | 1h | |
|
|
|
 | SEM confirma que han atendido a 23 personas en el incendio de Rubí |
| El subjefe territorial del SEM, Fran Tebar, ha explicado que en el incendio que se ha producido en un... |
 Europa Press Europa Press | 1h | |
|
|
|
 | SEM confirma que han atendido a 23 personas en el incendio de Rubí |
| El subjefe territorial del SEM, Fran Tebar, ha explicado que en el incendio que se ha producido en un... |
 Europa Press Europa Press | 1h | |
|
|
|
 | El Congreso tumba la moción de Tamames, que suma el voto afirmativo de Vox y de un... |
| El Pleno del Congreso ha rechazado este miércoles la moción de censura presentada por Vox con el economista... |
 Europa Press Europa Press | 1h | |
|
|
|
 | SCHÜSSE BEI REICHSBÜRGER-RAZZIA: Polizei befragt Zeugen – "Und dann hat er das... |
| SCHÜSSE BEI REICHSBÜRGER-RAZZIA: Polizei befragt Zeugen – "Und dann hat er das Feuer eröffnet" Bei... |
| |
|
|
|
 | LIVE: Donald Trump's 1st 2024 Campaign Rally in Waco, Texas |
| Support the stream: https://streamlabs.com/thedavidpakmanshow Support the stream, get a Membership at... |
 David Pakman Show David Pakman Show | 1h | |
|
|
|
 | Japan celebrates World Baseball Classic win |
| With cherry blossoms reaching full bloom in Tokyo, Japanese sports fans erupted in jubilation after their... |
 Reuters Reuters | 1h | |
|
|
|
 | CBSNewsOnline's YouTube Videos: LIVE: Latest News, Breaking Stories and Analysis... |
| ... |
 Trump News TV from Michael_Novakhov (10 sites) Trump News TV from Michael_Novakhov (10 sites) | 1h | |
|
|
|
 | Dimite la directora general de la Guardia Civil |
| Madrid, 22 mar (EFE). (Imagen: Manuel Única).- La directora general de la Guardia Civil, María Gámez,... |
 AGENCIA EFE AGENCIA EFE | 1h | |
|
|
|
 | Сергей Безруков и Анна Матисон: как служебный роман перерос в счастливую семью |
| Сергей Безруков и Анна Матисон обвенчались в церкви после 8 лет брака. Супруги воспитывают троих детей... |
 Комсомольская Правда Комсомольская Правда | 1h | |
|
|
|
 | Noticias Telemundo En La Noche, 22 de marzo 2023 | Noticias Telemundo |
| Video oficial de Noticias Telemundo. Mira lo último en las principales historias del día, más allá de... |
 NOTICIAS TELEMUNDO NOTICIAS TELEMUNDO | 1h | |
|
|
|
 | Noticias Telemundo Mediodía, 22 de marzo de 2023 | Noticias Telemundo |
| Video oficial de Noticias Telemundo. Mira lo último en las principales historias del día, más allá de... |
 NOTICIAS TELEMUNDO NOTICIAS TELEMUNDO | 1h | |
|
|
|
 | After a disaster left dozens of migrants dead will the EU reconsider its asylum policies?... |
| Search teams are still scouring the sea for bodies in the wake of a deadly shipwreck near Crotone in... |
 DW (English) DW (English) | 1h | |
|
|
|
 | 'Bloomberg Surveillance: Early Edition' Full (03/22/23) |
| Bloomberg Surveillance: Early Edition, live from London and New York. Francine Lacqua, Anna Edwards,... |
 Bloomberg TV Markets and Finance Bloomberg TV Markets and Finance | 1h | |
|
|
|
 | AT1s Are 'Absolutely Not' Dead, Says Algebris CEO Serra |
| Davide Serra, founder and CEO at Algebris, says, "I don't think the system isn't safe," as he discusses... |
 Bloomberg TV Markets and Finance Bloomberg TV Markets and Finance | 1h | |
|
|
|
 | US Plan to Rush Abrams to Ukraine? Refurbished Older M1A1 Variants Instead of The... |
| The US is accelerating its delivery of Abrams tanks to Ukraine, by sending a refurbished older model... |
| |
|
|
|
 | Multiple people injured after large ship dislodges in Edinburgh dry dock |
| Specialist trauma teams, ambulances, fire crews and police are on the scene with pictures posted on social... |
 Sky News Sky News | 1h | |
|
|
|
 | PMQs: Labour leader says Prime Minister is 'totally out of touch' |
| Sir Keir Starmer has criticised Rishi Sunak in PMQs, calling him out of "touch" with the country. .. |
 Sky News Sky News | 1h | |
|
|
|
 | New Zealanders happier than Australians according to polling |
| New Zealand has made the World Happiness Report's list of the world's top ten happiest countries ahead... |
 SkyNewsAustralia SkyNewsAustralia | 1h | |
|
|
|
 | Finland ranked happiest country with more heavy metal bands per capita than anywhere... |
| Finland has been listed as the happiest country in the world according to the World Happiness Report... |
 SkyNewsAustralia SkyNewsAustralia | 1h | |
|
|
|
 | 'This is how the national broadcaster treats us': ABC staff go on strike mid-broadcast |
| A small group of ABC staff went on strike mid-broadcast on Wednesday, says Sky News host Liz Storer.... |
 SkyNewsAustralia SkyNewsAustralia | 1h | |
|
|
|
 | WION Live Broadcast: World Latest English News | English News | International News... |
| WION Live Broadcast: World Latest English News | English News | International News | WION #WIONLiveBroadcast... |
| |
|
|
|
 | Lionel Messi back in Argentina to take part in international friendlies | WION Sports |
| Lionel Messi, who just a few months ago lifted the World Cup in Qatar has joined Argentina camp for international... |
| |
|
|
|
 | TikTok trackers embedded in US state-government websites | Latest English News |... |
| According to a new report from a cybersecurity company, more than two dozen state governments have placed... |
| |
|
|
|
 | UK says no nuclear escalation in Ukraine after row over depleted uranium munitions... |
| Britain's Foreign Secretary James Cleverly said on Wednesday there was no nuclear escalation in the Ukraine... |
| |
|
|
|
 | Boris Johnson faces fight for political future at Partygate hearing | Latest English... |
| Boris Johnson faces a battle for his political future on Wednesday after a dossier setting out his defence... |
| |
|
|
|
 | Boris Johnson and Liz Truss to vote against Sunak's NI Brexit deal | Latest News... |
| Two former prime ministers, Boris Johnson and Liz Truss, are to vote against Rishi Sunak's new Brexit... |
| |
|
|
|
 | Leo Sbaraglia con su carrera a todo vapor espera "dirigir una película" |
| Buenos Aires, 22 mar (EFE).- Leonardo Sbaraglia está en un buen momento. No para de rodar películas y... |
 AGENCIA EFE AGENCIA EFE | 1h | |
|
|
|
 | President Xi wraps up Russia trip with message to the West |
| Chinese President Xi Jinping has left Russia after a series of high-profile meetings with Russian President... |
 NBC News NBC News | 1h | |
|
|
|
 | LIVE: White House holds press briefing | NBC News |
| Watch as White House Press Secretary Karine Jean-Pierre holds a press briefing. » Subscribe to NBC... |
 NBC News NBC News | 1h | |
|
|
|
 | Dick Van Dyke on the Masked Singer #shorts #dickvandyke |
| #shorts #maskedsinger #dickvandyke Not all of our videos can be shown to a public YouTube audience.... |
 Facts Verse Facts Verse | 1h | |
|
|
|
 | Boris Johnson Risks "Looking Like a Pound Shop Nigel Farage" - Steve Baker's... |
| 'Boris Johnson Risks "Looking Like a Pound Shop Nigel Farage" - Steve Baker's Verdict ' In blue-on-blue... |
| |
|
|
|
 | WATCH LIVE: Gwyneth Paltrow Ski Crash Trial — Sanderson v. Paltrow — Day Two |
| Actress Gwyneth Paltrow is set to face off with a retired doctor in a civil trial starting March 21 over... |
 LawNewz Network LawNewz Network | 1h | |
|
|
|
 | Гаргульи возвращаются на фасад Нотр-Дама |
| На протяжении веков они не только служили для отвода дождевой воды, но и защищали собор от "сил зла".... |
 euronews (на русском) euronews (на русском) | 1h | |
|
|
|
 | Гаргульи возвращаются на фасад Нотр-Дама |
| На протяжении веков они не только служили для отвода дождевой воды, но и защищали собор от "сил зла".... |
 euronews (на русском) euronews (на русском) | 1h | |
|
|
|
 | Kyiv has destroyed Russian 'Kalibr' cruise missiles being transported in Russian-annexed... |
| Ukraine war in maps: Kyiv has destroyed Russian 'Kalibr' cruise missiles being transported in Russian-annexed... |
 euronews (in English) euronews (in English) | 1h | |
|
|
|
 | Greece begins gradual restart of train services, three weeks after rail disaster |
| Greece begins gradual restart of train services, three weeks after rail disaster READ MORE : https://www.euronews.com/2023/03/22/greece-begins-g... |
 euronews (in English) euronews (in English) | 1h | |
|
|
|
 | Mary Yoon's Weather Forecast (March 22) |
| Soggy and cold morning, rain continues through Wednesday, diminishing early Thursday morning. Drying... |
 CBS Los Angeles CBS Los Angeles | 1h | |
|
|
|
 | "La gente está muerta de miedo": piden evacuar a pueblo de California por riesgo... |
| Los residentes de Porterville han tenido que evacuar sus casas por el crecimiento del río Tule en California.... |
 Univision Noticias Univision Noticias | 1h | |
|
|
|
 | Así logró un peatón detener en plena calle a un hombre armado que huía de la policía |
| El sospechoso estaba siendo perseguido por la policía tras un altercado en una bodega de Nueva York,... |
 Univision Noticias Univision Noticias | 1h | |
|
|
|
 | "Les ofrecen un iPhone o iPad": denuncian el uso de menores para traficar fentanilo... |
| Las autoridades de los puertos de entrada en la frontera de México y EEUU aseguran que las bandas criminales... |
 Univision Noticias Univision Noticias | 1h | |
|
|
|
 | US Superbug fungus cases rose dramatically during pandemic |
| (22 Mar 2023) US Superbug fungus cases rose dramatically during pandemic Subscribe for more Breaking... |
 Associated Press Associated Press | 1h | |
|
|
|
 | Pensions: dockers blockade the port of Brest | AFP |
| Dockers and port workers blockade the port of Brest as part of a "dead ports" day called by the CGT union... |
| |
|
|
|
 | Удар России по многоэтажке в Запорожье | Путин врёт о ядерном оружии | Пропаганда... |
| В Запорожье под обстрел попал жилой многоэтажный дом. Погиб один человек, 25 пострадавших находятся в... |
 Штаб Навального Штаб Навального | 1h | |
|
|
|
 | "Freedom" from dictatorship isn't enough when the result is civil war: reflecting... |
| |
 GZERO Media GZERO Media | 1h | |
|
|
|
 | Gutfeld: Our country is facing a deadly crisis |
| 'Gutfeld!' panelists discuss several school districts suing social media giants alleging they are contributing... |
 Fox News Fox News | 1h | |
|
|
|
 | Duo steals $8k in jewelry, cash from NYC home: NYPD |
| A Manhattan couple woke up to thousands of dollars worth of items stolen from their East Village apartment... |
 PIX11 News PIX11 News | 1h | |
|
|
|
 | Indigenous Engineer Joins UN Water Conference |
| Yurok student shares lessons from her tribe's 20-year campaign to remove dams Originally published... |
 VOA News VOA News | 1h | |
|
|
|
 | "Мерзкое быдло издевается над военнопленным" #shorts |
| Российский офицер, бежавший из России, рассказал, как его командир пытал пленного украинского солдата.... |
 Радио Свобода Радио Свобода | 1h | |
|
|
|
 | "Здесь Путина не любят" #shorts |
| В Тбилиси протестовали против принятия по примеру России репрессивного закона об иноагентах Подпишитесь... |
 Радио Свобода Радио Свобода | 1h | |
|
|
|
 | La agenda: Oklahoma aprueba el aborto para preservar la vida de la madre |
| La Corte Suprema de Oklahoma aprueba el aborto para preservar la vida de la madre. Publicado originalmente |
 Voz de América Voz de América | 1h | |
|
|
|
 | "LETZTE GENERATION" KÖNNTE EIGENE PARTEI PLANEN: Gefahr für die Grünen... |
| Nach Recherchen von WELT hat es Hinweise darauf gegeben, dass die Klimagruppe "Letzte Generation" womöglich... |
| |
|
|
|
 | María Gámez presenta su dimisión como directora general de la Guardia Civil |
| María Gámez presenta su dimisión como directora general de la Guardia Civil #guardiacivil #dimisión |
 Europa Press Europa Press | 1h | |
|
|
|
 | Desarticulado un laboratorio en un operativo antidroga gallego |
| Al menos dieciocho personas han sido detenidas en el transcurso de una operación antidroga que ha permitido... |
 Europa Press Europa Press | 1h | |
|
|
|
 | Bombers indican que el incendio se produjo en la entrada del edificio |
| El jefe del dispositivo de Bombers en el incendio de Rubí (Barcelona), Pep Colás, ha explicado que el... |
 Europa Press Europa Press | 1h | |
|
|
|
 | Andalucía destinará más de 14 millones a crear un nodo de ciberseguridad sobre salud... |
| Andalucía, País Vasco y Castilla y León, junto con El Instituto Nacional de Ciberseguridad de España... |
 Europa Press Europa Press | 1h | |
|
|
|
 | La jueza de 'Mediador' admite que PP, PSOE y Vox ejerzan acusación contra el Tito... |
| La juez del denominado 'caso Mediador' ha admitido que el PP, PSOE y Vox ejerzan la acusación popular... |
 Europa Press Europa Press | 1h | |
|
|
|
 | Andalucía lamenta que el TC no suspenda el impuesto de las grandes fortunas |
| La consejera de Economía, Hacienda y Fondos Europeos, Carolina España, ha lamentado este miércoles que... |
 Europa Press Europa Press | 1h | |
|
|
|
 | Alcaldesa de Rubí lamenta la muerte de los tres vecinos |
| Declaraciones de la alcaldesa de Rubí (Barcelona), Ana Maria Martínez, en las que ha lamentado la muerte... |
 Europa Press Europa Press | 1h | |
|
|
|
 | Elena señala que los fallecidos en Rubí podrían haber muerto por inhalación de humo |
| El conseller de Interior, Joan Ignasi Elena, ha explicado que la investigación de Bombers de la Generalitat... |
 Europa Press Europa Press | 1h | |
|
|
|
 | Andalucía "no tira la toalla" para un acuerdo con Gobierno sobre Doñana |
| El consejero de Sostenibilidad, Medio Ambiente y Economía Azul, Ramón Fernández-Pacheco, ha sostenido... |
 Europa Press Europa Press | 1h | |
|
|
|
 | Detenidos los seis presuntos autores de la agresión a dos agentes de Vigilancia Aduanera |
| Agentes de la Policía Nacional han detenido en La Línea de la Concepción (Cádiz) a seis personas, de... |
 Europa Press Europa Press | 1h | |
|
|
|
 | 'Partygate': Boris Johnson faces high-stakes grilling in UK lockdown parties inquiry... |
| Britain's former prime minister Boris Johnson will face hours of questioning by a committee of U.K. lawmakers... |
 Global News Global News | 1h | |
|
|
|
 | Watch Alex Wagner Tonight Highlights: March 21 |
| Watch Alex Wagner Tonight Tuesday through Friday at 9 p.m. ET. » Subscribe to MSNBC: http://on.msnbc.com/SubscribeTomsnbc... |
| |
|
|
|
 | Watch The 11th Hour Highlights: March 21 |
| Watch highlights from Tuesday's The 11th Hour. » Subscribe to MSNBC: http://on.msnbc.com/SubscribeTomsnbc... |
| |
|
|
|
 | Watch The ReidOut With Joy Reid Highlights: March 21 |
| Tune into The Reidout weekdays at 7 p.m. ET on MSNBC. » Subscribe to MSNBC: http://on.msnbc.com/SubscribeTomsnbc... |
| |
|
|
|
 | Kicking the Football Habit |
| When Buffalo Bills tight end Damar Hamlin collapsed of cardiac arrest after making a tackle, it set off... |
| |
|
|
|
 | What life is like without a water supply | Al Jazeera Newsfeed |
| "Since the first day we never had access to water." Joanna Valencia and her children escaped violence... |
 Al Jazeera English Al Jazeera English | 1h | |
|
|
|
 | msnbcleanforward's YouTube Videos: Watch The 11th Hour Highlights: March 21 |
| ... |
 Trump News TV from Michael_Novakhov (10 sites) Trump News TV from Michael_Novakhov (10 sites) | 1h | |
|
|
|
 | msnbcleanforward's YouTube Videos: Watch The ReidOut With Joy Reid Highlights: March... |
| ... |
 Trump News TV from Michael_Novakhov (10 sites) Trump News TV from Michael_Novakhov (10 sites) | 1h | |
|
|
|
 | bbcnews's YouTube Videos: Black #SanFrancisco residents could get $5m each in reparations... |
| ... |
 Trump News TV from Michael_Novakhov (10 sites) Trump News TV from Michael_Novakhov (10 sites) | 1h | |
|
|
|
 | ABC News's YouTube Videos: Start Here Podcast - March 22, 2023 | ABC News |
| ... |
 Trump News TV from Michael_Novakhov (10 sites) Trump News TV from Michael_Novakhov (10 sites) | 1h | |
|
|
|
 | Уганда: депутаты криминализировали гомосексуальность |
| Новый нормативный акт предусматривает наказание не только за однополый секс, но и за причисление себя... |
 euronews (на русском) euronews (на русском) | 1h | |
|
|
|
 | Historic Maras Bazaar reopens after the devastating quakes |
| Six weeks after the devastating earthquakes, life in the Turkish city of Kahramanmaras is slowly returning... |
 TRT World TRT World | 1h | |
|
|
|
 | Mr. Rogers asks WGN employees — 'What makes you angry?' |
| Mr. Rogers asks WGN employees — 'What makes you angry?' |
 WGN News WGN News | 1h | |
|
|
|
 | MPs vote on Windsor Framework in Commons |
| Northern Ireland Secretary Chris Heaton-Harris leads debate on the Windsor Framework in the House of... |
 Sky News Sky News | 2h | |
|
|
|
 | BREAKING: 25 people injured after ship dislodges in Edinburgh dry dock |
| 25 people have been injured, with 15 of them being treated in the hospital after a large ship became... |
 Sky News Sky News | 2h | |
|
|
|
 | Senior protesters cut up credit cards, quit 'bad-climate' US banks I WION Shorts |
| Senior climate activists cut up their credit cards in Washington D.C. on March 21. The "Old & Bold... |
| |
|
|
|
 | This Morning's Top Headlines – March 22 |
| A New York grand jury reconvenes to decide on whether to indict former President Trump, a Fox News employee... |
 NBC News NBC News | 2h | |
|
|
|
 | El agua y el saneamiento llegan a una barriada argentina abandonada por el Estado |
| Buenos Aires, 22 mar (EFE), (Imagen: Alberto Caratozzolo).- Las calles son un basurero, los cruces son... |
 AGENCIA EFE AGENCIA EFE | 2h | |
|
|
|
 | NSW Premier and Opposition leader go head to head in People's Forum debate |
| NSW Premier Dominic Perrottet and Opposition leader Chris Minns have gone head to head in the Sky News/The... |
 SkyNewsAustralia SkyNewsAustralia | 2h | |
|
|
|
 | Matt Kean 'might as well retire and go fishing': Mark Latham |
| NSW Treasurer Matt Kean "might as well retire and go fishing" following polls showing a 39 per cent drop... |
 SkyNewsAustralia SkyNewsAustralia | 2h | |
|
|
|
 | One Nation is the 'best chance of putting a handbrake' on the Labor-Green radical... |
| The One Nation party is the "best chance of putting a handbrake" on the Labor-Green radical policies,... |
 SkyNewsAustralia SkyNewsAustralia | 2h | |
|
|
|
 | 'Would be happy to have either': Perrottet and Minns' calibre is 'so far above' Victoria |
| Sky News host Rita Panahi says she looked on "jealously" at the Sky News People's Forum debate between... |
 SkyNewsAustralia SkyNewsAustralia | 2h | |
|
|
|
 | VERDICT WATCH: Obsessed Ex-Boyfriend Murder Trial — WI v. Zachariah Anderson - Day... |
| Wisconsin man Zachariah Anderson faces trial for charges in connection with the disappearance and death... |
 LawNewz Network LawNewz Network | 2h | |
|
|
|
 | Watch Live: Killer Teen Sentencing -- FL v. Aiden Fucci -- Day Two |
| Last month, 16-year-old Aiden Fucci pleaded guilty to murdering 13-year-old former classmate Tristyn... |
 LawNewz Network LawNewz Network | 2h | |
|
|
|
 | WATCH LIVE: Ice Cream Man Double Murder Retrial — FL v. Michael Keetley — Day 13 |
| Former ice cream truck driver Michael Keetley is facing a retrial for allegedly shooting six people on... |
 LawNewz Network LawNewz Network | 2h | |
|
|
|
 | LA schools strike: Workers call for 30% pay raise, more hours | Morning in America |
| Thousands of Los Angeles service workers, backed by teachers, will hit the picket lines Wednesday for... |
 NewsNation Now NewsNation Now | 2h | |
|
|
|
 | Jack Daniels says it was mocked by dog toy company. What will SCOTUS say? | Morning... |
| The Supreme Court is set to hear arguments Wednesday on whether a dog toy spoofing Jack Daniel's bottles... |
 NewsNation Now NewsNation Now | 2h | |
|
|
|
 | UnivisionNoticias's YouTube Videos: Lo mejor de La Voz de la Mañana del miércoles... |
| ... |
 Puerto Rico News Videos from Michael_Novakhov (20 sites) Puerto Rico News Videos from Michael_Novakhov (20 sites) | 2h | |
|
|
|
 | Sandstorm puts Beijing's air quality into very hazardous level |
| China's capital city of Beijing was affected by dense sandstorms that severely affected visibility, shrouding... |
 NBC News NBC News | 2h | |
|
|
|
 | DeSantis Breaks Silence On Possible Trump Indictment — Here's What You Need To Know |
| Former President Donald Trump faces a possible indictment in connection to alleged hush-money payments... |
 Forbes Under 30 Forbes Under 30 | 2h | |
|
|
|
 | Black #SanFrancisco residents could get $5m each in reparations plan. #Shorts #USA... |
| |
 BBC News BBC News | 2h | |
|
|
|
 | Chinese J-11 Fighters 'Shoot Down' Indian Mirage 2000 Jets |
| |
 World Affairs World Affairs | 2h | |
|
|
|
 | China is using VFX to destroy Indian Mirage and Rafale Fighters |
| A video circulating on the Chinese microblogging platform Weibo shows an animated aerial battle between... |
 World Affairs World Affairs | 2h | |
|
|
|
 | Gaming goals 😍😍😍Mario Kart on the big baseball screen! 🙌 #BBCSport #iPlayer |
| |
| |
|
|
|
 | Woman raped in Brooklyn driveway: NYPD |
| Police are searching for a man who allegedly raped a woman in Sheepshead Bay on March 18, 2023. |
 PIX11 News PIX11 News | 2h | |
|
|
|
 | Bronx fire engulfs 2 homes, mars third building: FDNY |
| A massive four-alarm fire tore through a vacant home early Wednesday in Highbridge, then spread to two... |
 PIX11 News PIX11 News | 2h | |
|
|
|
 | NYC restaurants reflect on three years since shutdown |
| The city's restaurants are still facing challenges. So where does the industry stand today, and what... |
 CBS New York CBS New York | 2h | |
|
|
|
 | Marvell Technology to cut about 4% of the workforce |
| CNBC's 'Squawk Box' anchors present the day's financial news. |
 CNBC Television CNBC Television | 2h | |
|
|
|
 | If the Fed keeps raising rates, you're going to have a lot of banks in trouble: Mark... |
| Mark Mobius, Mobius Capital founding partner, joins 'Squawk Box' to discuss Mobius' chief concerns with... |
 CNBC Television CNBC Television | 2h | |
|
|
|
 | Inflation jump deepens UK cost-of-living crisis |
| British inflation unexpectedly rose to 10.4% in February, pushed up by higher food and drink prices in... |
 Reuters Reuters | 2h | |
|
|
|
 | Gwyneth Paltrow in Utah court, accused of violently crashing into a man while skiing |
| Actress and businesswoman Gwyneth Paltrow attended the first day of a trial in Utah on Tuesday (March... |
 Reuters Reuters | 2h | |
|
|
|
 | Endangered monarch butterfly population falls 22% |
| The population of monarch butterflies that arrived in Mexico's forests to hibernate this winter fell... |
 Reuters Reuters | 2h | |
|
|
|
 | PRO: Watch CNBC's full interview with former Goldman Sachs CEO Lloyd Blankfein |
| Lloyd Blankfein, former Goldman Sachs CEO, joins 'Squawk Box' to discuss if the recent banking crisis... |
 CNBC Television CNBC Television | 2h | |
|
|
|
 | Ethridge: The Fed should hit the pause button and wait to see how things wash out... |
| Malcolm Ethridge of CIC Wealth says what he thinks the Fed should do isn't necessarily what they will... |
 CNBC Television CNBC Television | 2h | |
|
|
|
 | "PROVOKATION" VON ISRAEL? Jüdische Siedler dürfen laut Knesset-Beschluss... |
| Das israelische Parlament hat ein seit Jahren bestehendes Gesetz zugunsten jüdischer Siedler geändert.... |
| |
|
|
|
 | La Junta de Andalucía destaca que la Ley de Economía Circular cuida del medio natural |
| El consejero de Sostenibilidad, Medio Ambiente y Economía Azul, Ramón Fernández-Pacheco, ha destacado... |
 Europa Press Europa Press | 2h | |
|
|
|
 | LIVE: Latest News, Breaking Stories and Analysis on March 22 | CBS News |
| Law enforcement remains on high alert ahead of a potential grand jury indictment of former President... |
 CBS News CBS News | 2h | |
|
|
|
 | Start Here Podcast - March 22, 2023 | ABC News |
| #interestrates #losangeles #foxnews The Federal Reserve is expected to raise interest rates again,... |
 ABC News ABC News | 2h | |
|
|
|
 | En Comú Podem ve al Ejecutivo fortalecido tras la moción |
| La portavoz de En Comú Podem, Aina Vidal, ha afirmado en declaraciones en el patio del Congreso de los... |
 Europa Press Europa Press | 2h | |
|
|
|
 | La Junta de Andalucía pide "cautela" ante el "error" en fecundación... |
| El portavoz del Gobierno de la Junta de Andalucía y consejero de Sostenibilidad, Medio Ambiente y Economía... |
 Europa Press Europa Press | 2h | |
|
|
|
 | Madrid Río cerrará la "brecha" del Calderón con el ajardinamiento de la... |
| El alcalde de Madrid, José Luis Martínez Almeida,ha informado de que la culminación definitiva del icónico... |
 Europa Press Europa Press | 2h | |
|
|
|
 | msnbcleanforward's YouTube Videos: Watch The Last Word With Lawrence O'Donnell Highlights:... |
| ... |
 Trump News TV from Michael_Novakhov (10 sites) Trump News TV from Michael_Novakhov (10 sites) | 2h | |
|
|
|
 | msnbcleanforward's YouTube Videos: 'I kinda like it': DeSantis laughs at Trump's... |
| ... |
 Trump News TV from Michael_Novakhov (10 sites) Trump News TV from Michael_Novakhov (10 sites) | 2h | |
|
|
|
 | bbcnews's YouTube Videos: Global water crisis looming, UN says - BBC News |
| ... |
 Trump News TV from Michael_Novakhov (10 sites) Trump News TV from Michael_Novakhov (10 sites) | 2h | |
|
|
|
 | whitehouse's YouTube Videos: President Biden and The First Lady Host a Reception... |
| ... |
 Trump News TV from Michael_Novakhov (10 sites) Trump News TV from Michael_Novakhov (10 sites) | 2h | |
|
|
|
 | whitehouse's YouTube Videos: Press Briefing by Press Secretary Karine Jean-Pierre |
| ... |
 Trump News TV from Michael_Novakhov (10 sites) Trump News TV from Michael_Novakhov (10 sites) | 2h | |
|
|
|
 | Nuevas protestas por reforma de las pensiones en Francia #Shorts | Noticias Telemundo |
| Short oficial de Noticias Telemundo. Más de 230 personas fueron detenidas en medio de disturbios en los... |
 NOTICIAS TELEMUNDO NOTICIAS TELEMUNDO | 2h | |
|
|
|
 | TikTok se defiende y promete cambios #Shorts | Noticias Telemundo |
| Short oficial de Noticias Telemundo. El director ejecutivo de esta red que está en la mira de las autoridades... |
 NOTICIAS TELEMUNDO NOTICIAS TELEMUNDO | 2h | |
|
|
|
 | La bomba ciclónica que azota a California se cobra ya una primera vida #Shorts |... |
| Short oficial de Noticias Telemundo. La víctima falleció por la caída de un árbol sobre su vehículo en... |
 NOTICIAS TELEMUNDO NOTICIAS TELEMUNDO | 2h | |
|
|
|
 | This Is the Banking Crisis of the Rich: Algebris CEO |
| Davide Serra, founder and CEO at Algebris, characterizes the current issues in banking as "the banking... |
 Bloomberg TV Markets and Finance Bloomberg TV Markets and Finance | 2h | |
|
|
|
 | Singapur es el país con el mayor consumo de agua embotellada del mundo |
| Singapur, 22 mar (EFE).- Singapur es el país con el mayor consumo per cápita de agua embotellada del... |
 AGENCIA EFE AGENCIA EFE | 2h | |
|
|
|
 | Fauci simply cannot admit this: Joe Concha |
| Fox News contributor Joe Concha discusses Rep. James Comer's demands that Biden own up to Chinese payouts... |
 Fox News Fox News | 2h | |
|
|
|
 | Russia Reports Drone Attack On Oil Facility, Ukraine Targets Border Region of Bryansk... |
| A Russian oil pumping station on the Druzhba pipeline near the Ukrainian border has been attacked. Russia... |
| |
|
|
|
 | Watch live: Police and Crime Committee explore findings in Met Police with Commissioner... |
| Susan Hall chairs a Police and Crime Committee meeting with with Commissioner Sir Mark Rowley after a... |
 Sky News Sky News | 2h | |
|
|
|
 | 6@6: The average price of bachelorette parties |
| 6@6: The average price of bachelorette parties |
 WGN News WGN News | 2h | |
|
|
|
 | Deadliest weapons in use by Putin's men in Ukraine: Tanks to hypersonic missiles|... |
| Russia-Ukraine war live: Have a look at the new generations of weapons in which Russia says it is investing... |
| |
|
|
|
 | Active Covid cases in India cross 7,000 mark | WION Exclusive |
| There is an increase in the number of Covid-19 cases in India. The country has recorded 1,134 new Covid-19... |
| |
|
|
|
 | US: 'Extremely troubled' by new Israeli settlements law | Israel-Palestine tensions... |
| The Israeli parliament on Tuesday decided to repeal a law banning four settlements in the occupied West... |
| |
|
|
|
 | Rising knife crime in England & Wales |
| The overall number of crimes in England and Wales has majorly come down, but knife crime is on the rise.... |
| |
|
|
|
 | Russian drones swarm Kyiv in display of force as Xi Jinping leaves Moscow | Russia-Ukraine... |
| Russian President Vladimir Putin said that China's Ukraine "peace plan" could be discussed and that Moscow... |
| |
|
|
|
 | Most Powerful Military soundtracks 2023 | Most Powerful and Beautiful Music | War... |
| Most Powerful Military soundtracks 2023 | Most Powerful and Beautiful Music | War Battle Epic Mix .. |
 War Epic Music War Epic Music | 2h | |
|
|
|
 | Lo mejor de La Voz de la Mañana del miércoles 22 de marzo de 2023 |
| Este miércoles los ojos están puestos en Nueva York y crece la expectativa, ya que un gran jurado puede... |
 Univision Noticias Univision Noticias | 2h | |
|
|
|
 | Dominic Perrottet 'missed' a couple of opportunities to hit back at Chris Minns in... |
| NSW Premier Dominic Perrottet "missed" a couple of opportunities to hit back at Chris Minns during the... |
 SkyNewsAustralia SkyNewsAustralia | 2h | |
|
|
|
 | People's Forum 'always good' because nobody knows what questions will be asked |
| The People's Forums are always good because nobody knows what questions are going to be asked, according... |
 SkyNewsAustralia SkyNewsAustralia | 2h | |
|
|
|
 | Matt Kean a 'massive turn-off' in places NSW Liberals need to win |
| Matt Kean is a "massive turn-off" in the places the New South Wales Liberal National Party need to win,... |
 SkyNewsAustralia SkyNewsAustralia | 2h | |
|
|
|
 | Minns was 'punchy' and 'relatable': Labor leader wins NSW People's Forum |
| Chris Minns was "more relatable" and "punchy" during the Sky News People's Forum as the NSW Opposition... |
 SkyNewsAustralia SkyNewsAustralia | 2h | |
|
|
|
 | Words Matter More with Kel Richards: The term 'mullet' officially identified in 1994 |
| The "mullet" haircut officially become known as a mullet in 1994, even though this feels too recent for... |
 SkyNewsAustralia SkyNewsAustralia | 2h | |
|
|
|
 | Watch The Last Word With Lawrence O'Donnell Highlights: March 21 |
| Watch highlights from The Last Word with Lawrence O'Donnell. » Subscribe to MSNBC: http://on.msnbc.com/SubscribeTomsnbc... |
| |
|
|
|
 | GOP voters give brutal assessment of Mike Pence. Hear what they said |
| The Atlantic staff writer McKay Coppins joins "CNN This Morning" to discuss his article about former... |
| |
|
|
|
 | Jack Daniel's trademark fight over dog toy goes to SCOTUS | Morning in America |
| The Supreme Court on Wednesday will hear arguments on whether a dog toy spoofing Jack Daniel's bottles... |
 NewsNation Now NewsNation Now | 2h | |
|
|
|
 | Stephen Smith's death now ruled a homicide by state | Morning in America |
| Stephen Smith's death, which was initially ruled a hit and run, has now officially been ruled a homicide... |
 NewsNation Now NewsNation Now | 2h | |
|
|
|
 | Are Fox News legal affairs hurting its brand? | Morning in America |
| Colby Hall says it depends on the person's initial thoughts about Fox News. He says for those who don't... |
 NewsNation Now NewsNation Now | 2h | |
|
|
|
 | Biden quips about re-election while issuing arts medals to Bruce Springsteen and... |
| While honouring back-to-back Pulitzer Prize winner Colson Whitehead, the President hints that he may... |
 Sky News Sky News | 2h | |
|
|
|
 | Northern Ireland: Rees-Mogg to vote against Windsor Framework alongside the ERG |
| The former Business Secretary minister was speaking to political correspondent Ali Fortescue after the... |
 Sky News Sky News | 2h | |
|
|
|
 | Watch live: Sunak faces Starmer at PMQs ahead of Johnson committee grilling |
| Prime Minister Rishi Sunak faces questions from Labour leader Sir Keir Starmer at PMQs. Politics... |
 Sky News Sky News | 2h | |
|
|
|
 | President Biden and The First Lady Host a Reception Celebrating Women's History Month |
| The White House |
 The White House The White House | 2h | |
|
|
|
 | Press Briefing by Press Secretary Karine Jean-Pierre |
| The White House |
 The White House The White House | 2h | |
|
|
|
 | Richard Engel on Iraq post- US invasion: mixed legacy #shorts |
| |
 GZERO Media GZERO Media | 2h | |
|
|
|
 | The Best of Vivaldi |
| 🎵 Buy the MP3 album "Bach and Vivaldi: The Best of Baroque Music" on the Official Halidon Music Store:... |
 HALIDONMUSIC HALIDONMUSIC | 2h | |
|
|
|
 | Classical Music for Studying | POMODORO 25/5 |
| |
 HALIDONMUSIC HALIDONMUSIC | 2h | |
|
|
|
 | 5 children rescued from storm drain on SI: officials |
| Five children were rescued from a storm drain in Clove Lakes Park after climbing in Tuesday evening,... |
 PIX11 News PIX11 News | 2h | |
|
|
|
 | Know before you go: Wednesday, March 22 |
| Chris Wragge, Mary Calvi and Elise Finch have the latest news and weather headlines from CBS2. |
 CBS New York CBS New York | 2h | |
|
|
|
 | Gwyneth Paltrow in court over skiing accident |
| Gwyneth Paltrow was in court for the first day of the trial in Summit County, Utah, where she is accused... |
 NBC News NBC News | 2h | |
|
|
|
 | Grand jury to decide on possible Trump indictment |
| A grand jury is set to reconvene to discuss a possible indictment against former President Trump over... |
 NBC News NBC News | 2h | |
|
|
|
 | China says it has 'not provided weapons to any party' in Ukraine war | AFP |
| China says that it was not the one "who created the crisis in Ukraine" and that it has "not provided... |
| |
|
|
|
 | US-West Africa Military Exercise Introduces Maritime Training |
| Flintlock, the United States-led annual joint military exercises in West Africa, is introducing maritime... |
 VOA News VOA News | 2h | |
|
|
|
 | HABECKS HEIZUNGSVERBOT: Hausbesitzer in Panik – "Nerven liegen blank bei den... |
| Bundeswirtschafts- und Klimaschutzminister Robert Habeck (Grüne) hat die Diskussion rund um Klimaschutz... |
| |
|
|
|
 | Watch again: Amphibious Assault Ship USS Makin Island arrives in South Korea |
| Amphibious Assault Ship USS Makin Island arrives in South Korea to join large-scale Ssangyong amphibious... |
 The Independent The Independent | 2h | |
|
|
|
 | Watch again: British politicians give news conference in Taiwan |
| News conference by visiting British lawmakers to Taiwan, hosted by Taiwan Foreign Ministry. Source:... |
 The Independent The Independent | 2h | |
|
|
|
 | PP dice que la "España real" hablará en las próximas elecciones |
| La portavoz del PP en el Congreso de los Diputados, Cuca Gamarra, ha afirmado tras la votación al Gobierno... |
 Europa Press Europa Press | 2h | |
|
|
|
 | El Congreso tumba la moción de Tamames, que sólo se suma al voto de Vox un exdiputado... |
| El Pleno del Congreso ha rechazado este miércoles la moción de censura presentada por Vox con el economista... |
 Europa Press Europa Press | 2h | |
|
|
|
 | Abogado de pareja que ha denunciado al SAS por fecundación "errónea" desconoce... |
| Ignacio Martínez, el abogado del matrimonio que ha reclamado al Servicio Andaluz de Salud (SAS) un millón... |
 Europa Press Europa Press | 2h | |
|
|
|
 | Biden's hometown has reservations about his re-election |
| Voters in US President Joe Biden's hometown of Scranton, Pennsylvania, express concerns about his advanced... |
 Reuters Reuters | 2h | |
|
|
|
 | Sneakers help Nike sprint past forecasts |
| Nike raised its full-year revenue outlook after reporting quarterly results that beat estimates, but... |
 Reuters Reuters | 2h | |
|
|
|
 | Will Indonesia's new capital be a threat to wildlife? |
| Environmentalists are wary that the construction of Indonesia's new capital, Nusantara, would disturb... |
 Reuters Reuters | 2h | |
|
|
|
 | WARNING: GRAPHIC CONTENT - Ten indicted in Virginia over Irvo Otieno's death |
| A Virginia grand jury formally indicted 10 people, including police officers and hospital workers, over... |
 Reuters Reuters | 2h | |
|
|
|
 | How does China benefit from sanctions on Russia? |
| With Russia under pressure to sell surplus volumes of oil and coal no longer going to the EU due to sanctions,... |
 Reuters Reuters | 2h | |
|
|
|
 | Экс-солист группы «На-На» Валерий Юрин подтянул лицо ради девушки |
| 56-летний экс-солист группы «На-На» Валерий Юрин готовится к свадьбе с 20-летней возлюбленной. Ранее... |
 Комсомольская Правда Комсомольская Правда | 2h | |
|
|
|
 | В Норильске бушуют метели |
| Видимость на дорогах плохая, а ветер свистит до 30 м/с. И все это безобразие, если верить синоптикам,... |
 Комсомольская Правда Комсомольская Правда | 2h | |
|
|
|
 | Dan sorpresa a niño que padece un tumor cerebral #Shorts | Noticias Telemundo |
| Short oficial de Noticias Telemundo. Elijah, un menor de 11 años que sufre de un tumor en la cabeza,... |
 NOTICIAS TELEMUNDO NOTICIAS TELEMUNDO | 2h | |
|
|
|
 | Las noticias de la mañana, miércoles 22 de marzo de 2023 | Noticias Telemundo |
| Video oficial de Noticias Telemundo. El mal tiempo deja a unos 140,000 usuarios sin energía eléctrica... |
 NOTICIAS TELEMUNDO NOTICIAS TELEMUNDO | 2h | |
|
|
|
 | Украина: новые удары. Что не так с НАТОвским оружием. Экстрасенсы снова в моде. DW... |
| Ведущие программы Татьяна Фельгенгауэр и Александр Плющев вместе с русской редакцией DW выбирают темы,... |
 DW (Russian) DW (Russian) | 2h | |
|
|
|
 | Macron aims to 'calm things down' in address to France over pension changes • FRANCE... |
| President Emmanuel Macron will look to "calm things down" with a televised interview on Wednesday amid... |
 FRANCE 24 English FRANCE 24 English | 2h | |
|
|
|
 | Pension reform protests in France may impact King Charles' visit • FRANCE 24 English |
| Protests in France may impact plans for a planned state visit by Britain's King Charles next week, a... |
 FRANCE 24 English FRANCE 24 English | 2h | |
|
|
|
 | Macron defiant as anger smoulders over French pension reform • FRANCE 24 English |
| French President Emmanuel Macron told allies Tuesday he plans to keep the government in place and not... |
 FRANCE 24 English FRANCE 24 English | 2h | |
|
|
|
 | Israeli government lifts ban on return to West Bank settlements • FRANCE 24 English |
| The Israeli parliament on Tuesday paved the way for Jewish settlers' return to four settlements in the... |
 FRANCE 24 English FRANCE 24 English | 2h | |
|
|
|
 | Hundreds protest pension reforms in Paris ahead of Macron interview • FRANCE 24 English |
| Hundreds of protesters denouncing the French government's proposed pension reform gathered on Tuesday... |
 FRANCE 24 English FRANCE 24 English | 2h | |
|
|
|
 | Xi departs Russia after 'new era' summit with Putin • FRANCE 24 English |
| Chinese leader Xi Jinping left Russia on Wednesday after a summit with President Vladimir Putin that... |
 FRANCE 24 English FRANCE 24 English | 2h | |
|
|
|
 | Trump's 2024 'train wreck': Quest for power 'best chance of avoiding criminal prosecution' |
| Donald Trump will try to turn any indictment to his advantage by stoking anger among core supporters... |
 FRANCE 24 English FRANCE 24 English | 2h | |
|
|
|
 | Amid mounting legal battles, Trump's hush money case 'the most trivial of all the... |
| Barricades set up near Trump Tower, police on high alert, and throngs of journalists outside the prosecutor's... |
 FRANCE 24 English FRANCE 24 English | 2h | |
|
|
|
 | Latest weapons in use by the Zelensky's Ukraine against Russian invasion | Russia-Ukraine... |
| Ukrainian Military Arsenal Live: Have a look at military vehicles and equipment used by the Ukrainian... |
| |
|
|
|
 | First permanent US military garrison opens in Poland | Polish MiG-29s & Dutch F-35s... |
| Polish and Dutch fighter jet pilots participated in a joint exercise on Tuesday (March 21) from the northern... |
| |
|
|
|
 | Paltrow court case continues |
| (22 Mar 2023) On Wednesday, Gwyneth Paltrow is expected to appear in court for a trial in which she's... |
 Associated Press Associated Press | 3h | |
|
|
|
 | Wilde, Klum, walk carpet at Fashion Awards |
| (22 Mar 2023) Stars including Olivia Wilde, Demi Moore, Heidi Klum, Alessandra Ambrosio, and Kate Beckinsale... |
 Associated Press Associated Press | 3h | |
|
|
|
 | Death of Buster Murdaugh's classmate ruled a homicide |
| Buster Murdaugh has denied any involvement in the death of 19-year-old Stephen Smith back in 2015. #FoxNews... |
 Fox News Fox News | 3h | |
|
|
|
 | Удар по жилому дому в Запорожье. Шойгу не ответил, когда ждать мира. Умер экс-глава... |
| Включайте новости на Дожде в 15.00 мск. В эфире Денис Катаев В этом выпуске: Российские войска... |
 tvrainru tvrainru | 3h | |
|
|
|
 | Latest news bulletin | March 22nd – Midday |
| Catch up with the most important stories from around Europe and beyond - latest news, breaking news,... |
 euronews (in English) euronews (in English) | 3h | |
|
|
|
 | Abascal señala a Sánchez como el "líder de la manada que ha premiado a 800 violadores" |
| El líder de Vox, Santiago Abascal, ha señalado este miércoles al presidente del Gobierno, Pedro Sánchez,... |
 Europa Press Europa Press | 3h | |
|
|
|
 | Tamames afea a Sánchez que se crea "el Gobierno salvador" |
| El economista Ramón Tamames ha acusado este miércoles al presidente del Gobierno, Pedro Sánchez, de estar... |
 Europa Press Europa Press | 3h | |
|
|
|
 | Unai Sordo tilda de "grotesca parodia" la maniobra de VOX aprovechando... |
| "Una grotesca parodia y un ejercicio de gamberrismo parlamentario", así ha definido este miércoles el... |
 Europa Press Europa Press | 3h | |
|
|
|
 | Sánchez dice que la moción es un "fraude constitucional" |
| El presidente del Gobierno, Pedro Sánchez, ha calificado hoy de "fraude constitucional" la moción de... |
 Europa Press Europa Press | 3h | |
|
|
|
 | 'Utter folly': The Liberal party's 'drift to the Left' is their downfall |
| If the Coalition government falls in the upcoming NSW state election, "there will not be one" Liberal... |
 SkyNewsAustralia SkyNewsAustralia | 3h | |
|
|
|
 | 'Let me start this over again': Biden stumbles over poem |
| US President Joe Biden has stumbled over a poem excerpt while reading from a teleprompter, says Sky News... |
 SkyNewsAustralia SkyNewsAustralia | 3h | |
|
|
|
 | 'They need a Voice': Indigenous 'No' campaigners 'undermine their own argument' |
| No campaigners have "undermined their own argument" as they "complain" Indigenous people opposed to the... |
 SkyNewsAustralia SkyNewsAustralia | 3h | |
|
|
|
 | 'We can't afford to stall and go backwards under Labor': Perrottet delivers final... |
| NSW Premier Dominic Perrottet gave his final pitch to voters at the Sky News People's forum saying the... |
 SkyNewsAustralia SkyNewsAustralia | 3h | |
|
|
|
 | 'Shocking': Linda Burney fails to meet with Indigenous delegates in Canberra |
| The idea that Indigenous Australians Minister Linda Burney failed to meet with Aboriginal delegates who... |
 SkyNewsAustralia SkyNewsAustralia | 3h | |
|
|
|
 | Global water crisis looming, UN says - BBC News |
| A United Nations report has warned of a looming global water crisis and an "imminent risk" of shortages... |
 BBC News BBC News | 3h | |
|
|
|
 | 'I kinda like it': DeSantis laughs at Trump's 'DeSanctimonious' nickname |
| In a new interview with Piers Morgan, Gov. Ron DeSantis, R-Fla., jokes about Donald Trump's nickname... |
| |
|
|
|
 | Watch All In With Chris Hayes Highlights: March 21 | MSNBC |
| Get the latest news and commentary from Chris Hayes weekdays at 8 p.m. ET on MSNBC. » Subscribe... |
| |
|
|
|
 | Grand jury could vote on possible Trump charges Wednesday |
| The Guardian's Hugo Lowell discusses what could happen Wednesday if a grand jury votes on an indictment.... |
| |
|
|
|
 | New police misogyny claims: Serving Humberside officer says problem at her force... |
| A woman working for Humberside Police has told Sky News that an officer would sift through victims' statements... |
 Sky News Sky News | 3h | |
|
|
|
 | Gwyneth Paltrow: US star 'slammed into fellow skier very hard before bolting' |
| Gwyneth Paltrow is being sued by a man who says the actress crashed into him while skiing, knocking him... |
 Sky News Sky News | 3h | |
|
|
|
 | Ukraine War: 'Ukraine is just the battle, there is a bigger war taking place in Europe'-... |
| Tobias Ellwood, the chair of the Defence Select Committee, discusses the importance of a Ukrainian victory... |
 Sky News Sky News | 3h | |
|
|
|
 | Former Prime Minster Boris Johnson has left his house to travel to the partygate... |
| Former Prime Minster Boris Johnson has left his house to travel to the partygate committee hearing this... |
 Sky News Sky News | 3h | |
|
|
|
 | Road rage driver knocks motorcyclist off bike after 50mph chase |
| The road rage episode was caught by the driver's own dashcam, although he initially lied to the police... |
 Sky News Sky News | 3h | |
|
|
|
 | Ski Accident Trial: Attorneys describe opposite stories to jury | Morning in America |
| Terry Sanderson claims that Gwyneth Paltrow was cruising down the slopes so recklessly that they violently... |
 NewsNation Now NewsNation Now | 3h | |
|
|
|
 | Trump's Tuesday prediction wrong, vote possible Wednesday | Morning in America |
| Tuesday has come and gone; the day that former President Donald Trump claimed he would be arrested on... |
 NewsNation Now NewsNation Now | 3h | |
|
|
|
 | What is SLED looking for in Stephen Smith's homicide investigation? | Early Morning |
| Bernarda Villalona says the family is hoping that someone will speak up with more information on Stephen... |
 NewsNation Now NewsNation Now | 3h | |
|
|
|
 | Florida aims to bolster National Guard with incentive program | Early Morning |
| Lawmakers in Florida are aiming to help the state's National Guard bring in more troops, part of a national... |
 NewsNation Now NewsNation Now | 3h | |
|
|
|
 | Rollerskating revival holds special significance for communities of color |
| For the Black community roller skating was not always an accessible outlet, however, decades later the... |
 NBC News NBC News | 3h | |
|
|
|
 | Российская элита превратилась в послушного китайского слугу | Марк Фейгин |
| С юристом Марком Фейгиным поговорили о продолжающихся переговорах России и Китая, поджоге партизанами... |
 Штаб Навального Штаб Навального | 3h | |
|
|
|
 | 79-year-old woman killed, 5 family members injured in North Side car crash |
| A 79-year-old woman was killed and several family members — including two children — were injured following... |
 WGN News WGN News | 3h | |
|
|
|
 | Cameroon Professor Finds Refuge at California University |
| A university professor threatened by separatist violence in Cameroon is now in Southern California, sharing... |
 VOA News VOA News | 3h | |
|
|
|
 | AKTUELLE LAGE: „Da entstehen Kessel, in denen die Ukrainer fast schon festsitzen"... |
| Aktuelle Lage im Ukraine-Krieg: „Da entstehen Kessel, in denen die Ukrainer fast schon festsitzen", sagt... |
| |
|
|
|
 | Poser: Nike will likely be able to get inventory in-line with expectations by the... |
| Williams Trading's Sam Poser breaks down Nike's earnings results. |
 CNBC Television CNBC Television | 3h | |
|
|
|
 | Girard: The market is priced in for a 25 bps rate increase by the Fed |
| Michelle Girard, Head of U.S. at NatWest Markets, discusses her expectations for the latest FOMC meeting. |
 CNBC Television CNBC Television | 3h | |
|
|
|
 | Stone: A pause in the Fed's rate hiking cycle would send the wrong signal to markets |
| The Glenview Trust Company CIO Bill Stone explains the Fed's impact on the markets. |
 CNBC Television CNBC Television | 3h | |
|
|
|
 | Lebanese police fire tear gas on protesters angry at economic woes | AFP |
| Lebanese security fores use tear gas to disperse retired army and security forces veterans demanding... |
| |
|
|
|
 | Live: Sunak faces Starmer in PMQs ahead of Boris Johnson Partygate inquiry |
| Watch live as Rishi Sunak and Keir Starmer face off in Prime Minister's Questions in the House of Commons... |
 The Independent The Independent | 3h | |
|
|
|
 | msnbcleanforward's YouTube Videos: Grand jury could vote on possible Trump charges... |
| ... |
 Trump News TV from Michael_Novakhov (10 sites) Trump News TV from Michael_Novakhov (10 sites) | 3h | |
|
|
|
 | FoxNewsChannel's YouTube Videos: Dick Van Dyke injured in Malibu car crash: report |
| ... |
 Trump News TV from Michael_Novakhov (10 sites) Trump News TV from Michael_Novakhov (10 sites) | 3h | |
|
|
|
 | msnbcleanforward's YouTube Videos: Watch The Beat With Ari Melber Highlights: March... |
| ... |
 Trump News TV from Michael_Novakhov (10 sites) Trump News TV from Michael_Novakhov (10 sites) | 3h | |
|
|
|
 | msnbcleanforward's YouTube Videos: Democrats see downside in Trump's NY case |
| ... |
 Trump News TV from Michael_Novakhov (10 sites) Trump News TV from Michael_Novakhov (10 sites) | 3h | |
|
|
|
 | FoxNewsChannel's YouTube Videos: 'WHERE ARE THE FACT-CHECKERS?: Comer demands Biden... |
| ... |
 Trump News TV from Michael_Novakhov (10 sites) Trump News TV from Michael_Novakhov (10 sites) | 3h | |
|
|
|
 | Taylor Swift dives into stage on US tour in planned show-stopper |
| Watch as Taylor Swift dives into the stage on her US tour in a planned show-stopper. Some members... |
 Sky News Sky News | 3h | |
|
|
|
 | Police officer shot as German authorities target the extreme-right Reichsbürger group... |
| Authorities in Germany have carried out a series of raids on locations linked to the so-called Reichsbürger... |
 DW (English) DW (English) | 3h | |
|
|
|
 | Why Israel keeps the bodies of Palestinians | Al Jazeera Newsfeed |
| For decades, Israel has withheld hundreds of Palestinian bodies, denying their loved ones the closure... |
 Al Jazeera English Al Jazeera English | 3h | |
|
|
|
 | Каждый четвёртый в мире не имеет доступа к безопасной питьевой воде |
| Проблемы с питьевой водой в основном испытывают развивающиеся страны и связаны они с быстрым ростом населения... |
 euronews (на русском) euronews (на русском) | 3h | |
|
|
|
 | Roads and farmland under water in storm-ravaged California I WION Shorts |
| Drone video from California showed roads and farmland underwater on March 21. Homes & vehicles could... |
| |
|
|
|
 | New Twitter Blue Tick Scam: Hackers Stealing Bank Passwords - How to Protect Yourself... |
| Twitter Blue Tick Scam: A new financial scam has been unearthed on Twitter which once again shows the... |
| |
|
|
|
 | Can Mbappe, Morata & De Bruyne be successful Captains? WION Sports |
| It is transition time in international football. Three major European heavyweights have named new captains... |
| |
|
|
|
 | Saudi Arabia and Iran restore relations: A chance at peace for Yemen? • FRANCE 24... |
| The two sides in Yemen's conflict have agreed to free nearly 900 people in a prisoner exchange. That... |
 FRANCE 24 English FRANCE 24 English | 3h | |
|
|
|
 | Libya in deadlock with no election in sight |
| Politicians in Libya have now been squabbling over the electoral process timeline for years. Our correspondent... |
 TRT World TRT World | 3h | |
|
|
|
 | Springsteen, Louis-Dreyfus among 22 honored by Biden |
| (22 Mar 2023) President Joe Biden welcomed a high-wattage collection of singers, authors, artists and... |
 Associated Press Associated Press | 3h | |
|
|
|
 | ShowBiz Minute: Paltrow, Springsteen, Fashion Trust Awards |
| (22 Mar 2023) Doctors expected to testify in Gwyneth Paltrow's ski trial; Springsteen, Kaling, Louis-Dreyfus... |
 Associated Press Associated Press | 3h | |
|
|
|
 | UK's Uranium Shells For Ukraine Tanks | Putin "Disinformation" Or "Weapons... |
| Russian President Vladimir Putin has warned that Moscow would be "forced to react" if the United Kingdom... |
| |
|
|
|
 | Rufián avisa a Tamames que "la sabiduría no está reñida con la miseria moral" |
| El portavoz de ERC en el Congreso, Gabriel Rufián, ha señalado al PP como ganador de la moción de censura... |
 Europa Press Europa Press | 3h | |
|
|
|
 | Los reproches de Tamames y las acusaciones entre PP y PSOE ponen el broche a la moción... |
| La segunda y última jornada de la moción de censura ha arrancado cargada de acusaciones, por parte del... |
 Europa Press Europa Press | 3h | |
|
|
|
 | 🔴 En vivo ViX: La Voz de la Mañana 7:00 A.M., 22 de marzo de 2023 |
| En @VIX ésta y más noticias 24 horas Noticias 24/7 en ViX: https://bit.ly/3LBhvTK #ViX en redes... |
 Univision Noticias Univision Noticias | 3h | |
|
|
|
 | Dick Van Dyke injured in Malibu car crash: report |
| Legendary actor, 97, involved in single-car crash. #FoxNews Subscribe to Fox News! https://bit.ly/2vaBUvAS... |
 Fox News Fox News | 3h | |
|
|
|
 | Trump indictment vote looms as grand jury reconvenes |
| Twenty-three grand jurors will reconvene Wednesday in Lower Manhattan, expected to vote on whether former... |
 PIX11 News PIX11 News | 3h | |
|
|
|
 | Clouds move in, but temps still pleasant in NY, NJ |
| High pressure will move offshore into the Atlantic on Wednesday as a front will work its way into the... |
 PIX11 News PIX11 News | 3h | |
|
|
|
 | Exiled Pakistani journalist Taha Siddiqui on his graphic novel 'Dissident Club' •... |
| Taha Siddiqui is an award-winning former FRANCE 24 journalist who fled #Pakistan after escaping a kidnapping... |
 FRANCE 24 English FRANCE 24 English | 3h | |
|
|
|
 | Libya's boxers recover from Kadhafi-era knockout • FRANCE 24 English |
| Libyan boxers fight and train in Tripoli, as they participate in various competitions following Libya's... |
 FRANCE 24 English FRANCE 24 English | 3h | |
|
|
|
 | France requisitions refinery workers as energy strikes continue • FRANCE 24 English |
| Several French refineries were still blocked from delivering products after two weeks of strikes, causing... |
 FRANCE 24 English FRANCE 24 English | 3h | |
|
|
|
 | Defiant Johnson faces UK parliament grilling over Covid 'Partygate' • FRANCE 24 English |
| Britain's former prime minister Boris Johnson re-enters the bear pit of parliamentary inquisition on... |
 FRANCE 24 English FRANCE 24 English | 3h | |
|
|
|
 | Uganda's parliament passes tough anti-LGBTQ bill • FRANCE 24 English |
| Uganda's parliament on Tuesday passed sweeping anti-gay legislation which proposes tough new penalties... |
 FRANCE 24 English FRANCE 24 English | 3h | |
|
|
|
 | Los Angeles schools shut as workers stage mass walkout • FRANCE 24 English |
| More than 500,000 children were shut out of lessons Tuesday as school workers in Los Angeles began a... |
 FRANCE 24 English FRANCE 24 English | 3h | |
|
|
|
 | АМЕРИКА |
| Ежедневная информационная программа. |
 Настоящее Время Настоящее Время | 3h | |
|
|
|
 | ВЕЧЕР |
| Самые интересные и важные события дня. |
 Настоящее Время Настоящее Время | 3h | |
|
|
|
 | ГЛАВНОЕ |
| Ежедневная информационная программа. |
 Настоящее Время Настоящее Время | 3h | |
|
|
|
 | Российские войска ударили по Запорожью | НОВОСТИ |
| Ракеты, выпущенные российской армией, попали в два многоэтажных дома. Часть зданий снесло. Произошел... |
 Настоящее Время Настоящее Время | 3h | |
|
|
|
 | LIVE: Top Stories and Breaking News on March 22 | CBS News Mornings |
| Get ahead on the latest news by streaming the most important national and global stories on CBS News... |
 CBS News CBS News | 3h | |
|
|
|
 | Indigenous 'No' campaigners 'tell the truth' about Voice to Parliament in Canberra |
| Indigenous Minister Linda Burney failed to meet with Indigenous Elders from the 'No' campaign in Canberra... |
 SkyNewsAustralia SkyNewsAustralia | 3h | |
|
|
|
 | Chris Minns had the 'edge' in the Sky News/The Daily Telegraph's People's Forum |
| NSW Opposition Leader Chris Minns had the "edge" in the Sky News/The Daily Telegraph's People's Forum,... |
 SkyNewsAustralia SkyNewsAustralia | 3h | |
|
|
|
 | 'Anything can happen': Minority government a 'recipe for chaos' |
| Former Liberal advisor David Gazard says a minority government is a "recipe for chaos" and urged people... |
 SkyNewsAustralia SkyNewsAustralia | 3h | |
|
|
|
 | Watch The Beat With Ari Melber Highlights: March 21 | MSNBC |
| Watch the top news stories and highlights from The Beat with Ari Melber, airing weeknights at 6 p.m.... |
| |
|
|
|
 | Democrats see downside in Trump's NY case |
| Axios' Alexi McCammond joins Way Too Early to discuss why Democrats see a downside in Trump's NY case.... |
| |
|
|
|
 | Trump is allegedly anticipating this element of possibly being arrested |
| New York Times reporter and CNN political contributor Maggie Haberman and CNN's Kaitlan Collins discuss... |
| |
|
|
|
 | Ждём удары по центрам принятия решений | Интервью @DailyTVEurope |
| Путин ворует Украинских детей. Бездействие США провоцирует Путина на расширение конфликта и использование... |
 borovonovodvo borovonovodvo | 3h | |
|
|
|
 | The fortune of Charles III | AFP |
| A few days before the visit of Charles III visit in France and in Germany, a videographic on his fortune.... |
| |
|
|
|
 | Young South Koreans push back on proposal to increase workweek cap |
| As a growing number of companies in the U.S. and Europe are moving toward a four-day workweek, the South... |
 NBC News NBC News | 3h | |
|
|
|
 | Певчий монастыря стал артиллеристом |
| До мобилизации этот мужчина служил певчим в Тихвинском Богородичном Успенском мужском монастыре. «Батюшка»... |
 Комсомольская Правда Комсомольская Правда | 3h | |
|
|
|
 | Лариса Латынина: Непобедимая гимнастка СССР |
| Почти 50 лет рекорд Ларисы Латыниной не могли побороть даже мужчины. 18 олимпийских наград, девять из... |
 Комсомольская Правда Комсомольская Правда | 3h | |
|
|
|
 | California prepares for major power outages Wednesday | Early Morning |
| Strong winds have caused a lot of damage across California leading to power outages. The weather system... |
 NewsNation Now NewsNation Now | 3h | |
|
|
|
 | Moscow visit 'new partnership between Russia and China': Xi Jinping | Early Morning |
| Miles Yu says Xi Jinping wants to be peacemaker in the Ukraine war, but he can't do that when he's in... |
 NewsNation Now NewsNation Now | 3h | |
|
|
|
 | 🎙 Честное слово с Александрой Филиппенко |
| Политолог-американист Александра Филиппенко сегодня у нас в гостях. В 17:00, как всегда, начинаем «Честное... |
 Штаб Навального Штаб Навального | 3h | |
|
|
|
 | UnivisionNoticias's YouTube Videos: 🔴 En vivo ViX: La Voz de la Mañana 7:00 A.M.,... |
| ... |
 Puerto Rico News Videos from Michael_Novakhov (20 sites) Puerto Rico News Videos from Michael_Novakhov (20 sites) | 3h | |
|
|
|
 | MESSERATTACKE MÜNSTER: 21-jähriger Tatverdächtiger stellt sich der Polizei | EILMELDUNG |
| MESSERATTACKE MÜNSTER: 21-jähriger Tatverdächtiger stellt sich der Polizei | EILMELDUNG Nach dem... |
| |
|
|
|
 | Fi's journey to understanding her anorexia and autism | Christine McGuinness: Unmasking... |
| Subscribe and 🔔 to the BBC 👉 https://bit.ly/BBCYouTubeSub Watch the BBC first on iPlayer 👉 https://bbc.in/iPlayer-Home... |
| |
|
|
|
 | Whale sinks boat in the Pacific |
| Four sailors say they're lucky to be alive after a whale struck their boat, leaving them stranded for... |
 ABC News ABC News | 3h | |
|
|
|
 | Gwyneth Paltrow on trial |
| The Oscar-winning actress is being sued for her alleged role in a ski crash that left a man with broken... |
 ABC News ABC News | 3h | |
|
|
|
 | The new Palestinian resistance groups in the Occupied West Bank | Al Jazeera World... |
| Is the occupied West Bank the new battleground in the Israeli-Palestinian conflict? Why has Palestinian... |
 Al Jazeera English Al Jazeera English | 3h | |
|
|
|
 | Russia's war on Ukraine benefits China by 'distracting' the West |
| "What we didn't see was any commitment, publicly at least, from China to provide Russia with weapons."... |
 Times Radio Times Radio | 3h | |
|
|
|
 | The Messed Up Truth About Cult Leader David Koresh |
| Self-proclaimed messiah and master manipulator David Koresh created a death cult, then made his prophecy... |
| |
|
|
|
 | Sofia Coppola's daughter says she tried to 'charter helicopter' on on her father's... |
| Sofia Coppola's teenage daughter has gone viral after posting a video about being grounded at home because... |
 The Independent The Independent | 3h | |
|
|
|
 | Road rage driver's dashcam captures him knocking motorcyclist off bike after 50mph... |
| Shocking dashcam footage filmed from a road rage driver's car shows the moment he knocked a motorcyclist... |
 The Independent The Independent | 3h | |
|
|
|
 | Moment deputies piled on top of Irvo Otieno before his death at psychiatric hospital |
| Video footage of the moments leading up to the death of Irvo Otieno, 28, has been released. It shows... |
 The Independent The Independent | 3h | |
|
|
|
 | Orlando Bloom sings Irish folk song at pub on St Patrick's Day |
| Orlando Bloom surprised fans on St Patrick's Day when he gave an impromptu performance of a traditional... |
 The Independent The Independent | 3h | |
|
|
|
 | Moment large tugboat sinks into Seattle Bay |
| Watch the moment a large tugboat sinks into Seattle Bay. Seattle Fire officials and Coast Guard... |
 The Independent The Independent | 3h | |
|
|
|
 | Canadian tourist board releases parody music video |
| A Canadian tourist board was forced to apologise after it released a parody music video which sexualised... |
 The Independent The Independent | 3h | |
|
|
|
 | Pensioner knocks over motorcyclist after 50mph chase in North Wales #shorts |
| Click here to subscribe to The Independent: https://bit.ly/Subscribe-to-Independent About The Independent:... |
 The Independent The Independent | 3h | |
|
|
|
 | Watch moment police chase and arrest murder suspect in Cobb County, Georgia |
| Police officers spotted a vehicle connected to a murder outside Miami and attempted a traffic stop, but... |
 Sky News Sky News | 3h | |
|
|
|
 | Watch live: Protests in Beirut continue after Lebanese pound hits new low |
| Protesters take to the street after the economic crisis deepens with the Lebanese pound briefly hitting... |
 Sky News Sky News | 3h | |
|
|
|
 | US man dies in custody after being held down by 10 people | Al Jazeera Newsfeed |
| Surveillance cameras filmed the final moments of a Black man who died after 10 police officers and medical... |
 Al Jazeera English Al Jazeera English | 3h | |
|
|
|
 | Russian Drone strikes |
| At least two civilians were injured and more are still trapped under buildings and rubbles in Russian... |
 Al Jazeera English Al Jazeera English | 3h | |
|
|
|
 | Protesters hurl cake and milkshake at Kosovo deputy PM |
| A cake and milkshake were thrown at Kosovo's Deputy Prime Minister Besnik Bislimi by Kosovo Social Democratic... |
 TRT World TRT World | 3h | |
|
|
|
 | Encore: Someone's Selling Human Bones on TikTok? | ICYMI Podcast |
| Today, we're revisiting one of our early favorite episodes from August 2021 about selling bones on TikTok.... |
 Slate Video Slate Video | 4h | |
|
|
|
 | Las peores tormentas de arena del año golpean varias áreas del norte de China |
| Pekín (China), 22 mar (EFE).- El Centro Meteorológico de China renovó hoy una alerta amarilla por las... |
 AGENCIA EFE AGENCIA EFE | 4h | |
|
|
|
 | El plan de la Xunta para renovables ampliará la evaluación ambiental para medir impacto... |
| La ley que tramitará la Xunta para crear una sociedad público-privada que pueda participar y promover... |
 Europa Press Europa Press | 4h | |
|
|
|
 | MTA seizes 20 cars in toll crackdown |
| Officials say these vehicles belong to drivers responsible for nearly $600,000 in unpaid tolls. |
 CBS New York CBS New York | 4h | |
|
|
|
 | 'WHERE ARE THE FACT-CHECKERS?: Comer demands Biden admit Chinese payouts |
| Rep. James Comer, R-Ky., joined 'Fox & Friends First' to discuss the GOP-led investigation into the... |
 Fox News Fox News | 4h | |
|
|
|
 | Qld government's housing fund has not 'delivered one roof over one head' |
| Queensland Opposition leader David Crisafulli says the state government continues to talk about its $2... |
 SkyNewsAustralia SkyNewsAustralia | 4h | |
|
|
|
 | NSW Opposition leader Chris Minns wins People's Forum debate |
| NSW Opposition leader Chris Minns has won the Sky News/The Daily Telegraph People's Forum in which he... |
 SkyNewsAustralia SkyNewsAustralia | 4h | |
|
|
|
 | 'Time for a fresh start': Chris Minns delivers final pitch for voters |
| Opposition leader Chris Minns has delivered his final pitch for voters at the Sky News / The Daily Telegraph... |
 SkyNewsAustralia SkyNewsAustralia | 4h | |
|
|
|
 | NSW government will continue to 'invest record amounts' in health |
| NSW Premier Dominic Perrottet says the government is "doing everything" it can to improve the health... |
 SkyNewsAustralia SkyNewsAustralia | 4h | |
|
|
|
 | Haven't Seen Equity Lows in This Cycle: Man Group CEO |
| Man Group Chief Executive Officer Luke Ellis believes "we have a big sell off somewhere in our near future"... |
 Bloomberg TV Markets and Finance Bloomberg TV Markets and Finance | 4h | |
|
|
|
 | Man Group CEO Ellis Says Banking Crisis Is Not Over Yet |
| Man Group Chief Executive Officer Luke Ellis sees "a significant number of banks that will not exist... |
 Bloomberg TV Markets and Finance Bloomberg TV Markets and Finance | 4h | |
|
|
|
 | Watch: Japanese baseball fans go wild after World Baseball Classic win |
| Baseball fans in Tokyo celebrated after Japan beat the United States 3-2 in the final of the 2023 World... |
 NBC News NBC News | 4h | |
|
|
|
 | Court appearance for woman accused in Pride flag burning |
| Police say Angelina Cando was seen on video setting the flag on fire outside Little Prince restaurant... |
 CBS New York CBS New York | 4h | |
|
|
|
 | First Alert Weather: Tracking rain tomorrow |
| CBS2's Elise Finch has the latest weather forecast. |
 CBS New York CBS New York | 4h | |
|
|
|
 | Trump investigation enters another day without arrest |
| New York City remains on high alert for protests in response to a possible indictment in the Manhattan... |
 CBS New York CBS New York | 4h | |
|
|
|
 | Suspect wanted in Sunset Park rape |
| Police say the man sexually assaulted a 49-year-old woman early Saturday morning in Brooklyn. |
 CBS New York CBS New York | 4h | |
|
|
|
 | Overnight fire rips through vacant buildings in the Bronx |
| A massive fire in the Bronx is now under control. Two buildings caught fire overnight in the Highbridge... |
 CBS New York CBS New York | 4h | |
|
|
|
 | Search for man who raped woman near Green-Wood Cemetery in Brooklyn |
| Police in Brooklyn are searching for a man who they say raped a woman near a cemetery. It happened... |
 Eyewitness News ABC7NY Eyewitness News ABC7NY | 4h | |
|
|
|
 | Fact-check: Did Paris requisition the military to clean up the capital's garbage-filled... |
| In Paris, as piles of garbage been rising so does fake news around the strike against the pension reform.... |
 euronews (in English) euronews (in English) | 4h | |
|
|
|
 | ❗️ НОВОСТИ | ОЧЕРЕДЬ ГРОБОВ В ПРИМОРЬЕ | УРАНОВЫЕ СНАРЯДЫ ДЛЯ УКРАИНЫ |
| 392 день войны ⚡️ Мэрия Новосибирска хочет размещать рекламу о призыве солдат в жилых домах, во Владивостоке... |
 Штаб Навального Штаб Навального | 4h | |
|
|
|
 | |
| Michael Novakhov retweeted: Today, Ukrainian Forces 🇺🇦 reported destroying... |
 Tweets by @mikenov Tweets by @mikenov | 4h | |
|
|
|
 | |
| Michael Novakhov retweeted: Обедненный уран - "стандартный компонент"... |
 Tweets by @mikenov Tweets by @mikenov | 4h | |
|
|
|
| |
| Michael Novakhov retweeted: An American woman working for U.S. intelligence... |
 Tweets by @mikenov Tweets by @mikenov | 4h | |
|
|
|
| |
| Michael Novakhov retweeted: The U.S. will send tanks to Ukraine far more... |
 Tweets by @mikenov Tweets by @mikenov | 4h | |
|
|
|
 | |
| Michael Novakhov retweeted: IT'S TIME FOR STRANGE SPY FACTS! HOOK-UPS... |
 Tweets by @mikenov Tweets by @mikenov | 4h | |
|
|
|
 | |
| Michael Novakhov retweeted: "Если Китай хочет играть конструктивную роль,... |
 Tweets by @mikenov Tweets by @mikenov | 4h | |
|
|
|
 | |
| Michael Novakhov retweeted: BREAKING: Japan will send military aid... |
 Tweets by @mikenov Tweets by @mikenov | 4h | |
|
|
|
| |
| Michael Novakhov retweeted: A New York Times investigation uncovered the... |
 Tweets by @mikenov Tweets by @mikenov | 4h | |
|
|
|
| |
| Michael Novakhov retweeted: The greatness of a nation isn't just measured... |
 Tweets by @mikenov Tweets by @mikenov | 4h | |
|
|
|
 | |
| Michael Novakhov retweeted: Former CIA officer Kristin Wood reveals the... |
 Tweets by @mikenov Tweets by @mikenov | 4h | |
|
|
|
 | |
| Michael Novakhov retweeted: 🇦🇿 Approximately 5,000 Russian soldiers serving... |
 Tweets by @mikenov Tweets by @mikenov | 4h | |
|
|
|
 | |
| Michael Novakhov retweeted: Webcam de #LaMolina - March 22, 2023 at 07:29AM... |
 Tweets by @mikenov Tweets by @mikenov | 4h | |
|
|
|
 | |
| Michael Novakhov retweeted: Премьер Японии пригласил Зеленского на G7.... |
 Tweets by @mikenov Tweets by @mikenov | 4h | |
|
|
|
 | |
| Michael Novakhov retweeted: On this day in 1622, unarmed Powhatan warriors... |
 Tweets by @mikenov Tweets by @mikenov | 4h | |
|
|
|
| |
| Michael Novakhov retweeted: The CIA doen't know how Putin rose to power... |
 Tweets by @mikenov Tweets by @mikenov | 4h | |
|
|
|
 | |
| China calls Xi's Russia visit one of friendship, peace | AP News apnews.com/article/china-… |
 Tweets by @mikenov Tweets by @mikenov | 4h | |
|
|
|
 | Trump indictment vote looms as grand jury reconvenes |
| Twenty-three grand jurors will reconvene Wednesday in Lower Manhattan, expected to vote on whether former... |
 PIX11 News PIX11 News | 4h | |
|
|
|
 | VORSICHT DEEP-FAKE: "Niemand steht über dem Gesetz" – Täuschend echte Bilder... |
| VORSICHT DEEP-FAKE: "Niemand steht über dem Gesetz" – Täuschend echte Bilder von Trumps Verhaftung .. |
| |
|
|
|
 | Virginia inmate 'smothering' case |
| Newly released video shows officers and hospital workers dragging and holding down Irvo Otieno for 12... |
 ABC News ABC News | 4h | |
|
|
|
 | Murdaugh-linked case deemed homicide |
| Authorities say the death of a teenager linked to the son of convicted double murderer Alex Murdaugh... |
 ABC News ABC News | 4h | |
|
|
|
 | bbcnews's YouTube Videos: More French anti-government protests over pension reforms... |
| ... |
 Trump News TV from Michael_Novakhov (10 sites) Trump News TV from Michael_Novakhov (10 sites) | 4h | |
|
|
|
 | BREAKING: Boris Johnson's future on the line as new partygate evidence is revealed |
| Boris Johnson's future is in the balance as he is set to give evidence to MPs investigating whether he... |
 Sky News Sky News | 4h | |
|
|
|
 | UK students face chaos as strikes hit universities | Latest English News |
| Universities in the UK have been hit by strike action once again, despite hopes of a breakthrough last... |
| |
|
|
|
 | NBA great Willis Reed dies at 80 I WION Shorts |
| Hall of Famer Willis Reed, the beloved former New York Knicks player died at the age of 80. The seven-time... |
| |
|
|
|
 | Donald Trump: Political witch-hunt against leading Republican candidate | Stormy... |
| Supporters of former President Donald Trump rallied near his Mar-a-Lago resort in Florida on Tuesday... |
| |
|
|
|
 | UK government's MIGRANT PLAN could cost £9bn in first three years | English News |
| The cost of the government's plan to clamp down on Channel migrant crossings could amount to more than... |
| |
|
|
|
 | France's Pension Reforms: Protests and strikes continues across France over pensions... |
| France's Pension Reforms: The British monarch and Queen Consort will be in the republic during a period... |
| |
|
|
|
 | Partygate EVIDENCE published as Boris Johnson prepares to face inquiry | Partygate... |
| Partygate Scandal: The Commons privileges committee has now published a bundle of evidence that Boris... |
| |
|
|
|
 | Блокада порта в Марселе. Макрон и профсоюзы готовятся к "чёрному четвергу" |
| Недовольные пенсионной реформой перекрыли автостраду возле Марселя, бастующие блокируют один из въездов... |
 euronews (на русском) euronews (на русском) | 4h | |
|
|
|
 | Quarter of global population lacks access to clean water |
| The UN says more than a quarter of the world's population lacks clean drinking water and almost half... |
 TRT World TRT World | 4h | |
|
|
|
 | NYC fire: Multi-alarm fire tears through homes in High Bridge section of Bronx |
| Flames quickly tore through the buildings on Ogden Avenue after breaking out just after 1:10 a.m. Janice... |
 Eyewitness News ABC7NY Eyewitness News ABC7NY | 4h | |
|
|
|
 | El Ibex 35 baja el 0,22 % tras la apertura pero mantiene los 9.000 puntos a la espera... |
| Madrid, 22 mar (EFE).- (Imágenes, edición y locución: Ana Bornay) El Ibex 35 abre este miércoles con... |
 AGENCIA EFE AGENCIA EFE | 4h | |
|
|
|
 | Detenido por traer a mujeres de Sudamérica y obligarlas después a ejercer la prostitución |
| Agentes de la Policía Nacional han detenido a un hombre que traía bajo engaños a mujeres de Sudamérica... |
 Europa Press Europa Press | 4h | |
|
|
|
 | Tamames da "un repaso" a los portavoces y les reprocha los gritos |
| El economista Ramón Tamames ha querido este miércoles "dar un repaso" a los portavoces de todos los grupos... |
 Europa Press Europa Press | 4h | |
|
|
|
 | Bendodo dice que el "escándalo del Tito Berni, no hay moción que lo tape" |
| El coordinador general del PP, Elías Bendodo, dice que el PSOE "es el pasado de este país" porque "ha... |
 Europa Press Europa Press | 4h | |
|
|
|
 | López al PP: "Ante cuestiones tan terribles no se puede mirar hacia otro lado" |
| El portavoz del Grupo Socialista en el Congreso, Patxi López, ha respondido a la portavoz del PP, Cuca... |
 Europa Press Europa Press | 4h | |
|
|
|
 | El padre del menor asesinado en (Lardero) La Rioja dice que se encuentran "como... |
| David, el padre de Álex, el menor asesinado en Lardero (La Rioja) en octubre de 2021, ha asegurado que... |
 Europa Press Europa Press | 4h | |
|
|
|
 | REPLAY: French President Emmanuel Macron talks about pensions reform • FRANCE 24... |
| French President Emmanuel Macron on Wednesday said a deeply unpopular new law that raises the retirement... |
 FRANCE 24 English FRANCE 24 English | 4h | |
|
|
|
 | «США разжигают, НАТО сошло с ума, Китай помирит РФ и Украину». Спор с представителем... |
| Зачем Си Цзиньпин приехал к Путину? Как Китай хочет остановить войну? Екатерина Котрикадзе обсуждает... |
 tvrainru tvrainru | 4h | |
|
|
|
 | Expenses will 'spiral out of control' under a Labor government |
| NSW Premier Dominic Perrottet claims NSW Opposition leader Chris Minns can't tell people how he will... |
 SkyNewsAustralia SkyNewsAustralia | 4h | |
|
|
|
 | Anti-corruption commissions shouldn't become 'kangaroo courts' |
| Sky News host Peta Credlin says it's a challenge for anti-corruptions commissions to get the balance... |
 SkyNewsAustralia SkyNewsAustralia | 4h | |
|
|
|
 | If Labor wins NSW election they'll be given 'the largest debt NSW has ever seen' |
| If Labor were to win the NSW election they would be handed "the largest debt NSW has ever seen", according... |
 SkyNewsAustralia SkyNewsAustralia | 4h | |
|
|
|
 | NSW government must address experienced people 'leaving' the health system |
| NSW Premier Dominic Perrottet needs to think about "who's leaving" the health system, says NSW Labor... |
 SkyNewsAustralia SkyNewsAustralia | 4h | |
|
|
|
 | NSW Liberals promise to convert 15,000 casual teachers into permanent teaching roles |
| NSW Premier Dominic Perrottet promises his party would convert 15,000 casual teachers into permanent... |
 SkyNewsAustralia SkyNewsAustralia | 4h | |
|
|
|
 | NSW Labor promising to build 100 preschools in New South Wales |
| NSW Opposition Leader Chris Minns is promising to build 100 preschools in New South Wales under an elected... |
 SkyNewsAustralia SkyNewsAustralia | 4h | |
|
|
|
 | NSW Labor's promises to rebate energy bills for small businesses |
| New South Wales Opposition leader Chris Minns discusses NSW Labor's promise to rebate on energy bills... |
 SkyNewsAustralia SkyNewsAustralia | 4h | |
|
|
|
 | Donald Trump set to 'turn himself in voluntarily' |
| Adam Creighton says rumours are for Donald Trump to "likely" be indicted on Wednesday in the US and the... |
 SkyNewsAustralia SkyNewsAustralia | 4h | |
|
|
|
 | NSW wage cap of three per cent for public servants 'fair and reasonable' |
| NSW Premier Dominic Perrottet says the wage cap of three per cent for the state's public servants is... |
 SkyNewsAustralia SkyNewsAustralia | 4h | |
|
|
|
 | Мария Ильюхина стала мамой |
| Актриса Мария Ильюхина – наша Маша из «Ворониных» – родила дочку! Поздравляем с пополнением в семье!... |
 Комсомольская Правда Комсомольская Правда | 4h | |
|
|
|
 | 🔴Владимир Путин вручает премии президента для молодых деятелей культуры: прямая трансляция |
| Президент России Владимир Путин вручает премии за создание талантливых произведений литературы и искусства,... |
 Комсомольская Правда Комсомольская Правда | 4h | |
|
|
|
 | Life After the Traffic Stop |
| What is it like to survive a violent police encounter? As the world processes the beating and death of... |
| |
|
|
|
 | Confidence is key 😂 #RedNoseDay #iPlayer #Ghosts |
| |
| |
|
|
|
 | LIVE: NBC News NOW - March 22 |
| NBC News NOW is live, reporting breaking news and developing stories in real time. We are on the scene,... |
 NBC News NBC News | 4h | |
|
|
|
 | URAN-MUNITION FÜR DIE UKRAINE: Putin-Sprecher: „Alle fletschen die Zähne, außer Russen... |
| URAN-MUNITION FÜR DIE UKRAINE: Putin-Sprecher Peskow: „Alle fletschen die Zähne, außer Russen und Chinesen".... |
| |
|
|
|
 | 🔴 PMQs Unpacked | Will Boris overshadow today's events? |
| Keir and Rishi face off. We have the analysis. --- Times Radio brings you the latest breaking... |
 Times Radio Times Radio | 4h | |
|
|
|
 | ВОЙНА. ДЕНЬ 392. РАССЛЕДОВАНИЕ CIT: РОССИЯ ВЕЗЕТ НА ФРОНТ ОЧЕНЬ СТАРЫЕ ТАНКИ/ УГРОЗЫ... |
| Поддержать канал и выход новых роликов: https://www.patreon.com/macknack CIT выяснили, что Россия... |
 MackNack MackNack | 4h | |
|
|
|
 | Suspected gunman wearing 'devil mask' tackled as he tries to enter strip club |
| Watch the moment an armed suspect wearing a 'devil mask' is tackled as he tries to enter a strip club.... |
 The Independent The Independent | 4h | |
|
|
|
 | Crowds gather outside Trump Tower ahead of possible indictment |
| Crowds have gathered outside Trump Tower in New York ahead of the possible indictment of the former president.... |
 The Independent The Independent | 4h | |
|
|
|
 | China's Xi Jinping tells Putin 'change is coming' as he departs Moscow |
| Footage shows the moment Xi Jinping told Vladimir Putin that "change is coming" as he departed Moscow.... |
 The Independent The Independent | 4h | |
|
|
|
 | BREAKING: Privileges Committee releases partygate evidence |
| MPs investigating Boris Johnson over partygate accusations have published a "core bundle" of evidence... |
 Sky News Sky News | 4h | |
|
|
|
 | Sky News Breakfast: Boris Johnson partygate inquiry |
| On Sky News Breakfast with Kay Burley: - Peter Bone, former deputy leader of the House of Commons says... |
 Sky News Sky News | 4h | |
|
|
|
 | Russia flies two strategic missile carriers over Sea of Japan I WION Shorts |
| The two of Russian Tu-95MS strategic missile carriers made a routine flight over the Sea of Japan. SU-30... |
| |
|
|
|
 | Israeli parliament repeals law banning FOUR West Bank SETTLEMENTS | Israel-Palestine... |
| The Israeli parliament on Tuesday decided to repeal a law banning four settlements in the occupied West... |
| |
|
|
|
 | Deadly earthquake rattles large parts of Afghanistan and Pakistan | DW News |
| The powerful 6.5 magnitude tremor struck in the Hindu Kush mountains and was felt across Central and... |
 DW (English) DW (English) | 4h | |
|
|
|
 | Кнессет отменил "план размежевания" на Западном берегу |
| Документ касается только поселений Ганим, Кадим, Санур и Хомеш на севере Западного берега, эвакуированных... |
 euronews (на русском) euronews (на русском) | 4h | |
|
|
|
 | ECB Ready to Act as Needed With 'Robust' Policy: Lagarde |
| European Central Bank President Christine Lagarde said there is "no trade-off between price stability... |
 Bloomberg TV Markets and Finance Bloomberg TV Markets and Finance | 4h | |
|
|
|
 | Balance of Power Full Show (03/21/2023) |
| On Bloomberg's "Balance of Power" on Tuesday March 21st 2023: Sen. Ben Cardin (D) Maryland on what changes... |
 Bloomberg TV Markets and Finance Bloomberg TV Markets and Finance | 4h | |
|
|
|
 | Mexico Central Bank Sees Need for 'Additional Monetary Effort' |
| Banco de Mexico Deputy Governor Irene Espinosa discusses the possibility of another interest-rate hike... |
 Bloomberg TV Markets and Finance Bloomberg TV Markets and Finance | 4h | |
|
|
|
 | Quarter of global population lacks access to clean water |
| The UN says more than a quarter of the world's population lacks clean drinking water and almost half... |
 TRT World TRT World | 5h | |
|
|
|
 | Deadly earthquake strikes Pakistan and Afghanistan |
| (22 Mar 2023) Deadly earthquake strikes Pakistan and Afghanistan Subscribe for more Breaking News:... |
 Associated Press Associated Press | 5h | |
|
|
|
 | De la Fuente comienza a inculcar su ideario al frente de la Roja |
| Las Rozas (Madrid), 21 mar (EFE).- Luis de la Fuente, nuevo seleccionador de España, comenzó a inculcar... |
 AGENCIA EFE AGENCIA EFE | 5h | |
|
|
|
 | Entrenamiento de Marruecos de cara al partido amistoso contra Brasil |
| Rabat (Marruecos), 21 mar (EFE).- (Imagen: Fatima Zohra Bouaziz).- La selección marroquí, semifinalista... |
 AGENCIA EFE AGENCIA EFE | 5h | |
|
|
|
 | Investors Fear Missing Next Rally |
| Missing even a few days of a market rally could reduce your returns by more than half, evidence shows.... |
 TicToc by Bloomberg TicToc by Bloomberg | 5h | |
|
|
|
 | War-torn Ukraine to receive first loan from IMF • FRANCE 24 English |
| The International Monetary Fund (#IMF) and #Kyiv have reached a staff-level agreement for a $15.6 billion... |
 FRANCE 24 English FRANCE 24 English | 5h | |
|
|
|
 | Israeli settlements: US and EU condemn 2005 legislation reversal |
| Israel's parliament has overturned part of a law that banned illegal settlements in the occupied West... |
 Al Jazeera English Al Jazeera English | 5h | |
|
|
|
 | Ex-UK PM Johnson faces 'Partygate' parliamentary grilling |
| More than 200,000 people in the United Kingdom have now died from COVID-19. And for the families left... |
 Al Jazeera English Al Jazeera English | 5h | |
|
|
|
 | NSW Libs want to do everything to put 'downward pressure' on household budgets |
| The Liberal government promises to do everything they can to put "downward pressure" on household budgets... |
 SkyNewsAustralia SkyNewsAustralia | 5h | |
|
|
|
 | 'Had enough': Privatisation has gone 'way too far' |
| NSW Opposition leader Chris Minns claims privatisation has gone "way too far" and the state has had enough.... |
 SkyNewsAustralia SkyNewsAustralia | 5h | |
|
|
|
 | The point of the NSW budget is to 'help families in difficult times': Perrottet |
| The point of the NSW budget is to "help families in difficult times" following the rate rises and increase... |
 SkyNewsAustralia SkyNewsAustralia | 5h | |
|
|
|
 | Infrastructure 'Labor will not be building' must continue for growing population |
| NSW Premier Dominic Perrottet says infrastructure "Labor will not be building" has to continue in order... |
 SkyNewsAustralia SkyNewsAustralia | 5h | |
|
|
|
 | Perrottet to offer one year of free preschool for NSW kids |
| New South Wales Premier Dominic Perrottet has announced one year of free preschool for children in addition... |
 SkyNewsAustralia SkyNewsAustralia | 5h | |
|
|
|
 | Labor will 'need bipartisan support' for Voice referendum to succeed |
| The Labor government will "need bipartisan support" in order for the Voice to Parliament referendum to... |
 SkyNewsAustralia SkyNewsAustralia | 5h | |
|
|
|
 | NSW Labor 'do not support' raising the Warragamba Dam wall |
| NSW Opposition Leader Chris Minns says Labor "do not support" raising the Warragamba Dam wall and condemned... |
 SkyNewsAustralia SkyNewsAustralia | 5h | |
|
|
|
 | Aboriginal people don't want the government to 'be divided by race' |
| Aboriginal people do not want the government to "be divided by race" with the Voice to Parliament, says... |
 SkyNewsAustralia SkyNewsAustralia | 5h | |
|
|
|
 | NSW govt 'decluttering' school curriculum and 'getting back to basics' |
| NSW Premier Dominic Perrottet says the state government is making sure schools "get back to basics" with... |
 SkyNewsAustralia SkyNewsAustralia | 5h | |
|
|
|
 | Government commits to 'do more' to improve NSW health system |
| NSW Premier Dominic Perrottet admits the government needs to "do more" to improve the state's health... |
 SkyNewsAustralia SkyNewsAustralia | 5h | |
|
|
|
 | NSW Labor to offer energy rebate for small businesses: Chris Minns |
| NSW Labor Leader Chris Minns has promised a $315 rebate on energy bills for small businesses as the state... |
 SkyNewsAustralia SkyNewsAustralia | 5h | |
|
|
|
 | SEK-Beamter bei Durchsuchung im "Reichsbürger"-Milieu angeschossen | EILMELDUNG |
| SEK-Beamter bei Durchsuchung im "Reichsbürger"-Milieu angeschossen | EILMELDUNG Bei einer Durchsuchung... |
| |
|
|
|
 | More French anti-government protests over pension reforms - BBC News |
| Protests have continued in several French cities after President Emmanuel Macron used executive powers... |
 BBC News BBC News | 5h | |
|
|
|
 | UnivisionNoticias's YouTube Videos: Ríos desbordados, árboles caídos y conductores... |
| ... |
 Puerto Rico News Videos from Michael_Novakhov (20 sites) Puerto Rico News Videos from Michael_Novakhov (20 sites) | 5h | |
|
|
|
 | Stormont brake could 'invite' more EU control |
| "I'm a government supporting MP who normally likes to obey the conservative whip. But I don't see how... |
 Times Radio Times Radio | 5h | |
|
|
|
 | Brazil evicts miners from Yanomami territory |
| Brazil has ousted almost all illegal gold miners from the Yanomami territory, its largest indigenous... |
 Reuters Reuters | 5h | |
|
|
|
 | Uganda passes a law making it a crime to identify as LGBTQ |
| Uganda's parliament passed a law making it a crime to identify as LGBTQ, handing authorities broad powers... |
 Reuters Reuters | 5h | |
|
|
|
 | Moment lorry crashes into police cars |
| New Jersey Department of Transport released dashcam footage of a lorry crashing into three New Jersey... |
 Sky News Sky News | 5h | |
|
|
|
 | Saudi Prince Mohammed bin Salman says, 'no more easy cash for Pak' as its economy... |
| Saudi Arabia Prince Mohammed bin Salman cuts off cash to Pakistan as economy teeters on edge. Years of... |
| |
|
|
|
 | Palestine: Israel continuing open battle against our people | Latest English News |
| The Israeli parliament on Tuesday decided to repeal a law banning four settlements in the occupied west... |
| |
|
|
|
 | Irene Montero pide al PSOE "soltar la mano" del PP |
| La ministra de Igualdad, Irene Montero, ha emplazado al PSOE a demostrar "con hechos" las palabras del... |
 Europa Press Europa Press | 5h | |
|
|
|
 | El Gobierno dice que Vox representa un "modelo agotado" |
| La ministra portavoz y de Política Territorial, Isabel Rodríguez, ha señalado que la moción de censura... |
 Europa Press Europa Press | 5h | |
|
|
|
 | PP cree que la moción convierte a Yolanda Díaz en la marca blanca de Sánchez |
| La portavoz del Grupo Popular en el Congreso, Cuca Gamarra, ha asegurado hoy que las mociones de censura,... |
 Europa Press Europa Press | 5h | |
|
|
|
 | Vox considera que la intervención de Tamames superó expectativas |
| El portavoz de Vox en el Congreso de los Diputados, Iván Espinosa de los Monteros, ha considerado positivamente... |
 Europa Press Europa Press | 5h | |
|
|
|
 | Russia Warns UK On Uranium Shells, "US Doesn't Want Ceasefire Right Now",... |
| Russia launched attacks against seven communities in Sumy Oblast on March 21, according to Ukraine. Kyiv... |
| |
|
|
|
 | LIVE: Rishi Sunak Faces MPs as Johnson Set to Vote Against Brexit Deal |
| LIVE: Rishi Sunak Faces MPs as Johnson Set to Vote Against Windsor Framework Prime Minister Rishi... |
| |
|
|
|
 | Boris Johnson Faces Privileges Committee: Did He Deliberately Mislead Parliament? |
| LIVE: Did Boris Johnson Lie About Partygate? As Boris Johnson tries to convince the privileges committee... |
| |
|
|
|
 | Daisy Jones and the Fictional Fleetwood Mac | Culture Gabfest Podcast |
| This week, Dana, Julia, and Stephen begin by talking about Daisy Jones & the Six. Then they discuss... |
 Slate Video Slate Video | 5h | |
|
|
|
 | Ríos desbordados, árboles caídos y conductores en peligro: el impacto de las tormentas... |
| Otro río atmosférico azotó este martes a California con intensas lluvias, fuertes vientos e inundaciones.... |
 Univision Noticias Univision Noticias | 5h | |
|
|
|
 | Dubai's traditional markets gear up for Ramadan | AFP |
| Dubai's old souqs are adorned with Ramadan decorations and lightings, as people shop for traditional... |
| |
|
|
|
 | NSW Liberals can provide cost-of-living relief due to 'strong financial management' |
| New South Wales Premier Dominic Perrottet says families across New South Wales are doing it "incredibly... |
 SkyNewsAustralia SkyNewsAustralia | 5h | |
|
|
|
 | Minns promises to convert 10,000 temporary teachers into permanent roles |
| New South Wales Opposition leader Chris Minns says a Labor government will convert 10,000 temporary teachers... |
 SkyNewsAustralia SkyNewsAustralia | 5h | |
|
|
|
 | NSW public hospital system in 'worse condition' than during the pandemic |
| NSW Opposition leader Chris Minns says he doesn't think there is "any doubt" the state's public hospital... |
 SkyNewsAustralia SkyNewsAustralia | 5h | |
|
|
|
 | $60 toll cap is a 'common sense' cost-of-living measure: Chris Minns |
| Labor's promise to provide a $60 toll cap per week for motorists is a "common sense" cost-of-living measure... |
 SkyNewsAustralia SkyNewsAustralia | 5h | |
|
|
|
 | NSW Coalition has a plan to 'grow the economy' and focus on infrastructure |
| NSW Premier Dominic Perrottet says his government has a plan to continue to grow the economy, create... |
 SkyNewsAustralia SkyNewsAustralia | 5h | |
|
|
|
 | NSW election begs 'two big' questions on privatisation and repair |
| NSW Labor Leader Chris Minns says the election comes down to "two big questions" – which party is going... |
 SkyNewsAustralia SkyNewsAustralia | 5h | |
|
|
|
 | Privatisation a 'big issue' for Chris Minns in NSW election |
| New South Wales Opposition leader Chris Minns says privatisation is a "big issue" this election campaign... |
 SkyNewsAustralia SkyNewsAustralia | 5h | |
|
|
|
 | Perrottet reassures 'no privatisation' with a re-elected Liberal government |
| New South Wales Premier Dominic Perrottet has reassured a re-elected Liberal government "will not be... |
 SkyNewsAustralia SkyNewsAustralia | 5h | |
|
|
|
 | LINKEN-CHEF "STINKSAUER": Sahra Wagenknecht meldet rund 750.000 Euro an... |
| LINKEN-CHEF "STINKSAUER": Sahra Wagenknecht meldet rund 750.000 Euro an Nebeneinkünften. Die Linken-Politikerin... |
| |
|
|
|
 | Could the Stormont Brake derail the Northern Ireland Protocol? |
| Northern Ireland's Democratic Unionist Party has said it will vote against the Stormont Brake mechanism... |
 euronews (in English) euronews (in English) | 5h | |
|
|
|
 | Greece to hold general election in May as government faces anger over train disaster |
| Greek Prime Minister Kyriakos Mitsotakis has called a general election for May following angry mass protests... |
 euronews (in English) euronews (in English) | 5h | |
|
|
|
 | Штурм позиций ВСУ |
| Боец штурмового отряда Воздушно-десантных войск показал бой за опорный пункт ВСУ #десантники #сво... |
 Комсомольская Правда Комсомольская Правда | 5h | |
|
|
|
 | Мы знаем, кто убивает Навального по приказу Путина | Руслан Шаведдинов |
| Команда Навального рассказала о людях, которые прямо сейчас пытают Алексея Навального в ИК-6 по приказу... |
 Штаб Навального Штаб Навального | 5h | |
|
|
|
 | This case against Trump is political: Rep. Jim Jordan |
| Rep. Jim Jordan, R-Ohio, discusses how the campaign to arrest former President Donald Trump is politically... |
 Fox News Fox News | 5h | |
|
|
|
 | No Trump arrest Tuesday after weekend claims, Fed expected to raise rates & more... |
| Subscribe to LiveNOW from FOX! https://www.youtube.com/livenowfox?sub_confirmation=1 Where to watch... |
 FOX 10 Phoenix FOX 10 Phoenix | 5h | |
|
|
|
 | Behind Putin's arrest warrant: Detention, deportation and torture of Ukrainians -... |
| Russia's President Vladimir Putin has become the first serving head of a major state to be subject to... |
 Ukraine crisis Ukraine crisis | 5h | |
|
|
|
 | US drone: The hidden world beneath the Black Sea - BBC News |
| Russia says it plans to retrieve the unmanned US drone downed over the Black Sea last Tuesday. The... |
 Ukraine crisis Ukraine crisis | 5h | |
|
|
|
 | Thick sandstorms shroud Beijing, air quality plummets |
| China's capital city of Beijing was hit by dense sandstorms that severely affected visibility, shrouding... |
 Reuters Reuters | 5h | |
|
|
|
 | Doctors deliver baby during earthquake |
| Doctors at a hospital in the Anantnag district of Jammu and Kashmir delivered a baby when a massive 6.6... |
| |
|
|
|
 | Tamames dice que la moción es buena oportunidad de debate |
| El candidato a la presidencia del Gobierno en la moción de censura al Gobierno de España presentada por... |
 Europa Press Europa Press | 5h | |
|
|
|
 | Al menos doce muertos y cientos de heridos por un terremoto en Afganistán y Pakistán |
| Al menos doce personas han fallecido tras un terremoto de magnitud 6,8 en la escala de Richter, que se... |
 Europa Press Europa Press | 5h | |
|
|
|
 | Markets in 3 Minutes: Can Fed Hike And Still Reassure Markets? |
| Mark Cudmore and Francine Lacqua break down today's key themes for analysts and investors on "Bloomberg... |
 Bloomberg TV Markets and Finance Bloomberg TV Markets and Finance | 5h | |
|
|
|
 | Daily Podcast: Misogyny, racism and homophobia – it's not just the Met police's problem |
| The Metropolitan Police is institutionally racist, misogynistic and homophobic, according to the independent... |
 Sky News Sky News | 6h | |
|
|
|
 | Partygate: Johnson has 'no regard for standards in public life'- Labour MP |
| Labour MP Steve Reed has described Boris Johnson as a man "who has absolutely no regard for standards... |
 Sky News Sky News | 6h | |
|
|
|
 | Police and Crime Committee explore scathing findings in Met Police with Baroness... |
| Susan Hall chairs a Police and Crime Committee meeting after a year-long review by Baroness Louise Casey... |
 Sky News Sky News | 6h | |
|
|
|
 | Why Is Adderall So Hard to Find? | What Next | Daily News and Analysis Podcast |
| Since last summer, it's been difficult to fill an Adderall prescription. The shortage is driving some... |
 Slate Video Slate Video | 6h | |
|
|
|
 | How Zach Braff's own struggle with grief inspired 'A Good Person' | Nightline |
| ABC News' Byron Pitts spoke to the actor and filmmaker about his new drama film starring Florence Pugh,... |
 ABC News ABC News | 6h | |
|
|
|
 | Japan PM 'feels horror of Russian aggression' on visit to Ukraine | AFP |
| Japan's Prime Minister Fumio Kishida on Tuesday made a surprise visit to Kyiv and Bucha, a town near... |
| |
|
|
|
 | Will Macron 'Macronsplain' his way out of pension reforms anger? • FRANCE 24 English |
| IN THE PRESS – Wednesday, March 22: The French papers look ahead to Emmanuel #Macron's live TV interview... |
 FRANCE 24 English FRANCE 24 English | 6h | |
|
|
|
 | Fox faces skeptical judge in Dominion defamation case |
| Lawyers for Fox News faced a skeptical judge as they sought to block a $1.6 billion defamation lawsuit... |
 Reuters Reuters | 6h | |
|
|
|
 | XI IN MOSKAU: „Das ist für Putin die wichtigste Botschaft, die er in die Welt senden... |
| „Das ist für Putin die wichtigste Botschaft, die er in die Welt senden kann". Putin und Xi demonstrieren... |
| |
|
|
|
 | Those 'opposed' to AUKUS are 'yesterday's heroes': Greg Sheridan |
| The Australian's Foreign Editor Greg Sheridan says those "who are opposed" to AUKUS are "yesterday's... |
 SkyNewsAustralia SkyNewsAustralia | 6h | |
|
|
|
 | 'Many' within Liberal party unhappy with Dutton's bipartisan deal with govt on Voice |
| There are "many" members within Peter Dutton's party who are unhappy with his bipartisan deal with the... |
 SkyNewsAustralia SkyNewsAustralia | 6h | |
|
|
|
 | 'Chaos': Palaszczuk government's rent caps proposal a 'policy on the run' |
| Queensland Opposition leader David Crisafulli says the state government thinks it can "throw anything... |
 SkyNewsAustralia SkyNewsAustralia | 6h | |
|
|
|
 | Ukraine: Three killed in drone attacks launched by Russia |
| At least two civilians were injured and more are still trapped under buildings and rubbles in Russian... |
 Al Jazeera English Al Jazeera English | 6h | |
|
|
|
 | ABC News's YouTube Videos: How Zach Braff's own struggle with grief inspired 'A Good... |
| ... |
 Trump News TV from Michael_Novakhov (10 sites) Trump News TV from Michael_Novakhov (10 sites) | 6h | |
|
|
|
 | Protesters and police clash in Paris as protest continues I WION Shorts |
| Protesters set off flares as police attempted to disperse them with tear gas in Paris on March 21. The... |
| |
|
|
|
 | WION Live Broadcast: WION Live News | World News | English News | International News... |
| WION Live Broadcast: WION Live News | World News | English News | International News | Live News ... |
| |
|
|
|
 | Dutch and Polish jets perform joint NATO air exercise | Polish MiG-29s & Dutch F-35s... |
| Polish and Dutch fighter jet pilots participated in a joint exercise on Tuesday (March 21) from the northern... |
| |
|
|
|
 | TikTok denies transferring data to China, CEO Shou Zi Chew says 'never shared users'... |
| TikTok denies data transfer: As a major global economies including United Kingdom and United States and... |
| |
|
|
|
 | Israel repeals 2005 law banning four West Banks settlements | English News |
| The Israeli parliament on Tuesday decided to repeal a law banning four settlements in the occupied west... |
| |
|
|
|
 | AP Top Stories March 22 a.m. |
| (22 Mar 2023) Here's the latest for Wednesday March 22nd: Chinese President Xi leaves Russia after Putin... |
 Associated Press Associated Press | 6h | |
|
|
|
 | IU Ciudad Real augura el fracaso del proceso de confluencia con Podemos |
| El candidato de IU a la Alcaldía de Ciudad Real, Ángel Aguas, ha vaticinado que el proceso de confluencia... |
 Europa Press Europa Press | 6h | |
|
|
|
 | UBS Offers to Buy Back 2.75 Billion Euros of Bonds |
| UBS is offering to buy back 2.75 billion euros ($2.96 billion) worth of bonds it issued Friday, just... |
 Bloomberg TV Markets and Finance Bloomberg TV Markets and Finance | 6h | |
|
|
|
 | UN says gang violence has killed at least 530 people this year |
| The UN says new clashes between gangs in Haiti's capital and beyond have killed at least 187 people in... |
 TRT World TRT World | 6h | |
|
|
|
 | Partygate: 'No evidence' Johnson misled Parliament over partygate- Tory MP |
| Peter Bone, former deputy leader of the House of Commons, said he doesn't believe Boris Johnson is fighting... |
 Sky News Sky News | 6h | |
|
|
|
 | Biden honors actors, artists, musicians at White House |
| Eminent actors, performers and authors were felicitated by US President Joe Biden at a ceremony in the... |
 Reuters Reuters | 6h | |
|
|
|
 | Los Angeles schools shut as workers go on three-day strike |
| Thousands of education workers went on a three-day strike in Los Angeles, canceling school for nearly... |
 Reuters Reuters | 6h | |
|
|
|
 | ROBERT HABECK WITTERT VERRAT: Koalitionsausschuss wird zum Ampel-Krisengipfel |
| HABECK WITTERT VERRAT: Koalitionsausschuss wird zum Ampel-Krisengipfel. In der Ampel flackern die Lichter... |
| |
|
|
|
 | Си Цзиньпина проводили с оркестром |
| Председатель КНР Си Цзиньпин завершил государственный визит в Россию. Это первый его вылет за пределы... |
 Комсомольская Правда Комсомольская Правда | 6h | |
|
|
|
 | 'Shame on everybody': Riot squad called to violent Sydney protest outside One Nation... |
| Sky News host James Morrow says cancel culture "cannot be allowed" on Australian shores after violence... |
 SkyNewsAustralia SkyNewsAustralia | 6h | |
|
|
|
 | 'A lot of pressure' to lift rates: RBA flags interest rate pause in April |
| The Australian's Washington Correspondent Adam Creighton discusses the Australia Reserve Bank flagging... |
 SkyNewsAustralia SkyNewsAustralia | 6h | |
|
|
|
 | Ron DeSantis attempting to 'differentiate himself' from Donald Trump |
| Former Labor MP Michael Danby says Ron DeSantis believes Donald Trump is being "unfairly prosecuted"... |
 SkyNewsAustralia SkyNewsAustralia | 6h | |
|
|
|
 | US media biased 'in favour of Democrats' as Trump's indictment overshadows Biden... |
| The Australian's Washington Correspondent Adam Creighton says "80 per cent of the media" in the US "is... |
 SkyNewsAustralia SkyNewsAustralia | 6h | |
|
|
|
 | 'We're not being listened to': NSW paramedics planning revolts |
| Paramedics across NSW are planning further industrial action to "disrupt" the government as they remain... |
 SkyNewsAustralia SkyNewsAustralia | 6h | |
|
|
|
 | Attempts to 'buck' the rental market will make a 'bad situation worse' |
| Any attempt to buck the rental market, as opposed to making it work better, by freeing up supply constraints... |
 SkyNewsAustralia SkyNewsAustralia | 6h | |
|
|
|
 | Tax deductibility agreement a step towards establishing a 'level playing field' for... |
| The Albanese government has finally agreed to provide tax deductibility on donations to organisations... |
 SkyNewsAustralia SkyNewsAustralia | 6h | |
|
|
|
 | 'Distressing': NSW regions lack access to specialist paramedics |
| There are a "multitude" of factors contributing to the "distressing" NSW ambulance shortage crisis as... |
 SkyNewsAustralia SkyNewsAustralia | 6h | |
|
|
|
 | 'Kean effect' hindering Dominic Perrottet's chances at re-election |
| The "Kean effect" might not be helping NSW Premier Dominic Perrottet ahead of the state election with... |
 SkyNewsAustralia SkyNewsAustralia | 6h | |
|
|
|
 | NSW paramedics 'fleeing' to other states as they remain lowest paid force in the... |
| NSW paramedics are "fleeing" to other states as they remain the lowest paid force in the country facing... |
 SkyNewsAustralia SkyNewsAustralia | 6h | |
|
|
|
 | 'Heartbreaking' toll on paramedics amid NSW shortage crisis |
| NSW ambulance shortages and prolonged waiting times have a "heartbreaking" and "distressing" toll on... |
 SkyNewsAustralia SkyNewsAustralia | 6h | |
|
|
|
 | What's the biggest threat — China, Russia or climate change? | Americans Weigh In |
| People in Texas identify the biggest threat: China, Russia, or climate change. #foxnews Subscribe... |
 Fox News Fox News | 6h | |
|
|
|
 | Стыдное обвинение «Мемориала» в реабилитации нацизма | Наталия Секретарева |
| В Москве силовики проводят обыски у бывших сотрудников международного «Мемориала» по делу о «реабилитации... |
 Штаб Навального Штаб Навального | 6h | |
|
|
|
 | FoxNewsChannel's YouTube Videos: Club For Growth President on what's next for the... |
| ... |
 Trump News TV from Michael_Novakhov (10 sites) Trump News TV from Michael_Novakhov (10 sites) | 6h | |
|
|
|
 | Russia's most lethal weapons in Ukraine: Tanks to hypersonic missiles | Russia-Ukraine... |
| Russia-Ukraine war live: Have a look at the new generations of weapons in which Russia says it is investing... |
| |
|
|
|
 | Modern weapons in use by the Zelensky's Ukraine against Russian invasion | Russia-Ukraine... |
| Ukrainian Military Arsenal Live: Have a look at military vehicles and equipment used by the Ukrainian... |
| |
|
|
|
 | Ramadan 2023: What makes Iftar food special, straight from Jama Masjid in Indian... |
| The holy month of Ramadan is one of fasting and solemn prayers for Muslims across the world. During this... |
| |
|
|
|
 | India: Police search for separatist preacher sparks tension | DW News |
| Authorities in India extended a mobile internet blackout across the northern state of Punjab as police... |
 DW (English) DW (English) | 6h | |
|
|
|
 | В Греции пройдут досрочные выборы, Мицотакис и его партия теряют популярность |
| Досрочные парламентские выборы в Греции пройдут в мае. Судя по опросам, правящая партия "Новая демократия"... |
 euronews (на русском) euronews (на русском) | 6h | |
|
|
|
 | Watch again: View from Tokyo as cherry blossom trees are in full bloom |
| View from Tokyo as cherry blossom trees are in full bloom. Watch more from Independent TV: https://www.independent.co.uk/tv/editors-picks... |
 The Independent The Independent | 6h | |
|
|
|
 | Anger Over Greek Train Accident Shows No Signs Of Slowing |
| In Greece, a victim of the Feb 28 deadly train collision near the town of Tempi has filed a criminal... |
 TRT World TRT World | 7h | |
|
|
|
 | 6.5-magnitude earthquake shakes building in Pakistan |
| Subscribe: http://trt.world/subscribe Livestream: http://trt.world/ytlive Facebook: http://trt.world/facebook... |
 TRT World TRT World | 7h | |
|
|
|
 | Agreement to form transitional government | World of Africa |
| Three months after Sudan's military leaders and the country's main pro-democracy group struck a deal... |
| |
|
|
|
 | Anti-government protests in four nations | World of Africa |
| Countries in the four cardinal points of Africa witnessed many ruckuses on March 20th. Angry citizens... |
| |
|
|
|
 | Salon in Nairobi for Cancer patients | World Of Africa |
| Cancer patients undergoing Chemotherapy often lose their hair as a side effect of the treatment. A beautician... |
| |
|
|
|
 | Xi Jinping & Vladimir Putin agree to advance Russia-China strategic cooperation |... |
| Russian President Vladimir Putin said that China's Ukraine "peace plan" could be discussed and that Moscow... |
| |
|
|
|
 | Inflation in Nigeria nears 18-year high | World of Africa |
| Nigerian inflation quickened at its fastest pace in almost 18 years, placing pressure on the central... |
| |
|
|
|
 | Sport recovers from Gaddafi-era knockout | World of Africa |
| Libyan boxers nowadays fight and train in Tripoli. The sport was banned by former dictator Muammar Gaddafi... |
| |
|
|
|
 | Gwyneth Paltrow's lawyer brands ski hit-and-run accusations 'utter BS' |
| American actress Gwyneth Paltrow appeared in court in Utah on Tuesday for the start of a civil trial... |
 euronews (in English) euronews (in English) | 7h | |
|
|
|
 | Всемирный день водных ресурсов. Круглый стол |
| Эксперты обсудят вопросы достижения устойчивого развития в тесном сотрудничестве между государственным... |
 Комсомольская Правда Комсомольская Правда | 7h | |
|
|
|
 | 13 dead after earthquake hits Afghanistan, Pakistan |
| A magnitude 6.5 earthquake hits Afghanistan and northern Pakistan, and tremors are felt as far away as... |
 Al Jazeera English Al Jazeera English | 7h | |
|
|
|
 | Australian banks have 'simplified' their approach to business risk management |
| Most Australian banks have "simplified" their businesses in order to increase control of risks, says... |
 SkyNewsAustralia SkyNewsAustralia | 7h | |
|
|
|
 | Reserve Bank building in Sydney to remove asbestos in extensive renovations |
| Business Now understands the renovation of the Reserve Bank building in Sydney will remove hazardous... |
 SkyNewsAustralia SkyNewsAustralia | 7h | |
|
|
|
 | GameStop surprises with profit increase |
| GameStop has reported its net profit for the fourth quarter, revealing it has lifted itself from a $146... |
 SkyNewsAustralia SkyNewsAustralia | 7h | |
|
|
|
 | People want 'assurance' Australia wouldn't 'plunge' into a war between US and China |
| Former foreign minister Bob Carr says many people would want assurance that Australia wouldn't "plunge"... |
 SkyNewsAustralia SkyNewsAustralia | 7h | |
|
|
|
 | Albanese will not let 'small hurdles get in the way' of legislating the Voice |
| Prime Minister Anthony Albanese will not let "small hurdles get in the way" of legislating the Voice... |
 SkyNewsAustralia SkyNewsAustralia | 7h | |
|
|
|
 | Macron to give TV interview in bid to calm unrest over pension reform |
| French President Emmanuel Macron has been keeping a low profile for the last few days but has told allies... |
 euronews (in English) euronews (in English) | 7h | |
|
|
|
 | France hit by fresh violence |
| Violence continued in several cities across France, as part of a wave of demonstrations over the government's... |
 Sky News Sky News | 7h | |
|
|
|
 | BREAKING: Inflation takes surprise leap to 10.4% with record food costs to blame |
| The rate of inflation has taken a surprise leap, driven by record food costs. The Office for National... |
 Sky News Sky News | 7h | |
|
|
|
 | Xi tells Putin of 'changes not seen for 100 years' | Al Jazeera Newsfeed |
| Leaving a state reception at the Kremlin, Chinese President Xi Jinping was heard telling Russia's president... |
 Al Jazeera English Al Jazeera English | 7h | |
|
|
|
 | Ukraine wine producers enjoy unexpected boost amid war |
| The fighting in Ukraine has made many residents turn to home-grown products. As a result, the... |
 Al Jazeera English Al Jazeera English | 7h | |
|
|
|
 | Russia-China relations: Xi & Putin call for 'responsible dialogue' |
| China's President Xi Jinping has said he signed an agreement with his Russian counterpart Vladimir Putin... |
 Al Jazeera English Al Jazeera English | 7h | |
|
|
|
 | Continúa el debate de la moción de censura en el Congreso de los Diputados |
| Continúa el debate de la moción de censura en el pleno del Congreso de los Diputadosal Gobierno presidido... |
 Europa Press Europa Press | 7h | |
|
|
|
 | Землетрясние в Афганистане: жертвы и разрушения во всём регионе… |
| Землетрясение магнитудой 6,5, которое продолжалось около 30 секунд, унесло жизни по меньшей мере 13 человек.... |
 euronews (на русском) euronews (на русском) | 7h | |
|
|
|
 | Club For Growth President on what's next for the conservative movement | Ben Domenech... |
| For more of The Ben Domenech Podcast: https://bit.ly/3SoYZkE Follow Ben on Twitter: @BDomenech ... |
 Fox News Fox News | 7h | |
|
|
|
 | Live: British politicians give news conference in Taiwan |
| News conference by visiting British lawmakers to Taiwan, hosted by Taiwan Foreign Ministry. Source:... |
 The Independent The Independent | 7h | |
|
|
|
 | Live: Amphibious Assault Ship USS Makin Island arrives in South Korea |
| Amphibious Assault Ship USS Makin Island arrives in South Korea to join large-scale Ssangyong amphibious... |
 The Independent The Independent | 7h | |
|
|
|
 | Will Donald Trump be arrested? Barricades set up near Trump tower | English News... |
| Supporters of former President Donald Trump rallied near his Mar-a-Lago resort in Florida on Tuesday... |
| |
|
|
|
 | ENERGIE: "Versorgungssicherheit, wie das in dem Papier behauptet wird, ist alles... |
| Bundeswirtschaftsminister Robert Habeck ist mittlerweile bereit, bei seinen umstrittenen Plänen zum Heizungsaustausch... |
| |
|
|
|
 | DR Congo sexual violence: Survivors find support from each other |
| Charities working in displacement camps in the Democratic Republic of the Congo say they have been treating... |
 Al Jazeera English Al Jazeera English | 7h | |
|
|
|
 | 'Uncharted territory': South Sudan's four years of flooding | AFP |
| For the last four years, unprecedented flooding linked to climate change has turned almost two-thirds... |
| |
|
|
|
 | Tourists celebrate spring equinox in Mexico's Teotihuacan | AFP |
| From the air in hot-air balloons or at the bottom of the pyramids of Teotihuacan, Mexican and foreigner... |
| |
|
|
|
 | At least 13 people dead after earthquake rocks Pakistan and Afghanistan |
| A magnitude 6.5 earthquake was felt across huge swathes of Afghanistan, Pakistan, and parts of India... |
 euronews (in English) euronews (in English) | 7h | |
|
|
|
 | Latest news bulletin | March 22nd – Morning |
| Catch up with the most important stories from around Europe and beyond - latest news, breaking news,... |
 euronews (in English) euronews (in English) | 7h | |
|
|
|
 | 'In crisis': NSW health system needs to be fixed 'as a priority' |
| No one blames NSW Premier Dominic Perrottet for doing whatever he could to help his wife when she needed... |
 SkyNewsAustralia SkyNewsAustralia | 7h | |
|
|
|
 | TikTok CEO defends app from ban in USA |
| TikTok CEO Shou Zi Chew has made a new TikTok video defending the app after calls were made to have it... |
 SkyNewsAustralia SkyNewsAustralia | 7h | |
|
|
|
 | Financial distress will be seen 'outside' the banking system |
| The financial distress seen in the months ahead is going to be outside of the banking system, independent... |
 SkyNewsAustralia SkyNewsAustralia | 7h | |
|
|
|
 | Donald Trump's arrest would show 'how totally corrupt the deep state is': Nigel Farage |
| Former United States president Donald Trump could face charges against him over a $US130,000 hush money... |
 SkyNewsAustralia SkyNewsAustralia | 7h | |
|
|
|
 | New police misogyny claims: Serving Humberside officer says problem at her force... |
| A woman working for Humberside Police has told Sky News that an officer would sift through victims' statements... |
 Sky News Sky News | 7h | |
|
|
|
 | Для россиян закрыли берег Валдая с домами Путина |
| Часть берега Валдая (и даже самого озера) полностью закрыли для россиян из-за «ухудшения экологического... |
 Штаб Навального Штаб Навального | 7h | |
|
|
|
 | 'Has The President Formed An Opinion' On COVID Origins & Lab Leak Theory?: Biden... |
| During Tuesday's White House Press Briefing, Admiral John Kirby spoke about President Biden declassifying... |
 Forbes Under 30 Forbes Under 30 | 7h | |
|
|
|
 | Пилот F-16: «Вы можете на меня рассчитывать» |
| Подполковник ВВС США в отставке Дэн Хэмптон совершил сотни полетов на истребителях F-16. В интервью Украинской... |
 Голос Америки Голос Америки | 7h | |
|
|
|
 | Macron's under fire for governmental deficiencies and pension reforms • FRANCE 24... |
| Macron is under mounting criticism for governmental deficiencies and controversial pension reforms. He... |
 FRANCE 24 English FRANCE 24 English | 7h | |
|
|
|
 | Russia and China issue joint statement: 'No winners in a nuclear war' | Vladimir... |
| Russia-China joint statement: Russian President Vladimir Putin said that China's Ukraine "peace plan"... |
| |
|
|
|
 | Fumio Kishida Takes a Stand: Japan Won't Accept Russian Intimidation | Latest English... |
| Japanese Prime Minister Fumio Kishida met with President Volodymyr Zelensky during his unannounced visit... |
| |
|
|
|
 | Nike beats quarterly earnings, STRONG DEMAND for sneakers boosts market shares |... |
| Nike is a brand we all are more or less likely familiar with and it has reported better than expected... |
| |
|
|
|
 | Microsoft wins dismissal of Activision case, judge dismisses claims on 'harm' | World... |
| Microsoft Activision Deal: There is relief for Microsoft in the Activision case, the US firm has won... |
| |
|
|
|
 | DEUTSCHE WÄLDER BEDROHT: "Ja, der Regen der letzten Zeit hilft uns. Aber er... |
| DEUTSCHE WÄLDER BEDROHT: "Ja, der Regen der letzten Zeit hilft uns. Aber er ist nicht die Rettung" .. |
| |
|
|
|
 | Новости дня | 22 марта — утренний выпуск |
| Узнавайте о самых важных событиях в Европе и за ее пределами - последние новости, срочные новости, мир,... |
 euronews (на русском) euronews (на русском) | 8h | |
|
|
|
 | US Federal Reserve to remind people they are 'focused on inflation' |
| Independent economist Warren Hogan says there will be a lot more "financial instability" in the coming... |
 SkyNewsAustralia SkyNewsAustralia | 8h | |
|
|
|
 | NSW government 'planning for the next generation' through infrastructure projects |
| NSW Metropolitan Roads and Women's Safety Minister Natalie Ward says the government is "planning for... |
 SkyNewsAustralia SkyNewsAustralia | 8h | |
|
|
|
 | FoxNewsChannel's YouTube Videos: Jesse Watters Primetime: Woman details shocking... |
| ... |
 Trump News TV from Michael_Novakhov (10 sites) Trump News TV from Michael_Novakhov (10 sites) | 8h | |
|
|
|
 | Xi Jinping invita a Vladimir Putin a visitar su país #Shorts | Noticias Telemundo |
| Short oficial de Noticias Telemundo. Además, los mandatarios firmarán acuerdos clave sobre el reforzamiento... |
 NOTICIAS TELEMUNDO NOTICIAS TELEMUNDO | 8h | |
|
|
|
 | No hay avances visibles para un cese al fuego en Ucrania #Shorts | Noticias Telemundo |
| Short oficial de Noticias Telemundo. Los mandatarios firmaron convenios de cooperación mutua que pueden... |
 NOTICIAS TELEMUNDO NOTICIAS TELEMUNDO | 8h | |
|
|
|
 | Estos hermanos latinos hacen historia en el March Madness #Shorts | Noticias Telemundo |
| Short oficial de Noticias Telemundo. Gabriela y Jaime Jáquez se han ganado los aplausos de fanáticos... |
 NOTICIAS TELEMUNDO NOTICIAS TELEMUNDO | 8h | |
|
|
|
 | Rachel Zegler praises 'trailblazers' Lucy Liu, Helen Mirren |
| (22 Mar 2023) Rachel Zegler praised her "Shazam! Fury of the Gods" co-stars Lucy Liu and Helen Mirren,... |
 Associated Press Associated Press | 8h | |
|
|
|
 | Syrian Kurds celebrate Newroz with song and dance |
| (22 Mar 2023) Hundreds of people celebrated Newroz, or the Kurdish new year, in northeast Syria on Tuesday.... |
 Associated Press Associated Press | 8h | |
|
|
|
 | Как Путин стал заложником Китая после ордера на арест |
| Си Цзиньпин приехал в Москву к Путину спустя пару дней после того, как Международный суд Гааги вынес... |
 tvrainru tvrainru | 8h | |
|
|
|
 | Selección marroquí se prepara para el amistoso del sábado contra Brasil |
| Rabat (Marruecos), 21 mar (EFE).- (Imagen: Fatima Zohra Bouaziz).- La selección marroquí, semifinalista... |
 AGENCIA EFE AGENCIA EFE | 8h | |
|
|
|
 | US & allies working to COUNTER China's influence; Beijing to redevelop Solomon Islands... |
| The Solomon Islands has awarded a Chinese state company a multi-million-dollar contract to upgrade an... |
| |
|
|
|
 | STÄDTEBUND RUFT ZUR STADTFLUCHT AUF: 1,3 Millionen Wohnungen auf dem Land stehen... |
| Wegen der Wohnungsnot in Metropolen ruft der Städte- und Gemeindebund auf verstärkt Wohnung in ländlichen... |
| |
|
|
|
 | Торговля надеждой. Расследование Би-би-си |
| Как офтальмологи из России и США продают надежду на невозможное. 📩 МЫ ЗАПУСТИЛИ EMAIL-РАССЫЛКУ.... |
 BBC Russian BBC Russian | 8h | |
|
|
|
 | Киев назвал китайский план нелогичным и предлагает свою формулу мира |
| Си Цзиньпин завершает визит в Россию и пока неизвестно собирается ли он посетить Киев. Последний раскритиковал... |
 euronews (на русском) euronews (на русском) | 8h | |
|
|
|
 | Киев назвал китайский план нелогичным и предлагает свою формулу мира |
| Си Цзиньпин завершает визит в Россию и пока неизвестно собирается ли он посетить Киев. Последний раскритиковал... |
 euronews (на русском) euronews (на русском) | 8h | |
|
|
|
 | Jesse Watters Primetime: Woman details shocking battle to remove squatter from her... |
| Darthula Young details her battle with a squatter on her property who moved in and changed the locks... |
 Fox News Fox News | 8h | |
|
|
|
 | Latitude finance admit hackers gained access to more data than revealed |
| The farewell lap for Latitude Finance CEO Ahmed Fahour is not going to plan after the company admitted... |
 SkyNewsAustralia SkyNewsAustralia | 8h | |
|
|
|
 | Government needs to 'work harder' to address concerns around AUKUS |
| Former foreign minister Bob Carr says the government will need to "work harder" to explain away concerns... |
 SkyNewsAustralia SkyNewsAustralia | 8h | |
|
|
|
 | Labor is 'doing what we can' to address cost of living crisis: Albanese |
| Prime Minister Anthony Albanese says the government is "doing what we can" to make a difference on the... |
 SkyNewsAustralia SkyNewsAustralia | 8h | |
|
|
|
 | US Treasury Secretary attempts to calm Americans as banking crisis looms over the... |
| US Treasury Secretary Janet Yellen is attempting to calm Americans as a banking crisis looms after the... |
 SkyNewsAustralia SkyNewsAustralia | 8h | |
|
|
|
 | 'No ideas, no alternatives, no credibility': Albanese bites back at Coalition |
| Prime Minister Anthony Albanese says the Coalition has 'no ideas, no alternatives, no credibility' after... |
 SkyNewsAustralia SkyNewsAustralia | 8h | |
|
|
|
 | Piers Morgan interviews Tennis Champion Martina Navratilova about dual cancer battle |
| Sky News Australia host Piers Morgan sits down with Tennis Champion Martina Navratilova to talk about... |
 SkyNewsAustralia SkyNewsAustralia | 8h | |
|
|
|
 | Labor MP who criticised AUKUS shares concerns over submarine deal |
| Labor MP Michelle Ananda-Rajah discusses her recently raised concerns about the trilateral pact at the... |
 SkyNewsAustralia SkyNewsAustralia | 8h | |
|
|
|
 | ASX 200 finished the day up on Wednesday |
| Sky News Business Reporter Edward Boyd says the ASX 200 finished the day up on Wednesday. |
 SkyNewsAustralia SkyNewsAustralia | 8h | |
|
|
|
 | Martina Navratilova becomes emotional over songs sent to her during cancer treatment |
| Tennis star Martina Navratilova recalls the "tear-jerker" songs sent from the tennis community that helped... |
 SkyNewsAustralia SkyNewsAustralia | 8h | |
|
|
|
 | Australia 'in trouble' as obesity becomes 'more common' |
| Iverson health research institute Professor John Dixon says Australia is "in trouble" as obesity is becoming... |
 SkyNewsAustralia SkyNewsAustralia | 8h | |
|
|
|
 | Liberal party addresses concerns on Western Sydney and cost of living |
| Penrith MP Stuart Ayres says the Liberal party plans to focus on Western Sydney and on "reducing the... |
 SkyNewsAustralia SkyNewsAustralia | 8h | |
|
|
|
 | ТВ-экстрасенсы предсказывают конец войны |
| За судьбу России взялись экстрасенсы и тарологи. Видимо, пропагандистам на федеральных каналах осталось... |
 Штаб Навального Штаб Навального | 8h | |
|
|
|
 | msnbcleanforward's YouTube Videos: President Biden presents award to 'Selina Meyer':... |
| ... |
 Trump News TV from Michael_Novakhov (10 sites) Trump News TV from Michael_Novakhov (10 sites) | 8h | |
|
|
|
 | Cool temperatures continue as rain dissipates |
| Expect cool temperatures as the rain goes away later this week. |
 CBS Los Angeles CBS Los Angeles | 8h | |
|
|
|
 | LAFD holds retirement ceremony for two K-9s |
| The Los Angeles Fire Department held a retirement ceremony for K-9s Blue and Veya. |
 CBS Los Angeles CBS Los Angeles | 8h | |
|
|
|
 | President Biden presents award to 'Selina Meyer': National Medal of Arts, Humanities... |
| President Biden presented awards to the delayed recipients of the 2021 National Humanities Medal and... |
| |
|
|
|
 | Секрет его молодости | #ньюйоркньюйорк |
| Как распорядиться свободным временем и старыми проездными на метро? Коренной житель Нью-Йорка Томас Маккейн... |
 Голос Америки Голос Америки | 8h | |
|
|
|
 | 'What Does The Government Think Of That?': Neil Gorsuch Questions Lawyer In Case... |
| On Tuesday, Justice Neil Gorsuch questioned a lawyer during oral arguments in Abitron Austria GmbH v.... |
 Forbes Under 30 Forbes Under 30 | 8h | |
|
|
|
 | UnivisionNoticias's YouTube Videos: "Un inri que va a colgar de su espalda": opinión... |
| ... |
 Puerto Rico News Videos from Michael_Novakhov (20 sites) Puerto Rico News Videos from Michael_Novakhov (20 sites) | 8h | |
|
|
|
 | Ramadan fasting rules: How do Muslims with chronic diseases manage their medications? |
| Ramadan calls on Muslims to fast from sunrise to sunset - but what about patients on diabetes drugs or... |
 euronews (in English) euronews (in English) | 8h | |
|
|
|
 | Шокирующие подробности взрыва ФСБ / Ну и новости! |
| 00:00 Ну и новости! 01:41 Ещё больше снарядов от ЕС 02:45 Лаврова опозорил обеднённый уран 04:13... |
 Stepan Nexta Stepan Nexta | 8h | |
|
|
|
 | Musical family forms 'Quarantined Quartet' |
| At the start of the Covid-19 pandemic, the Hochman family, who were quarantining together, decided to... |
 NBC News NBC News | 9h | |
|
|
|
 | Japan PM Fumio Kishida meets Zelensky; What Trump's arrest would look like? | Trending... |
| Here, we bring you the news that is trending across WION's social media platforms - Japanese Prime Minister... |
| |
|
|
|
 | Xi Jinping Affirms China's Commitment to UN: Is He More Influential than Putin |... |
| Xi Jinping reiterates China's adherence to UN; Is Xi more commanding than Putin? Here we bring you a... |
| |
|
|
|
 | SVB's financial bankruptcy leads to cash seizure conflict | WION Business Watch |
| Lawyers for the part of Silicon Valley Bank that has been put into bankruptcy protection accused US bank... |
| |
|
|
|
 | XI IN MOSKAU: Billig-Tankstelle Russland - Putin zunehmend Abhängig von China | WELT... |
| Xi in Moskau - Russland wird zur Billig-Tankstelle - Kriegspräsident Putin in zunehmender Abhängigkeit... |
| |
|
|
|
 | CHINA: Potentielle Gefahr! Simples Beispiel zeigt eindrucksvoll, warum die USA harten... |
| CHINA: Potentielle Gefahr! Simples Beispiel zeigt eindrucksvoll, warum die USA harten Kurs vermeiden... |
| |
|
|
|
 | Coffee-hooked Libyans brace for low-caffeine Ramadan days | AFP |
| As the Muslim fasting month of Ramadan approaches, people in Libya are preparing to go without coffee.... |
| |
|
|
|
 | "Un inri que va a colgar de su espalda": opinión ante golpe de la comunidad internacional... |
| Tras más de un año de la invasión a Ucrania, la Corte Penal Internacional (CPI) emitió orden de arresto... |
 Univision Noticias Univision Noticias | 9h | |
|
|
|
 | Real estate industry bodies slam government policies over rental crisis |
| Two NSW real estate industry bodies have slammed government policies over the state's rental crisis.... |
 SkyNewsAustralia SkyNewsAustralia | 9h | |
|
|
|
 | Labor's 'ambitious' plans to combat veteran homelessness |
| Veterans' Affairs Minister Matt Keogh considers homelessness a serious priority issue and has an "ambitious"... |
 SkyNewsAustralia SkyNewsAustralia | 9h | |
|
|
|
 | Perrottet must use People's Forum to shift 'momentum' his way |
| NSW Premier Dominic Perrottet will need to use the Sky News / The Daily Telegraph People's Forum to try... |
 SkyNewsAustralia SkyNewsAustralia | 9h | |
|
|
|
 | Labor 'steadfast' in its support for Treaty on the Non-Proliferation of Nuclear Weapons |
| Prime Minister Anthony Albanese says the government is "redoubling" its efforts to achieve a world free... |
 SkyNewsAustralia SkyNewsAustralia | 9h | |
|
|
|
 | 'All their fault': Prince Harry and Meghan Markle are now 'so badly regarded' |
| Royal author Angela Levin says Prince Harry and Meghan Markle are now so badly regarded and it's "all... |
 SkyNewsAustralia SkyNewsAustralia | 9h | |
|
|
|
 | 'Hopeless at delivery': Plibersek slams Coalitions environmental efforts |
| The Coalition has been targeted for its environmental efforts over the past nine years – they were "addicted... |
 SkyNewsAustralia SkyNewsAustralia | 9h | |
|
|
|
 | msnbcleanforward's YouTube Videos: Trump makes violent, racist signals available... |
| ... |
 Trump News TV from Michael_Novakhov (10 sites) Trump News TV from Michael_Novakhov (10 sites) | 9h | |
|
|
|
 | FoxNewsChannel's YouTube Videos: Kayleigh McEnany: Why is AOC outraged at Democrats? |
| ... |
 Trump News TV from Michael_Novakhov (10 sites) Trump News TV from Michael_Novakhov (10 sites) | 9h | |
|
|
|
 | msnbcleanforward's YouTube Videos: Trump prepares for possible indictment |
| ... |
 Trump News TV from Michael_Novakhov (10 sites) Trump News TV from Michael_Novakhov (10 sites) | 9h | |
|
|
|
 | msnbcleanforward's YouTube Videos: Why the GOP can't quit Trump no matter how much... |
| ... |
 Trump News TV from Michael_Novakhov (10 sites) Trump News TV from Michael_Novakhov (10 sites) | 9h | |
|
|
|
 | For Donald Trump, legal dominoes may not be finished falling |
| Susanne Craig, investigative reporter for the New York Times, and Rebecca Roiphe, former assistant D.A.... |
| |
|
|
|
 | Trump makes violent, racist signals available for right-wing followers |
| Alex Wagner looks at the suggestions in the language Donald Trump uses against the prosecutors investigating... |
| |
|
|
|
 | UnivisionNoticias's YouTube Videos: ¿Qué pasó? Llegó el martes y Donald Trump no... |
| ... |
 Puerto Rico News Videos from Michael_Novakhov (20 sites) Puerto Rico News Videos from Michael_Novakhov (20 sites) | 9h | |
|
|
|
 | UnivisionNoticias's YouTube Videos: Asistentes de vuelo insisten en que niños deben... |
| ... |
 Puerto Rico News Videos from Michael_Novakhov (20 sites) Puerto Rico News Videos from Michael_Novakhov (20 sites) | 9h | |
|
|
|
 | UnivisionNoticias's YouTube Videos: Más de 10,000 desapariciones ponen a Tamaulipas... |
| ... |
 Puerto Rico News Videos from Michael_Novakhov (20 sites) Puerto Rico News Videos from Michael_Novakhov (20 sites) | 9h | |
|
|
|
 | UnivisionNoticias's YouTube Videos: El reto que supone para los padres la huelga... |
| ... |
 Puerto Rico News Videos from Michael_Novakhov (20 sites) Puerto Rico News Videos from Michael_Novakhov (20 sites) | 9h | |
|
|
|
 | UnivisionNoticias's YouTube Videos: Un abogado explica la relación entre la campaña... |
| ... |
 Puerto Rico News Videos from Michael_Novakhov (20 sites) Puerto Rico News Videos from Michael_Novakhov (20 sites) | 9h | |
|
|
|
 | John Kirby Warns: Providing Lethal Aid To Russia Is Not In China's 'Best Interest' |
| During Tuesday's White House Press Briefing, Admiral John Kirby spoke about President Xi & Putin's... |
 Forbes Under 30 Forbes Under 30 | 9h | |
|
|
|
 | Sonia Sotomayor Asks Lawyer About Brief Citing Positive Outcome Of Student Debt Cancellation |
| In February, Justice Sonia Sotomayor questioned lawyers in Biden v. Nebraska, which would determine whether... |
 Forbes Under 30 Forbes Under 30 | 9h | |
|
|
|
 | Phoenix Police Box In And Gas Man Barricaded In Car | GLENDALE, AZ |
| 03.16.2023 | 9:20 PM Northern Ave & 56th Lane | GLENDALE Phoenix police were in a tactical... |
 LOUDLABS NEWS LOUDLABS NEWS | 9h | |
|
|
|
 | Grindr joins push to distribute free at-home HIV tests |
| Grindr, the world's most popular gay dating app, is working with the CDC and several other public health... |
 NBC News NBC News | 9h | |
|
|
|
 | IN DEN RUINEN VON TEOTIHUACAN: Mexikaner begrüßen den Frühling |
| IN DEN RUINEN VON TEOTIHUACAN: Mexikaner begrüßen den Frühling #mexiko #teotihuacan #fruehling ... |
| |
|
|
|
 | First Republic seeks new ways to escape losses | WION Business Watch |
| First Republic Bank's efforts to secure a capital infusion continued without success on Tuesday, as the... |
| |
|
|
|
 | Google releases bard program for collaboration with AI | WION Business Watch |
| Google said access to the artificial intelligence (AI) program would begin Tuesday (March 21) in the... |
| |
|
|
|
 | Uganda Anti-Gay Bill: Outlaws identifying as LGBTQ, imposes death penalty for gay... |
| Uganda Anti-Gay Bill: Uganda's parliament passed a law that criminalises identifying as LGBTQ. More than... |
| |
|
|
|
 | Authorities Ready to Support Asian Banks: Fitch Ratings |
| Jonathan Cornish, head of APAC bank ratings at Fitch Ratings, discusses the Asian banking system, the... |
 Bloomberg TV Markets and Finance Bloomberg TV Markets and Finance | 9h | |
|
|
|
 | Uganda's parliament passes tough anti-gay bill | AFP |
| Uganda's parliament on Tuesday passed a bill that proposes tough new penalties for same-sex relationships,... |
| |
|
|
|
 | В ЮАР предлагают добывать питьевую воду из кислотных стоков шахт |
| Предприниматели предлагают сложную систему отчистки дренажа рудников, чтобы обеспечить водой сотни тысяч... |
 euronews (на русском) euronews (на русском) | 9h | |
|
|
|
 | msnbcleanforward's YouTube Videos: Trump legal troubles cast shadow over GOP retreat |
| ... |
 Trump News TV from Michael_Novakhov (10 sites) Trump News TV from Michael_Novakhov (10 sites) | 9h | |
|
|
|
 | Kayleigh McEnany: Why is AOC outraged at Democrats? |
| 'Outnumbered' co-host Kayleigh McEnany sounds off on 'Jesse Watters Primetime,' says leftists are calling... |
 Fox News Fox News | 9h | |
|
|
|
 | 'Australians are benefitting' from the Albanese government's policies |
| Minister for Health and Aged Care Mark Butler says 'Australians right around the country are benefitting'... |
 SkyNewsAustralia SkyNewsAustralia | 9h | |
|
|
|
 | Labor will 'continue to take action' against cost of living crisis: Albanese |
| Prime Minister Anthony Albanese says that Labor will "continue to take action" to take pressure off the... |
 SkyNewsAustralia SkyNewsAustralia | 9h | |
|
|
|
 | 'Unacceptable': Housing Minister on rise of homelessness in people aged between 12... |
| Housing Minister Julie Collins says according to the 2021 census, 23 per cent of "all people" experiencing... |
 SkyNewsAustralia SkyNewsAustralia | 9h | |
|
|
|
 | Polling shows likely Labor victories in Goulburn and Leppington |
| Sky News Political Editor Andrew Clennell reveals new seat-by-seat polling which shows a large One Nation... |
 SkyNewsAustralia SkyNewsAustralia | 9h | |
|
|
|
 | Here are the chances for rain for the rest of the week |
| For the most part, the rain is expected to die down by Thursday and be almost completely gone by Saturday. |
 CBS Los Angeles CBS Los Angeles | 9h | |
|
|
|
 | Southern California faces 12th atmospheric river of the season |
| It's been storm after storm for the past few months in Southern California. Some are excited about the... |
 CBS Los Angeles CBS Los Angeles | 9h | |
|
|
|
 | FAA investigates close call at Hollywood Burbank Airport |
| The close call surrounds an incoming Southwest flight and an LAFD helicopter. |
 CBS Los Angeles CBS Los Angeles | 9h | |
|
|
|
 | Trump prepares for possible indictment |
| Special counsel Jack Smith says former President Trump misled his attorneys about classified documents... |
| |
|
|
|
 | Why the GOP can't quit Trump no matter how much of a disgrace he becomes |
| Stuart Stevens, former Republican consultant talks with Alex Wagner about the way in which Donald Trump... |
| |
|
|
|
 | Jornalero se salva tras ser secuestrado por cártel mexicano | Noticias Telemundo |
| Video oficial de Noticias Telemundo. Este joven de 21 años trabajaba en el tomate en Jalisco, cuando... |
 NOTICIAS TELEMUNDO NOTICIAS TELEMUNDO | 9h | |
|
|
|
 | ¿Uno de cada cuatro adultos tiene inseguridad alimentaria? | Noticias Telemundo |
| Video oficial de Noticias Telemundo. Según un estudio, una cuarta parte de la población adulta en EE.UU.... |
 NOTICIAS TELEMUNDO NOTICIAS TELEMUNDO | 9h | |
|
|
|
| Los CDC alertan sobre hongo peligroso en centros de salud | Noticias Telemundo |
| Video oficial de Noticias Telemundo. Según los Centros para el Control y Prevención de Enfermedades,... |
 NOTICIAS TELEMUNDO NOTICIAS TELEMUNDO | 9h | |
|
|
|
 | Как покупка швейцарского Credit Suisse банком UBS повлияет на мировой рынок и российских... |
| Швейцарский банк UBS купил за 3,2 млрд долларов своего бывшего конкурента, оказавшегося на грани дефолта... |
 DW (Russian) DW (Russian) | 9h | |
|
|
|
 | Irvo Otieno death: Ben Crump speaks with family after release of graphic video |... |
| A graphic video has been released showing the moment sheriff's deputies and workers at a Virginia mental... |
 FOX 10 Phoenix FOX 10 Phoenix | 9h | |
|
|
|
| Candida auris: What you should know about the fungus spreading in U.S. hospitals... |
| The potentially deadly fungus Candida auris or "C. auris" is spreading at an alarming rate in U.S. healthcare... |
 FOX 10 Phoenix FOX 10 Phoenix | 9h | |
|
|
|
 | Asian leaders on parallel visits to Kyiv and Moscow |
| (22 Mar 2023) Japanese Prime Minister Fumio Kishida made a surprise visit Tuesday to Kyiv, stealing some... |
 Associated Press Associated Press | 9h | |
|
|
|
 | A quarter of humanity lacks safe drinking water |
| (22 Mar 2023) Near Abidjan, Ivory Coast's port city and fast-growing economic hub, many communities live... |
 Associated Press Associated Press | 9h | |
|
|
|
 | Man Arrested After Setting Train Tracks On Fire | GLENDALE, AZ |
| 03.09.2023 | 8:30 PM Grand Ave & Missouri Ave | GLENDALE A DPS trooper was driving East on... |
 LOUDLABS NEWS LOUDLABS NEWS | 9h | |
|
|
|
 | Motorcycle Fatal | HOLLYWOOD, CA 3.9.23 |
| HOLLYWOOD, CALIFORNIA - Two vehicles ended up hitting a downed motorcycle rider on Hollywood Blvd just... |
 LOUDLABS NEWS LOUDLABS NEWS | 9h | |
|
|
|
 | Active shooter drill sparks fear and confusion at Michigan children's facility |
| Employees at a Michigan children's psychiatric facility thought their lives were in danger when they... |
| |
|
|
|
 | Horror moment tourist's bungee cord snaps |
| A tourist has survived after plunging 10 storeys when his bungee cord snapped. But the company's response... |
 news.com.au news.com.au | 10h | |
|
|
|
 | ¿Qué pasó? Llegó el martes y Donald Trump no fue arrestado como lo había anticipado... |
| El expresidente Donald Trump anunció el sábado en la plataforma Truth Social que este martes podría ser... |
 Univision Noticias Univision Noticias | 10h | |
|
|
|
 | Asistentes de vuelo insisten en que niños deben ir en asientos individuales para... |
| Debido a que es casi imposible que los padres sostengan a sus hijos en turbulencias severas, la Asociación... |
 Univision Noticias Univision Noticias | 10h | |
|
|
|
 | Más de 10,000 desapariciones ponen a Tamaulipas dentro de los estados más violentos... |
| De acuerdo con cifras del periódico El País, en el estado de Tamaulipas hay 11,680 personas desaparecidas.... |
 Univision Noticias Univision Noticias | 10h | |
|
|
|
 | El reto que supone para los padres la huelga en el distrito escolar de Los Ángeles |
| Si bien la mayoría de los padres de familia están de acuerdo con que los empleados del Distrito Escolar... |
 Univision Noticias Univision Noticias | 10h | |
|
|
|
 | msnbcleanforward's YouTube Videos: Rep. Schiff: House GOP wants 'immunity for their... |
| ... |
 Trump News TV from Michael_Novakhov (10 sites) Trump News TV from Michael_Novakhov (10 sites) | 10h | |
|
|
|
 | msnbcleanforward's YouTube Videos: Lawrence: Today's worst legal news for Trump didn't... |
| ... |
 Trump News TV from Michael_Novakhov (10 sites) Trump News TV from Michael_Novakhov (10 sites) | 10h | |
|
|
|
 | MidweekPolitics's YouTube Videos: Don Jr has manic episode over Trump arrest rumor |
| ... |
 Trump News TV from Michael_Novakhov (10 sites) Trump News TV from Michael_Novakhov (10 sites) | 10h | |
|
|
|
 | Most people 'will be delighted' if Harry and Meghan don't attend Charles' coronation |
| Royal author Angela Levin says most people in the UK will be delighted if Prince Harry and Meghan Markle... |
 SkyNewsAustralia SkyNewsAustralia | 10h | |
|
|
|
 | Tanya Plibersek criticises Coalition over Murray Darling Basin Plan |
| The government is "absolutely committed" to implementing the Murray Darling Basin Plan in full, says... |
 SkyNewsAustralia SkyNewsAustralia | 10h | |
|
|
|
 | Students can look forward to an 'exciting career' building nuclear-powered subs |
| As students pursue an education in technical trades or science, they can now look to a "really exciting... |
 SkyNewsAustralia SkyNewsAustralia | 10h | |
|
|
|
 | More than a 'quarter of a million' jobs created by new Labor govt: Albanese |
| Prime Minister Anthony Albanese says more than a "quarter of a million" jobs have been created under... |
 SkyNewsAustralia SkyNewsAustralia | 10h | |
|
|
|
 | Trump legal troubles cast shadow over GOP retreat |
| A Republican retreat in Florida was supposed to focus on policy, but now the party is yielding questions... |
| |
|
|
|
 | Rep. Schiff: House GOP wants 'immunity for their party leader' |
| Rep. Adam Schiff joins MSNBC's Lawrence O'Donnell to discuss how the Republican defense of Trump shows... |
| |
|
|
|
 | LAUSD worker prepare to continue three-day strike |
| More than 60,000 LAUSD workers and teachers began walking picket lines in the rain after reaching an... |
 CBS Los Angeles CBS Los Angeles | 10h | |
|
|
|
 | Rain floods streets near landslide site in Orange County |
| Galaxy Drive in Newport Beach was left flooded. This is also the street where a bluff-top home was red-tagged... |
 CBS Los Angeles CBS Los Angeles | 10h | |
|
|
|
 | Powerful winds push sheets of rain in snow-battered Crestline |
| Powerful winds pushed sheets of rain across the Crestline sky, putting even more pressure on trees that... |
 CBS Los Angeles CBS Los Angeles | 10h | |
|
|
|
 | Fallo a favor de joven que demandó a escuelas en Michigan | Noticias Telemundo |
| Video oficial de Noticias Telemundo. La acusación de Miguel Pérez contra los centros educativos de Sturgis... |
 NOTICIAS TELEMUNDO NOTICIAS TELEMUNDO | 10h | |
|
|
|
 | 'I Cannot Talk About Politics': Karine Jean-Pierre Dodges Question About 2024 DNC |
| During Tuesday's White House Press Briefing, Karine Jean-Pierre was asked about the Democratic Convention... |
 Forbes Under 30 Forbes Under 30 | 10h | |
|
|
|
 | Tommy Tuberville Calls To Make Daylight Saving Time Permanent |
| In Senate floor remarks, Sen. Tommy Tuberville (R-AL) argued to make Daylight Saving Time permanent.... |
 Forbes Under 30 Forbes Under 30 | 10h | |
|
|
|
 | UnivisionNoticias's YouTube Videos: Dos presos escapan de una cárcel utilizando un... |
| ... |
 Puerto Rico News Videos from Michael_Novakhov (20 sites) Puerto Rico News Videos from Michael_Novakhov (20 sites) | 10h | |
|
|
|
 | Пригожин против властей Горячего Ключа: конфликт вокруг самого большого кладбища... |
| Против захоронений вагнеровцев в станице Бакинская в Краснодарском Крае выступили местные власти. В ответ... |
 DW (Russian) DW (Russian) | 10h | |
|
|
|
 | US Moves to Repeal Iraq War Authorization Act and Reclaim War Powers | WION |
| US wants its war powers back, advances bill to repeal Iraq war authorisation act. Twenty years after... |
| |
|
|
|
 | NATO troops face test of readiness; 2,000 troops take part in Slovak shield drills... |
| NATO troops are facing test of readiness in the multinational battle group military exercise which is... |
| |
|
|
|
 | Un abogado explica la relación entre la campaña presidencial de Trump y su posible... |
| En medio de la expectativa por el posible arresto del expresidente Donald Trump por un supuesto soborno... |
 Univision Noticias Univision Noticias | 10h | |
|
|
|
 | French pension reform: torchlight protest in Nantes | AFP |
| In Nantes, thousands march with torches to protest against the government's pension reform. Interested... |
| |
|
|
|
 | Georgia couple fights for release of five children taken by officials during traffic... |
| A Georgia couple is fighting officials for the return of their five children taken away after a traffic... |
| |
|
|
|
 | Stay Tuned NOW with Gadi Schwartz - March 21 | NBC News NOW |
| Los Angeles schools remain closed on the first day of the workers' strike, Donald Trump criticizes the... |
| |
|
|
|
 | Sri Lanka to get first tranche of $2.9bn bailout in two days: IMF |
| Sri Lanka will receive an almost $3bn bailout from the International Monetary Fund over the next four... |
 Al Jazeera English Al Jazeera English | 10h | |
|
|
|
 | US bank failures 'very different' from 2008 crisis, Yellen says |
| Stocks on Wall Street have climbed after the rescue of Credit Suisse calmed nerves about a larger banking... |
 Al Jazeera English Al Jazeera English | 10h | |
|
|
|
 | ABC News's YouTube Videos: Irvo Otieno's family on his death: 'We're living a nightmare... |
| ... |
 Trump News TV from Michael_Novakhov (10 sites) Trump News TV from Michael_Novakhov (10 sites) | 10h | |
|
|
|
 | msnbcleanforward's YouTube Videos: Mary Trump: Trump would likely surrender if charged... |
| ... |
 Trump News TV from Michael_Novakhov (10 sites) Trump News TV from Michael_Novakhov (10 sites) | 10h | |
|
|
|
 | ABC News's YouTube Videos: Mikaela Shiffrin : 'it's a lot of dedication. It's pretty... |
| ... |
 Trump News TV from Michael_Novakhov (10 sites) Trump News TV from Michael_Novakhov (10 sites) | 10h | |
|
|
|
 | ABC News's YouTube Videos: Renowned chef Kristen Kish new series: 'Food can bring... |
| ... |
 Trump News TV from Michael_Novakhov (10 sites) Trump News TV from Michael_Novakhov (10 sites) | 10h | |
|
|
|
 | AUKUS deal to 'shape and strengthen' Australia's economy for 'decades' |
| Prime Minister Anthony Albanese says the AUKUS deal will "shape and strengthen" Australia's economy for... |
 SkyNewsAustralia SkyNewsAustralia | 10h | |
|
|
|
 | Inflation had taken off 'before Labor took office': Anthony Albanese |
| Prime Minister Anthony Albanese says inflation had taken off "before Labor took office". Mr Albanese... |
 SkyNewsAustralia SkyNewsAustralia | 10h | |
|
|
|
 | Australia strengthens relationship with Samoa |
| Prime Minister Anthony Albanese welcomed Samoan Prime Minister Fiame Naomi Mataʻafa to Parliament House... |
 SkyNewsAustralia SkyNewsAustralia | 10h | |
|
|
|
 | Japan's prime minister meets Volodymyr Zelensky in Ukraine |
| Japanese Prime Minister Fumio Kishida has met Ukrainian President Volodymyr Zelensky in Kyiv. This... |
 SkyNewsAustralia SkyNewsAustralia | 10h | |
|
|
|
 | Consequences of safeguard mechanism reform not passing are 'very real' |
| Climate Change and Energy Minister Chris Bowen says the consequences of the safeguard mechanism reform... |
 SkyNewsAustralia SkyNewsAustralia | 10h | |
|
|
|
 | Parents play a 'critical role' in a developing child's resilience and coping skills |
| Triple P International Program Director Carol Markie-Dadds says parents play a "critical role" in supporting... |
 SkyNewsAustralia SkyNewsAustralia | 10h | |
|
|
|
 | Chris Minns will not 'do a deal with the Greens' |
| New South Wales Opposition leader Chris Minns says he is "not going to do a deal with the Greens" in... |
 SkyNewsAustralia SkyNewsAustralia | 10h | |
|
|
|
 | Highest inflation rise occurred on Liberal watch: Anthony Albanese |
| Prime Minister Anthony Albanese says the "highest increase" in inflation occurred on the Liberal party's... |
 SkyNewsAustralia SkyNewsAustralia | 10h | |
|
|
|
 | Boris Johnson denies 'deliberately' misleading parliament |
| Former UK prime minister Boris Johnson has admitted he misled parliament over his COVID-19 lockdown party... |
 SkyNewsAustralia SkyNewsAustralia | 10h | |
|
|
|
 | Fed Is Between a Rock and a Hard Place: HSBC's Neumann |
| Frederic Neumann, chief Asia economist at HSBC, discusses the upcoming Federal Reserve policy decision,... |
 Bloomberg TV Markets and Finance Bloomberg TV Markets and Finance | 10h | |
|
|
|
 | Lawrence: Today's worst legal news for Trump didn't happen in New York |
| MSNBC's Lawrence O'Donnell analyzes the latest developments in the many criminal investigations of former... |
| |
|
|
|
 | Mary Trump: Trump would likely surrender if charged because he's a 'coward' |
| Joining MSNBC's Lawrence O'Donnell, clinical psychologist Mary Trump discusses what she says is a disconnect... |
| |
|
|
|
 | 'Fox was supposed to have fixed that': Katie Phang on new lawsuit alleging hostile... |
| With many of Donald Trump's legal allegations coming to a head, we continue to track the $1.6 billion... |
| |
|
|
|
 | LAUSD parents, students cope with the ongoing strike |
| As over 60,000 workers and teachers rallied in picket lines, the parents of students in the Los Angeles... |
 CBS Los Angeles CBS Los Angeles | 10h | |
|
|
|
 | Tornado Warning issued for Southwestern LA County and Central Ventura County |
| The National Weather Service issued a Tornado Warning for Southwestern LA County and Central Ventura... |
 CBS Los Angeles CBS Los Angeles | 10h | |
|
|
|
 | Irvo Otieno's family on his death: 'We're living a nightmare and it's indescribable' |
| ABC News' Linsey Davis spoke with Otieno's brother Leon Ochieng and attorney Ben Crump on seeking justice... |
| |
|
|
|
 | Will Trump be indicted? Criticism, protests as grand jury considers case |
| Trump's potential indictment: Small groups are gathering outside the former president's Florida home... |
 NewsNation Now NewsNation Now | 10h | |
|
|
|
 | Removing death penalty is a 'slap in the face': JJ Vallow's grandparents | Banfield |
| The death penalty has been removed in the trial for Lori Vallow Daybell, the woman accused in a doomsday-focused... |
 NewsNation Now NewsNation Now | 10h | |
|
|
|
 | Wapa TV's YouTube Videos: EOPR quiere frenar adquisiciones de inversionistas del... |
| ... |
 Puerto Rico News Videos from Michael_Novakhov (20 sites) Puerto Rico News Videos from Michael_Novakhov (20 sites) | 10h | |
|
|
|
 | Wapa TV's YouTube Videos: Análisis de la demanda en contra de Bad Bunny por parte... |
| ... |
 Puerto Rico News Videos from Michael_Novakhov (20 sites) Puerto Rico News Videos from Michael_Novakhov (20 sites) | 10h | |
|
|
|
 | Cow returned to slaughterhouse after getting loose in Brooklyn |
| An escaped cow seen on video running through the streets of Brooklyn was caught on Tuesday. Sonia Rincon... |
 Eyewitness News ABC7NY Eyewitness News ABC7NY | 11h | |
|
|
|
 | COPA Peoples Academy aims to bridge gap between locals, Chicago police |
| The first class of the Civilian Office of Police Accountability's People's Academy, a free-to-public... |
| |
|
|
|
 | China plan could end war, but Ukraine and West not ready for peace, says Putin |... |
| Russian President Vladimir Putin said on Monday that China's Ukraine "peace plan" could be discussed... |
| |
|
|
|
 | Japanese PM meets Zelensky, pledges more aid to Ukraine |
| Japanese Prime Minister Fumio Kishida met with President Volodymyr Zelensky during his unannounced visit... |
| |
|
|
|
 | Dos presos escapan de una cárcel utilizando un cepillo de dientes para cavar un hoyo |
| Arley Remo y John Garza lograron escapar de la cárcel de Newport News, una instalación de seguridad mínima,... |
 Univision Noticias Univision Noticias | 11h | |
|
|
|
 | EOPR quiere frenar adquisiciones de inversionistas del exterior | LDSD | WapaTV |
| El director ejecutivo de El Otro Puerto Rico (EOPR), Alonso Ortíz Menchaca, explicó en qué consiste el... |
| |
|
|
|
 | Civil rights groups call for investigation into new Fort Hood death |
| There are growing calls for an independent investigation into the death of a female soldier inside Fort... |
| |
|
|
|
 | Don Jr has manic episode over Trump arrest rumor |
| -- Donald Trump Jr is shot out of a cannon in his latest podcast in response to the Trump arrest rumors... |
 David Pakman Show David Pakman Show | 11h | |
|
|
|
 | Gutfeld: 'Woke B.S.' is ruining our society |
| Fox News host Greg Gutfeld gives his take on whether more men are becoming 'woke' on 'Gutfeld!' #foxnews... |
| |
|
|
|
 | Live: View from Tokyo as cherry blossom trees are in full bloom |
| View from Tokyo as cherry blossom trees are in full bloom. Watch more from Independent TV: https://www.independent.co.uk/tv/editors-picks... |
 The Independent The Independent | 11h | |
|
|
|
 | msnbcleanforward's YouTube Videos: New video shows final moments of Irvo Otieno's... |
| ... |
 Trump News TV from Michael_Novakhov (10 sites) Trump News TV from Michael_Novakhov (10 sites) | 11h | |
|
|
|
 | FoxNewsChannel's YouTube Videos: Gutfeld: 'Woke B.S.' is ruining our society |
| ... |
 Trump News TV from Michael_Novakhov (10 sites) Trump News TV from Michael_Novakhov (10 sites) | 11h | |
|
|
|
 | 33 alleged gang members indicted in Queens takedown |
| Queens District Attorney Melinda Katz and NYPD Commissioner Keechant Sewell announced one of the largest... |
| |
|
|
|
 | 'Tranq' and fentanyl mixed to 'further addict' customers: DEA |
| Greedy drug traffickers are making a "conscious choice" to mix xylazine, an animal tranquilizer called... |
| |
|
|
|
 | First Alert weather: CBS2 11 p.m. forecast |
| CBS2's Lonnie Quinn is calling for a mild day on Wednesday, with sun and clouds and a high approaching... |
 CBS New York CBS New York | 11h | |
|
|
|
 | Remembering New York sports icon Willis Reed |
| Known by many as "The Captain," Reed led the Knicks to two NBA championship during the 1970s. He died... |
 CBS New York CBS New York | 11h | |
|
|
|
 | Child welfare agencies paid "courtesy visit" to families of children killed... |
| Two sisters and two brothers were killed in the wreck had recently moved from New York City to Derby,... |
 CBS New York CBS New York | 11h | |
|
|
|
 | Federal and local law enforcement say they're ready for possible protests if Trump... |
| Rallies were held around the Tri-State Area on Tuesday, but they weren't nearly as big as expected. CBS2's... |
 CBS New York CBS New York | 11h | |
|
|
|
 | All eyes on NYC as country waits to see if former President Trump will be indicted |
| Trump took to social media on Tuesday night to blast the Manhattan district attorney. CBS2's Dick Brennan... |
 CBS New York CBS New York | 11h | |
|
|
|
 | Labor and Coalition reach Voice to Parliament Machinery Deal conclusions |
| Labor has struck a deal with the Opposition to back the Voice referendum Machinery Bill but not everyone... |
 SkyNewsAustralia SkyNewsAustralia | 11h | |
|
|
|
 | 'School refusal' closely related to anxiety in young children and pre-teens |
| Triple P International Program Director Carol Markie-Dadds says school children from five to six and... |
 SkyNewsAustralia SkyNewsAustralia | 11h | |
|
|
|
 | 'Gender pay gap is barely moving': Women likely to make '13.3 per cent' less than... |
| Aware Super CEO Deanne Stewart says the "gender pay gap is barely moving" as women are likely to make... |
 SkyNewsAustralia SkyNewsAustralia | 11h | |
|
|
|
 | Biden's brain 'melts' in new teleprompter gaffe |
| Joe Biden has been roasted online for stumbling over his words while attempting to read off a teleprompter... |
 SkyNewsAustralia SkyNewsAustralia | 11h | |
|
|
|
 | 'I take him at his word': Chris Minns on Perrottet's preferential treatment denial |
| NSW Opposition leader Chris Minns says "I take him at his word" after New South Wales Premier Dominic... |
 SkyNewsAustralia SkyNewsAustralia | 11h | |
|
|
|
 | Menindee dead fish clean up set to begin on Wednesday |
| The clean-up effort to remove the dead fish from the Darling-Baaka River at Menindee is expected to commence... |
 SkyNewsAustralia SkyNewsAustralia | 11h | |
|
|
|
 | Tennis champion Martina Navratilova reveals she is cancer-free |
| American tennis champion Martina Navratilova has revealed she is cancer-free after being diagnosed with... |
 SkyNewsAustralia SkyNewsAustralia | 11h | |
|
|
|
 | Vladimir Putin and Xi Jinping sign joint declaration partnership |
| Russian President Vladimir Putin and Xi Jinping held formal talks about a possible peace deal on the... |
 SkyNewsAustralia SkyNewsAustralia | 11h | |
|
|
|
 | 'Big rump' within Coalition after Voice deal reached |
| Senior political reporter Trudy McIntosh says there is a "big rump" within the Coalition after an agreement... |
 SkyNewsAustralia SkyNewsAustralia | 11h | |
|
|
|
 | Teacher strike in Los Angeles results in mass school shut down |
| Schools across Los Angeles have shut down as teacher unions are demanding better pay and health benefits.... |
 SkyNewsAustralia SkyNewsAustralia | 11h | |
|
|
|
 | Media is using Trump to drown out the Hunter Biden scandal |
| #shorts The Hill journalist Kristin Tate says the media is using Donald Trump to 'drown out' the Hunter... |
 SkyNewsAustralia SkyNewsAustralia | 11h | |
|
|
|
 | Trump indictment is a 'complete and utter abuse of power' from the DA |
| #shorts Commentator Nigel Farage says Trump's payout to Stormy Daniels was a 'rounding error' in comparison... |
 SkyNewsAustralia SkyNewsAustralia | 11h | |
|
|
|
 | 'Beastly': Harry and Meghan are not entitled to 'be on that balcony' at coronation |
| #shorts Sky News contributor Nigel Farage says Prince Harry and Meghan Markle are 'not entitled' to be... |
 SkyNewsAustralia SkyNewsAustralia | 11h | |
|
|
|
 | Trump's 'political prosecution is eerily similar' to China and Russia |
| #shorts Sky News host Andrew Bolt spoke to filmmaker Ami Horowitz and said the indictment of Trump is... |
 SkyNewsAustralia SkyNewsAustralia | 11h | |
|
|
|
 | The King has been 'too soft' on 'incredibly entitled' Harry and Meghan |
| #shorts The Spectator's Kara Kennedy says 'Meghan and Harry have failed to recognise that being non-working... |
 SkyNewsAustralia SkyNewsAustralia | 11h | |
|
|
|
 | Mikaela Shiffrin : 'it's a lot of dedication. It's pretty much a 24/7 job.' |
| ABC News' Linsey Davis spoke with Mikaela Shiffrin, Olympic champion and most successful alpine skier... |
| |
|
|
|
 | Renowned chef Kristen Kish new series: 'Food can bring people together' |
| ABC News' Linsey Davis sat with world renowned chef Kristen Kish about her culinary adventures on National... |
| |
|
|
|
 | New video shows final moments of Irvo Otieno's life at Virginia state psychiatric... |
| New video released by prosecutors Tuesday shows final moments of Irvo Otieno's life in custody at Virginia... |
| |
|
|
|
 | Family to petition court to exhume Stephen Smith's body | Banfield |
| South Carolina authorities reinvestigating the death of a teenager found dead in the middle of a road... |
 NewsNation Now NewsNation Now | 11h | |
|
|
|
 | Could Bryan Kohberger face firing squad if convicted? | Dan Abrams Live |
| Execution by firing squad may soon be legal in Idaho, which means Bryan Kohberger, if convicted of murdering... |
 NewsNation Now NewsNation Now | 11h | |
|
|
|
 | Gwyneth Paltrow on trial, accused of 'out of control' ski crash | Dan Abrams Live |
| Actress Gwyneth Paltrow is being sued for a skiing accident that happened years ago. Dan Abrams says... |
 NewsNation Now NewsNation Now | 11h | |
|
|
|
 | Is avoiding Trump fight still the right strategy for DeSantis? | Dan Abrams Live |
| Florida Gov. Ron DeSantis is slipping in the polls, and Dan Abrams says this began happening when former... |
 NewsNation Now NewsNation Now | 11h | |
|
|
|
 | Abrams: Indictment would be 'political gift' to Donald Trump | Dan Abrams Live |
| The possible indictment of former President Donald Trump has some Republican leaders rallying around... |
 NewsNation Now NewsNation Now | 11h | |
|
|
|
 | New details on Stephen Smith's death one day after Buster Murdaugh statement | LiveNOW... |
| An attorney for Sandy Smith, the mother of Stephen Smith whose death was originally ruled a hit-and-run,... |
 FOX 10 Phoenix FOX 10 Phoenix | 11h | |
|
|
|
 | LAUSD schools close as thousands of employees begin 3-day strike | LiveNOW from FOX |
| Thousands of service employees and teachers braved the rain and began picketing Tuesday at the Van Nuys... |
 FOX 10 Phoenix FOX 10 Phoenix | 11h | |
|
|
|
 | Newsmax Reporter Probes John Kirby About Biden's Performance As Commander-In-Chief |
| On Tuesday, Newsmax Reporter James Rosen asked John Kirby about Biden's role as commander-in-chief. ... |
 Forbes Under 30 Forbes Under 30 | 11h | |
|
|
|
 | LIVE: Tokyo's cherry blossoms in full bloom |
| Cherry blossoms mark the start of spring in the Japanese capital. #cherryblossom #sakura #Tokyo... |
| |
|
|
|
 | UnivisionNoticias's YouTube Videos: 🔴 En vivo ViX: Noticias Univision 24/7 Nocturna,... |
| ... |
 Puerto Rico News Videos from Michael_Novakhov (20 sites) Puerto Rico News Videos from Michael_Novakhov (20 sites) | 11h | |
|
|
|
 | UnivisionNoticias's YouTube Videos: Avanza investigación contra el hijo mayor del... |
| ... |
 Puerto Rico News Videos from Michael_Novakhov (20 sites) Puerto Rico News Videos from Michael_Novakhov (20 sites) | 11h | |
|
|
|
 | Vehicle riddled with bullets after road rage incident in Park Ridge, police say |
| Gunfire followed an alleged road rage incident in Park Ridge, prompting an investigation by police, the... |
| |
|
|
|
 | Disconnecting the brain helps kids with epilepsy |
| Disconnecting half the brain to stop seizures sounds unthinkable but it's an actual procedure to help... |
| |
|
|
|
 | Американские волонтеры продают «русский корабль» |
| Hearts for Ukraine – один из волонтерских фондов США – с марта прошлого года собрал и доставил в Украину... |
 Голос Америки Голос Америки | 11h | |
|
|
|
 | Análisis de la demanda en contra de Bad Bunny por parte de su exnovia | LDSD | WapaTV |
| El licenciado Carlos Dalmau explicó los detalles de la demanda que interpuso la exnovia del artista puertorriqueño... |
| |
|
|
|
 | Fire and Rescue manages to save 60 vehicles during a car park fire incident in Bankstown |
| Fire and Rescue NSW manages to rescue around 60 vehicles during a car park fire incident in Bankstown... |
 news.com.au news.com.au | 11h | |
|
|
|
 | Gwyneth Paltrow slammed as 'reckless' as she is sued for skiing accident |
| American actress Gwyneth Paltrow has been accused of "conscious disregard for people" as she is sued... |
 news.com.au news.com.au | 11h | |
|
|
|
 | Many Iraqis were happy that Saddam Hussein's dictatorship was ending #gzeroworld... |
| |
 GZERO Media GZERO Media | 11h | |
|
|
|
 | New report finds London Police Department racist, sexist, and homophobic |
| Members of the British Parliament released their scathing review of the London Metropolitan Police, calling... |
| |
|
|
|
 | América al día en 60 segundos, martes 21de marzo |
| Redacción Internacional, 17 mar (EFE).- La empresa matriz del intervenido Silicon Valley Bank se declara... |
 AGENCIA EFE AGENCIA EFE | 11h | |
|
|
|
 | Máxima expectación por regreso de la Albiceleste a las canchas en Argentina |
| Ezeiza (Argentina), 21 mar (EFE).- La selección de fútbol de Argentina culminó este martes su segunda... |
 AGENCIA EFE AGENCIA EFE | 11h | |
|
|
|
 | msnbcleanforward's YouTube Videos: Joy Reid: Trump has rarely been held accountable,... |
| ... |
 Trump News TV from Michael_Novakhov (10 sites) Trump News TV from Michael_Novakhov (10 sites) | 11h | |
|
|
|
 | FoxNewsChannel's YouTube Videos: Hannity exposes Alvin Bragg's soft-on-crime record |
| ... |
 Trump News TV from Michael_Novakhov (10 sites) Trump News TV from Michael_Novakhov (10 sites) | 11h | |
|
|
|
 | MidweekPolitics's YouTube Videos: Biden quietly gets a bunch done while Trump arrest... |
| ... |
 Trump News TV from Michael_Novakhov (10 sites) Trump News TV from Michael_Novakhov (10 sites) | 11h | |
|
|
|
 | Community leaders attend NYPD meeting on crime stats |
| CompStat is the department's computer system for collecting, tracking and analyzing crime data. Doing... |
| |
|
|
|
 | Activist raises concerns about Humane Society of NY |
| An animal rights activist wants answers from the Humane Society of New York, which he claims is warehousing... |
| |
|
|
|
 | Chinese EV Maker Nio 'Very Confident' of Reaching Sales Target: CFO |
| Nio Inc. Chief Financial Officer Steven Feng discusses the Chinese electric-vehicle maker's strategy... |
 Bloomberg TV Markets and Finance Bloomberg TV Markets and Finance | 11h | |
|
|
|
 | Putin hosts Xi in Russia |
| The Russian and Chinese leaders met in the Kremlin's grandest hall, and issued a statement against Ukraine.... |
| |
|
|
|
 | Warren Mundine calls for government 'fairness' on Yes/No Voice campaigns |
| Aboriginal Leader Warren Mundine says The Voice to Parliament's No Campaign wants fairness. "We... |
 SkyNewsAustralia SkyNewsAustralia | 11h | |
|
|
|
 | 'Everything's for sale': 'Terrified' royals 'won't tell Harry and Meghan anything' |
| News Corp columnist Louise Roberts says everyone close to Prince Harry and Meghan Markle are "terrified"... |
 SkyNewsAustralia SkyNewsAustralia | 11h | |
|
|
|
 | Potential Trump indictment: When could the former US president be arrested? |
| Days after he announced his arrest was imminent, Manhattan prosecutors have yet to indict former U.S.... |
 Global News Global News | 11h | |
|
|
|
 | Scathing report on London's Metropolitan Police finds force institutionally racist... |
| A year-long review into London's Metropolitan Police has exposed institutional racism, misogyny, and... |
 Global News Global News | 11h | |
|
|
|
 | Time to Invest in Whisky? |
| "Whisky is sexy. Good investments generally aren't." High-end casks of scotch can change hands for over... |
 TicToc by Bloomberg TicToc by Bloomberg | 11h | |
|
|
|
 | 🔴 En vivo ViX: Noticias Univision 24/7 Nocturna, 21 de marzo del 2023 |
| En @vix ésta y más noticias 24 horas Noticias 24/7 en ViX: https://bit.ly/3LBhvTK #ViX en redes... |
 Univision Noticias Univision Noticias | 11h | |
|
|
|
 | Avanza investigación contra el hijo mayor del presidente de Colombia por presunto... |
| Las autoridades de Colombia avanzan en la investigación contra Nicolás Petro Burgos, hijo mayor del presidente... |
 Univision Noticias Univision Noticias | 11h | |
|
|
|
 | Over 30 local Herbalife victims to finally receive checks over 2016 ruling |
| Over 30 people who were supposed to receive money from a 2016 settlement involving Herbalife are finally... |
| |
|
|
|
 | Kevin Fox, wrongly charged in daughter's 2004 death, dies in Arkansas crash |
| Dana Rebik reports from Wilmington where Kevin Fox was from. More on the story: https://wgntv.com/news/illinois/kevin-fox-wrongly-charged-in-daug... |
| |
|
|
|
 | New lawsuits filed against former Chicago cop bring old allegations to light |
| David Lugo recounted spending more than two decades in prison, being denied a proper goodbye to family... |
| |
|
|
|
 | 'That is so cruel': Sam Neill mortified during interview on Today |
| Actor Sam Neill was left red-faced during a live interview on Today this morning when he was surprised... |
 news.com.au news.com.au | 12h | |
|
|
|
 | Hungry crocodile invades picnic, steals esky |
| Footage captured the alarming moment a thieving crocodile crashed a South African safari group's alfresco... |
 news.com.au news.com.au | 12h | |
|
|
|
 | Wapa TV's YouTube Videos: ¿Causa para arresto contra Donald Trump? | LDSD | WapaTV |
| ... |
 Puerto Rico News Videos from Michael_Novakhov (20 sites) Puerto Rico News Videos from Michael_Novakhov (20 sites) | 12h | |
|
|
|
 | UnivisionNoticias's YouTube Videos: 🔴 En vivo ViX: Línea de Fuego, 21 de marzo del... |
| ... |
 Puerto Rico News Videos from Michael_Novakhov (20 sites) Puerto Rico News Videos from Michael_Novakhov (20 sites) | 12h | |
|
|
|
 | UnivisionNoticias's YouTube Videos: Once hombres condenados injustamente por crímenes... |
| ... |
 Puerto Rico News Videos from Michael_Novakhov (20 sites) Puerto Rico News Videos from Michael_Novakhov (20 sites) | 12h | |
|
|
|
 | UnivisionNoticias's YouTube Videos: Biden entrega medallas nacionales de artes y... |
| ... |
 Puerto Rico News Videos from Michael_Novakhov (20 sites) Puerto Rico News Videos from Michael_Novakhov (20 sites) | 12h | |
|
|
|
 | UnivisionNoticias's YouTube Videos: Dron ucraniano capta el momento de supuesto ataque... |
| ... |
 Puerto Rico News Videos from Michael_Novakhov (20 sites) Puerto Rico News Videos from Michael_Novakhov (20 sites) | 12h | |
|
|
|
 | Wapa TV's YouTube Videos: ¿Qué ocurrió en el quinto día del juicio contra Ángel Pérez?... |
| ... |
 Puerto Rico News Videos from Michael_Novakhov (20 sites) Puerto Rico News Videos from Michael_Novakhov (20 sites) | 12h | |
|
|
|
 | Why Donald Trump faces arrest and what happens next? | Latest English News |
| New York police have tightened security ahead of a possible historic indictment of Donald Trump over... |
| |
|
|
|
 | Earthquake in Afghanistan: 9 killed and over hundred injured after 6.6 magnitude... |
| A strong earthquake struck northeast Afghanistan on Tuesday, with tremors felt in cities in Pakistan... |
| |
|
|
|
 | Hush money case: Donald Trump likely to be arrested today | Latest English News |
| New York police have tightened security ahead of a possible historic indictment of Donald Trump over... |
| |
|
|
|
 | ¿Causa para arresto contra Donald Trump? | LDSD | WapaTV |
| El licenciado Carlos Dalmau analizó junto a Jay Fonseca el caso por el cual el expresidente de los Estados... |
| |
|
|
|
 | Biden quietly gets a bunch done while Trump arrest looms |
| -- President Joe Biden quietly accomplishes many things as Donald Trump's arrest looms https://www.cnn.com/2023/03/14/politics/white-house-cpi-in... |
 David Pakman Show David Pakman Show | 12h | |
|
|
|
 | Fentanyl testing not required in most emergency room drug screenings |
| Regulated drug tests in emergency rooms are only required to check for the "federal five:" marijuana,... |
| |
|
|
|
 | Teacher shot by six-year-old student relives what happened |
| Abigail Zwerner told NBC News' Savannah Guthrie about what happened after a six-year-old student shot... |
| |
|
|
|
 | ABC News's YouTube Videos: Trump may have broken law in handling classified docs:... |
| ... |
 Trump News TV from Michael_Novakhov (10 sites) Trump News TV from Michael_Novakhov (10 sites) | 12h | |
|
|
|
 | Joy Reid: Trump has rarely been held accountable, instead being consistently protected,... |
| Of Republicans denouncing the possibility of Donald Trump being indicted by the Manhattan district attorney's... |
| |
|
|
|
 | Trump lawyer: If he's indicted 'this is an all-out war' |
| A lawyer for former President Donald Trump said on Monday that it will be "an all-out war" if Trump is... |
| |
|
|
|
 | Hannity exposes Alvin Bragg's soft-on-crime record |
| Fox News host Sean Hannity discusses the criminal investigation for alleged hush money payments former... |
| |
|
|
|
 | Xi and Putin Toast Russia-China Partnership During Xi's Russia Visit | VOA News |
| Russia and China toasted to their "no limit friendship" on Tuesday during a Kremlin meeting filled with... |
| |
|
|
|
 | Putin-Xi Meeting Won't End Ukraine War, Says White House |
| US will support Chinese-brokered talks only if Ukraine believes it would lead to 'just peace' Originally... |
| |
|
|
|
 | Biden busca desclasificar información de origen del COVID-19 #Shorts | Noticias Telemundo |
| Short oficial de Noticias Telemundo. El presidente firmó un proyecto de ley bipartidista que ordena al... |
 NOTICIAS TELEMUNDO NOTICIAS TELEMUNDO | 12h | |
|
|
|
 | Suspects identified in assault of BC international student; hate crimes team joins... |
| Mounties have identified suspects involved in the Friday night assault of a Kelowna, B.C., international... |
 Global News Global News | 12h | |
|
|
|
 | 8 people critically injured in 2-vehicle crash on North Side, paramedics say |
| Eight people have been transported to various area hospitals in critical condition after a two-vehicle... |
| |
|
|
|
 | Biden Awards National Humanities Medals To Mindy Kaling, Bruce Springsteen, And More |
| President Biden awards National Humanities Medals and National Medal of Arts honors at the White House.... |
 Forbes Under 30 Forbes Under 30 | 12h | |
|
|
|
 | Enfamil Infant Formula Price Spikes: Frustrated Consumers Cry 'Robbery' As Shortages... |
| Months after baby formula shortages rattled parents, consumers are still taking a hit, reporting rapid... |
 Forbes Under 30 Forbes Under 30 | 12h | |
|
|
|
 | Burgess Owens: We Cannot Have A Free Society If We Do This |
| At today's House Republican leadership press briefing, Rep. Burgess Owens (R-UT) promoted the Parents'... |
 Forbes Under 30 Forbes Under 30 | 12h | |
|
|
|
 | Possible Trump arrest: Who is Manhattan District Attorney Alvin Bragg? | LiveNOW... |
| Former President Trump has not been formally notified of whether Manhattan District Attorney Alvin Bragg... |
 FOX 10 Phoenix FOX 10 Phoenix | 12h | |
|
|
|
 | Kids' Soccer Game Gets Hilarious Twist When Playful Emus Join In |
| A father in Montgomery, Texas, captured a hilarious moment on his family farm when his son and his friend... |
 news.com.au news.com.au | 12h | |
|
|
|
 | ¿Qué ocurrió en el quinto día del juicio contra Ángel Pérez? | LDSD | WapaTV |
| Cynthia López Cabán compartió los detalles de lo último que aconteció en el caso contra el exalcalde... |
| |
|
|
|
 | Wapa TV's YouTube Videos: Secretos para mantener hermoso y radiante tu cabello rubio... |
| ... |
 Puerto Rico News Videos from Michael_Novakhov (20 sites) Puerto Rico News Videos from Michael_Novakhov (20 sites) | 12h | |
|
|
|
 | Top Story with Tom Llamas - March 21 | NBC News NOW |
| New York City is bracing for Donald Trump's possible indictment, a Georgia couple fights for the release... |
| |
|
|
|
 | CBSNewsOnline's YouTube Videos: 10 charged with murder in Irvo Otieno's death |
| ... |
 Trump News TV from Michael_Novakhov (10 sites) Trump News TV from Michael_Novakhov (10 sites) | 12h | |
|
|
|
 | CBSNewsOnline's YouTube Videos: Fed to make interest rate decision amid banking turmoil |
| ... |
 Trump News TV from Michael_Novakhov (10 sites) Trump News TV from Michael_Novakhov (10 sites) | 12h | |
|
|
|
 | CBSNewsOnline's YouTube Videos: 3/21: CBS News Prime Time |
| ... |
 Trump News TV from Michael_Novakhov (10 sites) Trump News TV from Michael_Novakhov (10 sites) | 12h | |
|
|
|
 | Once hombres condenados injustamente por crímenes que no cometieron demandan a la... |
| Un grupo de 11 personas entabló una demanda contra la ciudad de Chicago, su departamento de policía y... |
 Univision Noticias Univision Noticias | 12h | |
|
|
|
 | Biden entrega medallas nacionales de artes y humanidades: cuatro hispanos entre los... |
| Este martes el presidente Joe Biden entregó en la Casa Blanca más de dos decenas de medallas nacionales... |
 Univision Noticias Univision Noticias | 12h | |
|
|
|
 | Dron ucraniano capta el momento de supuesto ataque ruso contra pareja de civiles |
| CNN tuvo acceso en exclusiva a un video del momento en que presuntos soldados rusos atacan el automóvil... |
 Univision Noticias Univision Noticias | 12h | |
|
|
|
 | 🔴 En vivo ViX: Línea de Fuego, 21 de marzo del 2023 |
| En @vix ésta y más noticias 24 horas Noticias 24/7 en ViX: https://bit.ly/3LBhvTK #ViX en redes... |
 Univision Noticias Univision Noticias | 12h | |
|
|
|
 | Tri-state forecast: mild day before chance of rain |
| Wednesday will be another pleasant day in the tri-state area, but clouds will be on the increase ahead... |
| |
|
|
|
 | Residents want federal oversight of Paterson police |
| Frustrations boiled over during a Tuesday night City Council meeting in Paterson, N.J., on Tuesday. |
| |
|
|
|
 | Man shoved into side of moving Brooklyn train: NYPD |
| A man pushed a straphanger into the side of a moving train in a Brooklyn subway station on Sunday, police... |
| |
|
|
|
 | 10 charged with murder in Irvo Otieno's death |
| Seven Virginia deputies and two hospital workers are facing murder charges in the death of 28-year-old... |
| |
|
|
|
 | Fed to make interest rate decision amid banking turmoil |
| The central bank is meeting this week to decide whether to continue raising interest rates as the banking... |
| |
|
|
|
 | Check your receipts: How Canadians can take a bite out of rising food prices |
| While inflation in Canada dropped in February to 5.2 per cent, its lowest point since April 2020, food... |
 Global News Global News | 12h | |
|
|
|
 | Trump may have broken law in handling classified docs: Sources |
| A federal judge ruled the special counsel has presented evidence that Donald Trump may have broken the... |
| |


